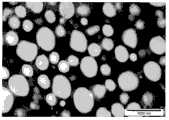
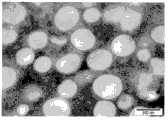

CN103384677A - Compositions for separation methods - Google Patents
Compositions for separation methodsDownload PDFInfo
- Publication number
- CN103384677A CN103384677ACN2011800672323ACN201180067232ACN103384677ACN 103384677 ACN103384677 ACN 103384677ACN 2011800672323 ACN2011800672323 ACN 2011800672323ACN 201180067232 ACN201180067232 ACN 201180067232ACN 103384677 ACN103384677 ACN 103384677A
- Authority
- CN
- China
- Prior art keywords
- polymer particles
- polypeptide
- particulate
- polymer
- polymkeric substance
- Prior art date
- Legal status (The legal status is an assumption and is not a legal conclusion. Google has not performed a legal analysis and makes no representation as to the accuracy of the status listed.)
- Pending
Links
Images
Classifications
- C—CHEMISTRY; METALLURGY
- C07—ORGANIC CHEMISTRY
- C07K—PEPTIDES
- C07K1/00—General methods for the preparation of peptides, i.e. processes for the organic chemical preparation of peptides or proteins of any length
- C07K1/14—Extraction; Separation; Purification
- C07K1/34—Extraction; Separation; Purification by filtration, ultrafiltration or reverse osmosis
- B—PERFORMING OPERATIONS; TRANSPORTING
- B01—PHYSICAL OR CHEMICAL PROCESSES OR APPARATUS IN GENERAL
- B01D—SEPARATION
- B01D69/00—Semi-permeable membranes for separation processes or apparatus characterised by their form, structure or properties; Manufacturing processes specially adapted therefor
- B01D69/14—Dynamic membranes
- B01D69/141—Heterogeneous membranes, e.g. containing dispersed material; Mixed matrix membranes
- B01D69/142—Heterogeneous membranes, e.g. containing dispersed material; Mixed matrix membranes with "carriers"
- B01D69/144—Heterogeneous membranes, e.g. containing dispersed material; Mixed matrix membranes with "carriers" containing embedded or bound biomolecules
- C—CHEMISTRY; METALLURGY
- C07—ORGANIC CHEMISTRY
- C07K—PEPTIDES
- C07K17/00—Carrier-bound or immobilised peptides; Preparation thereof
- C07K17/02—Peptides being immobilised on, or in, an organic carrier
- C—CHEMISTRY; METALLURGY
- C07—ORGANIC CHEMISTRY
- C07K—PEPTIDES
- C07K19/00—Hybrid peptides, i.e. peptides covalently bound to nucleic acids, or non-covalently bound protein-protein complexes
- G—PHYSICS
- G01—MEASURING; TESTING
- G01N—INVESTIGATING OR ANALYSING MATERIALS BY DETERMINING THEIR CHEMICAL OR PHYSICAL PROPERTIES
- G01N33/00—Investigating or analysing materials by specific methods not covered by groups G01N1/00 - G01N31/00
- G01N33/48—Biological material, e.g. blood, urine; Haemocytometers
- G01N33/50—Chemical analysis of biological material, e.g. blood, urine; Testing involving biospecific ligand binding methods; Immunological testing
- G01N33/53—Immunoassay; Biospecific binding assay; Materials therefor
- G01N33/543—Immunoassay; Biospecific binding assay; Materials therefor with an insoluble carrier for immobilising immunochemicals
- G01N33/54313—Immunoassay; Biospecific binding assay; Materials therefor with an insoluble carrier for immobilising immunochemicals the carrier being characterised by its particulate form
- G—PHYSICS
- G01—MEASURING; TESTING
- G01N—INVESTIGATING OR ANALYSING MATERIALS BY DETERMINING THEIR CHEMICAL OR PHYSICAL PROPERTIES
- G01N33/00—Investigating or analysing materials by specific methods not covered by groups G01N1/00 - G01N31/00
- G01N33/48—Biological material, e.g. blood, urine; Haemocytometers
- G01N33/50—Chemical analysis of biological material, e.g. blood, urine; Testing involving biospecific ligand binding methods; Immunological testing
- G01N33/53—Immunoassay; Biospecific binding assay; Materials therefor
- G01N33/543—Immunoassay; Biospecific binding assay; Materials therefor with an insoluble carrier for immobilising immunochemicals
- G01N33/544—Immunoassay; Biospecific binding assay; Materials therefor with an insoluble carrier for immobilising immunochemicals the carrier being organic
- B—PERFORMING OPERATIONS; TRANSPORTING
- B01—PHYSICAL OR CHEMICAL PROCESSES OR APPARATUS IN GENERAL
- B01D—SEPARATION
- B01D2315/00—Details relating to the membrane module operation
- B01D2315/10—Cross-flow filtration
- C—CHEMISTRY; METALLURGY
- C07—ORGANIC CHEMISTRY
- C07K—PEPTIDES
- C07K2319/00—Fusion polypeptide
Landscapes
- Chemical & Material Sciences (AREA)
- Health & Medical Sciences (AREA)
- Life Sciences & Earth Sciences (AREA)
- Molecular Biology (AREA)
- Organic Chemistry (AREA)
- Biochemistry (AREA)
- Engineering & Computer Science (AREA)
- Immunology (AREA)
- Medicinal Chemistry (AREA)
- General Health & Medical Sciences (AREA)
- Genetics & Genomics (AREA)
- Proteomics, Peptides & Aminoacids (AREA)
- Biophysics (AREA)
- Analytical Chemistry (AREA)
- Urology & Nephrology (AREA)
- Hematology (AREA)
- Biomedical Technology (AREA)
- Water Supply & Treatment (AREA)
- General Physics & Mathematics (AREA)
- Pathology (AREA)
- Physics & Mathematics (AREA)
- Food Science & Technology (AREA)
- Microbiology (AREA)
- Cell Biology (AREA)
- Biotechnology (AREA)
- Dispersion Chemistry (AREA)
- Chemical Kinetics & Catalysis (AREA)
- Separation Using Semi-Permeable Membranes (AREA)
- Peptides Or Proteins (AREA)
- Enzymes And Modification Thereof (AREA)
- Solid-Sorbent Or Filter-Aiding Compositions (AREA)
- Micro-Organisms Or Cultivation Processes Thereof (AREA)
- Apparatus Associated With Microorganisms And Enzymes (AREA)
- Measuring Or Testing Involving Enzymes Or Micro-Organisms (AREA)
Abstract
Translated fromChineseDescription
Technical field
Relate generally to of the present invention separates and the transformation technology field, relates more specifically to the material for the tangential flow filtration technology.The tangential flow material is widely used in and separates and conversion process, comprises those that depend on reverse osmosis, micro-filtration, ultrafiltration or the semi-permeable filtering membrane of nanofiltration, and the method that effectively is used for purifying or prepares the plurality of target material is provided.
Background of invention
From unwanted material, for example from complicated composition, separating the target substance of wanting is many important daily necessities, comprises for example basic step in the preparation of cell, virus, polypeptide, polynucleotide and metabolite of food, chemical, pharmaceuticals and biotechnological formulation.Similarly, one or more precursor substances are changed into target substance, for example by enzymatic conversion, enrichment or the separation coupling of optional and target substance,, for example from precursor substance, be the basic step of many manufacture method.
Therefore, method and the technology of required target substance can effectively be separated and prepare to existing very large expenditure with development.For example, be used for from the second composition, for example another kind of liquid or one or more dissolvings or solid that suspend separates one or more desired substances, and the typically reverse osmosis of one or more liquid (RO), micro-filtration (MF), ultrafiltration (UF) and nanofiltration (NF) technology have developed many years.
The most often use the packed bed chromatogram, wherein be filled in resin particle in bed and make the solution that contains target molecule be bonded to resin by post and target compound.A concrete challenge of the method is to form irregular fluid passage.These irregular fluid passages have hindered effective purifying of target compound and have hindered effective cleaning of resin, thereby have caused potentially contaminated.
In the preparation of monoclonal antibody, for example, proposed can process irregular stream problem with ten times of excess resin packed beds.Far and away, adopt this suggestion to have cost and efficiency consequence.In having the right to use the system of whole usable mediums, may reduce required amount of resin, therefore reduce preparation cost.
A kind of terms of settlement that reduces abnormal flow transportation work style danger is to reduce the working pressure of post.Reduce although this has the required effect that forms the runner risk, negative results is to increase in the treatment time.
Tangential flow (also referred to as crossing current) filtration procedure (wherein expect that stream crosses the surface on semipermeable partition surface and concentrate feed stream typically in the downstream recovery of charging stream) has some the potentiality in processing these problems.Develop multiple semipermeable partition and be used for these and other filtration procedure.
Existing tangential flow technology, realize specific the separation although meet, and not too is applicable to from complicated feed preparation or separates some target substance, for example polypeptide.Have the source liquid of high levels of particulate or utilize the filtering technique of particulate usually not to be suitable for tangential flow filtration, typically because they can form gel coat or block in addition or stick filter film, thereby lower efficiency.The trial that addresses this problem has concentrated on uses large rigid particle (being in the 100-300 micron order).Although large size and rigidity have reduced fouling risk or degree, the surface area/volume ratio that reduces presents target compound binding site still less, and this need to use more resin.
One object of the present invention particularly overcomes by tangential flow filtration or improves at least the above-mentioned shortcoming of part,, to provide improved for the preparation of the composition with the purification of target material and method, perhaps is at least the public available selection is provided.
Other purpose of the present invention becomes apparent by the following explanation that only provides as an example.
Summary of the invention
The present invention relates to a kind of for prepare the method for one or more target substances from source material, the method comprises makes source material and amorphous polymer Particle Swarm contact for some time to be enough to make the amorphous polymer particulate to be combined one or more target substances or one or more target substance precursors or one or more pollutents, separate one or more pollutents by tangential flow filtration from the target substance of particulate combination or its precursor, or from one or more target substances of separated from contaminants or its precursor of particulate combination, and reclaim target substance.
In one embodiment, the amorphous polymer Particle Swarm is the homogeneous group.In another embodiment, the amorphous polymer Particle Swarm is heterogeneous group.
In one embodiment, one or more amorphous polymer particulates comprise one or more and are selected from the biological polymer of polyester, polyester, polythioester or PHA.
In one embodiment, can to form albumen by particulate synthetic for one or more amorphous polymer particulates.In one embodiment, whole polymer particles group energy is enough basically forms albumen by particulate and synthesizes.
In one embodiment, one or more amorphous polymer particulates comprise polymer particles and form albumen, and for example polymkeric substance synthase or polymkeric substance synthase merge.
In one embodiment, target substance is by reclaiming from the polymer particles wash-out.In one embodiment, target substance is by collecting the tangential flow filtration recovery of permeate.In one embodiment, complex reclaims by collecting the tangential flow filtration retentate.
Correspondingly, in one aspect, the invention provides a kind of for the method from one or more target substances of source material isolated or purified, the method comprises makes source material and polymer particles group contact for some time to be enough to make one or more polymer particles to be combined one or more target substances, separate one or more pollutents by tangential flow filtration from the target substance of particulate combination, with the recovery target substance, wherein one or more polymer particles comprise:
■ is selected from the biological polymer of polyester, polythioester or PHA; Or
■ forms the polypeptide of polymer particles, and for example polymkeric substance synthase or polymkeric substance synthase merge; Or
■ haves both at the same time.
Correspondingly, in another aspect, the invention provides a kind of for the method from one or more target substances of source material isolated or purified, the method comprises makes source material and polymer particles group contact for some time to be enough to make one or more polymer particles to be combined one or more pollutents, by tangential flow filtration one or more target substances of separated from contaminants from the particulate combination, with the recovery target substance, wherein one or more polymer particles comprise:
■ is selected from the biological polymer of polyester, polyester, polythioester or PHA; Or
■ forms the polypeptide of polymer particles, and for example polymkeric substance synthase or polymkeric substance synthase merge; Or
■ haves both at the same time.
in another aspect, the invention provides a kind of method for the preparation of one or more reaction product, the method comprises by tangential flow filtration makes the source material that comprises one or more reactive material and one or more polymer particles contact for some time to be enough to make one or more polymer particles to be combined the required level part of one or more reactive material, randomly by tangential flow filtration, from polymer particles, separate one or more pollutents, with the recovery reaction product, wherein one or more polymer particles comprise catalysts, and wherein one or more polymer particles comprise:
■ is selected from the biological polymer of polyester, polyester, polythioester or PHA; Or
■ forms the polypeptide of polymer particles, and for example polymkeric substance synthase or polymkeric substance synthase merge; Or
■ haves both at the same time.
the invention further relates to a kind of for the purification process from the source material isolation of target substances, the method comprises that (a) provides source material, (b) with the described source material of at least one semi-permeable strainer tangential flow filtration, wherein source material or semi-permeable strainer comprise one or more polymer particles, (c) reclaim target substance, one or more source materials wherein, semi-permeable strainer, or in described tangential flow filtration, one or more solution used comprise one or more polymer particles, wherein one or more polymer particles comprise part that can the combining target material, and wherein one or more polymer particles comprise:
I. be selected from the biological polymer of polyester, polythioester or PHA; Or
Ii. form the polypeptide of polymer particles, for example polymkeric substance synthase or polymkeric substance synthase merge; Or
Iii. the polypeptide of conjugated polymer particulate;
Iv. polypeptide fusion partner;
V. affinity ligand;
Vi. enzyme;
Vii. the fusion polypeptide that comprises above two or more; Or
Viii. above (i) is to (any two or more any combination vii).
Correspondingly, in an exemplary, the invention provides a kind of purification process for one or more antibody of purifying, comprise: the source material that comprises one or more antibody is provided, comprise the described source material of semi-permeable strainer tangential flow filtration of one or more polymer particles with at least one, wherein one or more polymer particles comprise part that can binding antibody, and reclaim antibody.
Correspondingly, in another exemplary, the invention provides a kind of purification process for one or more polymer particles of purifying, comprise: the source material that comprises one or more polymer particles is provided, with the described source material of at least one semi-permeable strainer tangential flow filtration, wherein one or more polymer particles comprise:
■ is selected from the biological polymer of polyester, polythioester or PHA; Or
■ forms the polypeptide of polymer particles, and for example polymkeric substance synthase or polymkeric substance synthase merge; Or
■ haves both at the same time.
The present invention provides on the other hand and comprises following polymer particles
■ is selected from the biological polymer of polyester, polythioester or PHA; Or
■ forms the polypeptide of polymer particles, and for example polymkeric substance synthase or polymkeric substance synthase merge; Or
■ haves both at the same time; With
Wherein one or more fusion polypeptide for or comprise GB1 territory from streptococcic Protein G.
Fusion polypeptide comprises polypeptide and one or more territories of GB1 from streptococcic Protein G that form polymer particles.
In one embodiment, fusion polypeptide for or comprise by comprising the GB1 territory of 12 or a plurality of polynucleotide sequence coding in abutting connection with Nucleotide SEQ ID NO.4.In another embodiment, fusion polypeptide for or comprise by comprising the polypeptide of 12 or a plurality of polynucleotide sequence coding in abutting connection with Nucleotide SEQ ID NO.4.
In one embodiment, described polymer particles has the immunoglobulin (Ig) binding ability greater than 30mg immunoglobulin (Ig)/g wet polymer particulate.
In one embodiment, binding ability is at least about 35mg immunoglobulin (Ig)/g wet polymer particulate, about 40mg immunoglobulin (Ig)/g wet polymer particulate, about 45mg immunoglobulin (Ig)/g wet polymer particulate, about 50mg immunoglobulin (Ig)/g wet polymer particulate, about 55mg immunoglobulin (Ig)/g wet polymer particulate, or about 60mg immunoglobulin (Ig)/g wet polymer particulate.
In one embodiment, immunoglobulin (Ig) is IgG.
Further, the invention provides a kind of method of the semi-permeable strainer for the manufacture of being used for tangential flow filtration, the method comprises provides permeable or semi-permeable carrier, one or more polymer particles are bonded to carrier so that semi-permeable strainer to be provided, and wherein one or more polymer particles comprise:
■ is selected from the biological polymer of polyester, polythioester or PHA; Or
■ forms the polypeptide of polymer particles, and for example polymkeric substance synthase or polymkeric substance synthase merge; Or
■ haves both at the same time.
Further, the invention provides a kind of method for the preparation of polymer particles, wherein one or more polymer particles comprise:
■ is selected from the biological polymer of polyester, polythioester or PHA; Or
■ forms the polypeptide of polymer particles, and for example polymkeric substance synthase or polymkeric substance synthase merge; Or
■ haves both at the same time;
Wherein the method comprises by tangential flow filtration and separates one or more pollutents from polymer particles, and reclaims polymer particles.
In one aspect of the method, the invention provides a kind of for the method from one or more polymer particles of source material isolated or purified, the method comprises by tangential flow filtration separates one or more pollutents from polymer particles, with one or more polymer particles of recovery, wherein one or more particulates comprise
■ is selected from the biological polymer of polyester, polythioester or PHA; Or
■ forms the polypeptide of polymer particles, and for example polymkeric substance synthase or polymkeric substance synthase merge; Or
■ haves both at the same time.
The present invention further provides composition, film, strainer and the filter apparatus (for example filter cylinder) that comprise one or more polymer particles described herein.Said composition, film, strainer and filter apparatus are specially adapted to tangential flow filtration.
Following embodiment can relate to any of above aspect.
In a plurality of embodiments, one or more polymer particles comprise following one or more:
The polypeptide of ■ conjugated polymer particulate;
■ polypeptide fusion partner;
The ■ affinity ligand;
The ■ enzyme;
■ comprises the fusion polypeptide of above two or more; Or
Above two or more any combination arbitrarily of ■.
In a plurality of embodiments, whole polymer particles comprises basically:
The ■ biological polymer, for example be selected from the biological polymer of poly-beta-hydroxy acid, biological poly-lactic acid ester, biological polythioester and biological polyester; Or
■ forms the polypeptide of polymer particles, and for example polymkeric substance synthase or polymkeric substance synthase merge; Or
■ haves both at the same time.
In one embodiment, the polypeptid covalence of formation polymer particles is bonded to the surface of particulate.
In one embodiment, one or more polymer particles comprise one or more its surperficial parts that are placed in.
In one embodiment, polymer particles is bonded to semi-permeable carrier, with semi-permeable carrier, is combined or comprises semi-permeable carrier, such as semipermeable partition, resin, tangential flow filter, tangential flow filter cylinder etc.
In one embodiment, source material for or be derived from cell lysate.In one embodiment, source material is or is derived from protein expression system, comprises the recombinant protein expression system.
In one embodiment, source material is or is derived from food, comprises milk preparation or diary processing stream, comprises the fermented liquid of grape wine or beer fermentation liquid etc.
In one embodiment, source material is solution, comprises reaction soln, chemosynthesis solution, chemosynthesis intermediate etc.
In one embodiment, target substance is polypeptide, for example comprises recombinant polypeptide, antibody, enzyme, hormone etc.
In one embodiment, target substance is polynucleotide, for example comprises, recombination of polynucleotide, carrier, oligonucleotide, RNA molecule be rRNA, mRNA, miRNA, siRNA or tRNA for example, or DNA molecular cDNA for example.
In one embodiment, target substance is products of cellular metabolism, comprises the secretion meta-bolites.
In different embodiments, polymer particles comprises the biological polymer that is selected from polyester, polythioester or PHA (PHA).Most preferably, polymkeric substance comprises PHA, preferably gathers (3-hydroxybutyrate ester) (PHB).
In different embodiments, the polymkeric substance that forms particulate substantially go up by, or by the biological polymer that is selected from polyester, polythioester or PHA (PHA), formed.Most preferably, polymkeric substance comprises PHA, preferably gathers (3-hydroxybutyrate ester) (PHB).
In different embodiments, polymer particles comprises the polymer particles by the encapsulation of phosphatide individual layer.
In different embodiments, the polymkeric substance synthase is bonded to polymer particles or is bonded to the phosphatide individual layer or is bonded to both.
In different embodiments, polymer particles comprises two or more different fusion polypeptide.
In different embodiments, polymer particles comprises the two or more different fusion polypeptide that is on the polymer particles surface.
In different embodiments, polymer particles comprises three or more different fusion polypeptide, for example is in three or more different fusion polypeptide on polymer particles surface.
In different embodiments, polymer particles also comprises at least one and is bonded to or integrates with the material of polymer particles or its combination.
In different embodiments, described material is by the crosslinked polymer particles that is bonded to.
In different embodiments, the polymkeric substance synthase is bonded to polymer particles or is bonded to the phosphatide individual layer or is bonded to both.
In different embodiments, the polymkeric substance synthase covalently or non-covalently is bonded to its formed polymer particles.
in different embodiments, the polymkeric substance synthase is for being selected from acinetobacter (Acinetobacter), Vibrio (Vibrio), Aeromonas (Aeromonas), chromobacterium (Chromobacterium), Rhodopseudomonas (Pseudomonas), Zoogloea (Zoogloea), Alcaligenes (Alcaligenes), Dai Erfute Pseudomonas (Delftia), Burkholderia (Burkholderia), Lei Er Bordetella (Ralstonia), Rhod (Rhodococcus), Gordona (Gordonia), red bacterium belongs to (Rhodobacter), paracoccus (Paracoccus), rickettsiae (Rickettsia), Caulobacter (Caulobacter), methyl Bacillaceae (Methylobacterium), nitrogen-fixing root nodule Pseudomonas (Azorhizobium), Agrobacterium (Agrobacterium), rhizobium (Rhizobium), Sinorhizobium belongs to (Sinorhizobium), rickettsiae (Rickettsia), the ancient bacterium door (Crenarchaeota) of spring, synechocystis (Synechocystis), Ectothiorhodospira (Ectothiorhodospira), Thiocapsa (Thiocapsa), 1 type PHA synthase of Thiocystis (Thyocystis) and different Chromatium (Allochromatium), 2 type PHA synthase from Burkholderia (Burkholderia) and Rhodopseudomonas (Pseudomonas), or from the 4 type PHA synthase of bacillus (Bacillus), more preferably from acinetobacter calcoaceticus (Acinetobacter sp.) RA3849, vibrio cholerae (Vibrio cholerae), Vibrio parahemolyticus (Vibrio parahaemolyticus), aeromonas punctata (Aeromonas punctata) FA440, Aeromonas hydrophila (Aeromonas hydrophila), chromobacterium violaceum (Chromobacterium violaceum), pseudomonas (Pseudomonas sp.) 61-3, give birth to branch moving glue bacterium (Zoogloea ramigera), loose Alcaligenes (Alcaligenes latus), Alcaligenes (Alcaligenes sp.) SH-69, eat sour Dai Erfute bacterium (Delftia acidovorans), burkholderia (Burkholderia sp.) DSMZ9242, alcaligenes eutrophus (Ralstonia eutrophia) H16, Burkholderia cepacia (Burkholderia cepacia), Rhodococcus ruber (Rhodococcus rubber) PP2, Gordon Salmonella (Gordonia rubripertinctus), Rickettsia prowazeki (Rickettsia prowazekii), cytoalgae (Synechocystis sp.) PCC6803, outer sulphur rhodospirillum (Ectothiorhodospira shaposhnikovii) N1 of Sharpe, Pu Shi pod sulphur bacterium (Thiocapsa pfennigii) 9111, the different chomophoric bacterium of wine and women-sensual pursuits (Allochromatium vinosum) D, purple capsule sulphur bacterium (Thyocystis violacea) 2311, the red bacterium of class ball (Rhodobacter sphaeroides), Paracoccus denitrificans (Paracoccus denitrificans), the red bacterium of pod membrane (Rhodobacter capsulatus), crescent handle bacillus (Caulobacter crescentus), turn round demethylation bacillus (Methylobacterium extorquens), Azorhizobium caulinadans (Azorhizobium caulinodans), agrobacterium tumefaciens (Agrobacterium tumefaciens), Sinorhizobium meliloti (Sinorhizobium meliloti) 41, the 1 type PHA synthase of Crimson rhodospirillum (Rhodospirillum rubrum) HA and Crimson rhodospirillum ATCC25903, from China pink burkholderia (Burkholderia caryophylli), Pseudomonas chlororaphis (Pseudomonas chloraphis), pseudomonas Pseudomonas sp.) 61-3, pseudomonas putida (Pseudomonas putida) U, Pseudomonas oleovorans Pseudomonas oleovorans), Pseudomonas aeruginosa (Pseudomonas aeruginosa), Pseudomonas resinovorans (Pseudomonas resinovorans), pseudomonas stanieri (Pseudomonas stutzeri), pseudomonas mendocina (Pseudomonas mendocina), pseudomonas pseudoalcaligenes (Pseudomonas pseudolcaligenes), pseudomonas putida (Pseudomonas putida) BM01, Pseudomonas nitroreducens (Pseudomonas nitroreducins), 2 type PHA synthase of Pseudomonas chlororaphis (Pseudomonas chloraphis), and from the 4 type PHA synthase of bacillus megaterium (Bacillus megaterium) and genus bacillus (Bacillus sp.) INT005.
In other embodiments, the polymkeric substance synthase is from Gram-negative and Gram-positive eubacterium or from the PHA polymkeric substance synthase of archeobacteria.
In Multi-instance, the polymkeric substance synthase can comprise the PHA polymkeric substance synthase that is respectively the greedy copper bacterium (C.necator) of hookworm, Pseudomonas aeruginosa (P.aeruginosa), the different chomophoric bacterium of wine and women-sensual pursuits (A.vinosum), bacillus megaterium (B.megaterium), dead sea salts box bacterium (H.marismortui), Pseudomonas aureofaciens (P.aureofaciens) or the pseudomonas putida (P.putida) of AY836680, AE004091, AB205104, AF109909, YP137339, AB049413 and AF150670 from preserving number.
other is applicable to polymkeric substance synthase of the present invention and comprises from respectively with the polymkeric substance synthase of the biology of preserving number sign: alcaligenes eutrophus (A34341), Pu Shi pod sulphur bacterium (X93599), aeromonas punctata (O32472), pseudomonas 61-3(AB014757 and AB014758), the red bacterium of class ball (AAA72004), chromobacterium violaceum (AAC69615), Bo Ku island alkane eating bacteria (A.borkumensis) SK2(CAL17662), Bo Ku island alkane eating bacteria SK2(CAL16866), the red bacterium KD131(ACM01571 of class ball and YP002526072), opaque rhodococcus (R.opacus) B4(BAH51880 and YP002780825), bite burkholderia (B.multivorans) ATCC17616(YP001946215 and BAG43679) more, Bo Ku island alkane eating bacteria SK2(YP693934 and YP693138), Crimson rhodospirillum (AAD53179), γ mycetozoan (gamma proteobacterium) HTCC5015(ZP05061661 and EDY86606), fixed nitrogen vibrios (Azoarcus sp.) BH72(YP932525), chromobacterium violaceum ATCC12472(NP902459), lake deposit bacillus (Limnobacter sp.) MED105(ZP01915838 and EDM82867), M.algicola DG893(ZP01895922 and EDM46004), the red bacterium of class ball (CAA65833), chromobacterium violaceum ATCC12472(AAQ60457), loose Alcaligenes (AAD10274, AAD01209 and AAC83658), have a liking for narrow food sporangium (S.maltophilia) K279a(CAQ46418 of Fructus Hordei Germinatus and YP001972712), Ralstonia solanacearum (R.solanacearum) IPO1609(CAQ59975 and YP002258080), bite burkholderia ATCC17616(YP001941448 and BAG47458) more, pseudomonas gl13(ACJ02400), pseudomonas gl06(ACJ02399), pseudomonas gl01(ACJ02398), root nodule bacterium (R.sp.) gl32(ACJ02397), rhizobium leguminosarum (R.leguminosarum bv.viciae) 3841(CAK10329 and YP770390), fixed nitrogen vibrios BH72(CAL93638), pseudomonas LDC-5(AAV36510), L.nitroferrum2002(ZP03698179), Soxhlet bacterium (Thauera sp.) MZ1T(YP002890098 and ACR01721), radiation hardness methyl bacillus (M.radiotolerans) JCM2831(YP001755078 and ACB24395), methyl bacillus 4-46(YP001767769 and ACA15335), L.nitroferrum2002(EEG08921), Paracoccus denitrificans (BAA77257), the auspicious Fes Grindelwald of lattice magnetic spirillum (M.gryphiswaldense) (ABG23018), pseudomonas USM4-55(ABX64435 and ABX64434), Aeromonas hydrophila (AAT77261 and AAT77258), genus bacillus INT005(BAC45232 and BAC45230), pseudomonas putida (AAM63409 and AAM63407), Gordon Salmonella (G.rubripertinctus) (AAB94058), bacillus megaterium (AAD05260), eat sour Dai Erfute bacterium (BAA33155), have a liking for the secondary coccus of Serine (P.seriniphilus) (ACM68662), pseudomonas 14-3(CAK18904), pseudomonas LDC-5(AAX18690), pseudomonas PC17(ABV25706), pseudomonas 3Y2(AAV35431, AAV35429 and AAV35426), pseudomonas mendocina (AAM10546 and AAM10544), Pseudomonas nitroreducens (P.nitroreducens) (AAK19608), pseudomonas pseudoalcaligenes (AAK19605), Pseudomonas resinovorans (AAD26367 and AAD26365), pseudomonas USM7-7(ACM90523 and ACM90522), Pseudomonas fluorescens (P.fluorescens) (AAP58480) and other culturing bacterium (BAE02881 not, BAE02880, BAE02879, BAE02878, BAE02877, BAE02876, BAE02875, BAE02874, BAE02873, BAE02872, BAE02871, BAE02870, BAE02869, BAE02868, BAE02867, BAE0286, BAE02865, BAE02864, BAE02863, BAE02862, BAE02861, BAE02860, BAE02859, BAE02858, BAE02857, BAE07146, BAE07145, BAE07144, BAE07143, BAE07142, BAE07141, BAE07140, BAE07139, BAE07138, BAE07137, BAE07136, BAE07135, BAE07134, BAE07133, BAE07132, BAE07131, BAE07130, BAE07129, BAE07128, BAE07127, BAE07126, BAE07125, BAE07124, BAE07123, BAE07122, BAE07121, BAE07120, BAE07119, BAE07118, BAE07117, BAE07116, BAE07115, BAE07114, BAE07113, BAE07112, BAE07111, BAE07110, BAE07109, BAE07108, BAE07107, BAE07106, BAE07105, BAE07104, BAE07103, BAE07102, BAE07101, BAE07100, BAE07099, BAE07098, BAE07097, BAE07096, BAE07095, BAE07094, BAE07093, BAE07092, BAE07091, BAE07090, BAE07089, BAE07088, BAE07053, BAE07052, BAE07051, BAE07050, BAE07049, BAE07048, BAE07047, BAE07046, BAE07045, BAE07044, BAE07043, BAE07042, BAE07041, BAE07040, BAE07039, BAE07038, BAE07037, BAE07036, BAE07035, BAE07034, BAE07033, BAE07032, BAE07031, BAE07030, BAE07029, BAE07028, BAE07027, BAE07026, BAE07025, BAE07024, BAE07023, BAE07022, BAE07021, BAE07020, BAE07019, BAE07018, BAE07017, BAE07016, BAE07015, BAE07014, BAE07013, BAE07012, BAE07011, BAE07010, BAE07009, BAE07008, BAE07007, BAE07006, BAE07005, BAE07004, BAE07003, BAE07002, BAE07001, BAE07000, BAE06999, BAE06998, BAE06997, BAE06996, BAE06995, BAE06994, BAE06993, BAE06992, BAE06991, BAE06990, BAE06989, BAE06988, BAE06987, BAE06986, BAE06985, BAE06984, BAE06983, BAE06982, BAE06981, BAE06980, BAE06979, BAE06978, BAE06977, BAE06976, BAE06975, BAE06974, BAE06973, BAE06972, BAE06971, BAE06970, BAE06969, BAE06968, BAE06967, BAE06966, BAE06965, BAE06964, BAE06963, BAE06962, BAE06961, BAE06960, BAE06959, BAE06958, BAE06957, BAE06956, BAE06955, BAE06954, BAE06953, BAE06952, BAE06951, BAE06950, BAE06949, BAE06948, BAE06947, BAE06946, BAE06945, BAE06944, BAE06943, BAE06942, BAE06941, BAE06940, BAE06939, BAE06938, BAE06937, BAE06936, BAE06935, BAE06934, BAE06933, BAE06932, BAE06931, BAE06930, BAE06929, BAE06928, BAE06927, BAE06926, BAE06925, BAE06924, BAE06923, BAE06922, BAE06921, BAE06920, BAE06919, BAE06918, BAE06917, BAE06916, BAE06915, BAE06914, BAE06913, BAE06912, BAE06911, BAE06910, BAE06909, BAE06908, BAE06907, BAE06906, BAE06905, BAE06904, BAE06903, BAE06902, BAE06901, BAE06900, BAE06899, BAE06898, BAE06897, BAE06896, BAE06895, BAE06894, BAE06893, BAE06892, BAE06891, BAE06890, BAE06889, BAE06888, BAE06887, BAE06886, BAE06885, BAE06884, BAE06883, BAE06882, BAE06881, BAE06880, BAE06879, BAE06878, BAE06877, BAE06876, BAE06875, BAE06874, BAE06873, BAE06872, BAE06871, BAE06870, BAE06869, BAE06868, BAE06867, BAE06866, BAE06865, BAE06864, BAE06863, BAE06862, BAE06861, BAE06860, BAE06859, BAE06858, BAE06857, BAE06856, BAE06855, BAE06854, BAE06853 and BAE06852).
In different embodiments, the polymkeric substance synthase can be by making substrate (R)-hydroxyl acyl group-CoA or other CoA thioesters or derivatives thereof polymerization or promoting its polymerization to be used at the external polymer particles for preparing.
In different embodiments, substrate or substrate mixture comprise amino acid, lactic acid salt, ester or the saturated or unsaturated fatty acids of at least a optional replacement, preferred acetyl-CoA.
In different embodiments, catalyzer is enzyme.In representative example, catalyzer is enzyme, and precursor substance is enzyme substrates, and target substance is the enzymic catalytic reaction product.In further embodiment, the polymer particles group can comprise more than one or more enzymes.Be contemplated that especially polymer particles group wherein comprises the embodiment of two or more enzymes, wherein reaction product, by another kind of enzyme catalysis, for example, comprises two or more enzymes of partly or entirely synthetic or catalytic pathway.
In one embodiment, one or more polymer particles are combined with permeable or semi-permeable carrier enduringly.In another embodiment, one or more polymer particles reversibly are combined with permeable or semi-permeable carrier.
In different embodiments, one or more polymer particles covalently or non-covalently are bonded to semi-permeable strainer.For example, one or more polymer particles are adsorbed on semi-permeable carrier or film.In another example, one or more polymer particles comprise the part that can be bonded to semi-permeable carrier or film.In different embodiments, semi-permeable carrier comprises following one or more: polyethersulfone, PVDF, PP, PEES HDPE(high density polyethylene(HDPE)), the PP(polypropylene), the PEEK(polyether-ether-ketone), PET and FEP(fluorinated ethylene propylene).In another embodiment, semi-permeable carrier comprises and comprises, for example, and the polysaccharide of Mierocrystalline cellulose, derivation Mierocrystalline cellulose or stable fibers element.In another embodiment, semi-permeable carrier comprises one or more potteries.
In different embodiments, semi-permeable strainer is one of following structure: curling, plate rail, flat board, tubular fibre, rotating disk or tubulose.The example can provide as box or cylinder expediently.
In different embodiments, under following one or more exist, by tangential flow filtration prepare, one or more polymer particles of isolated or purified: sanitising agent, pH adjusting agent, one or more solvents, one or more chaotropic agents, one or more enzymes and one or more mercaptan.For example, tangential flow filtration comprises chemical processing agent for example acid or alkaline purification agent.In different embodiments, the method comprises the exemplified chemical processing agent of one or more this paper, for example, and the processing of example shown in one ormore embodiment 12.
In different embodiments, use the method for tangential flow filtration preparation, one or more materials of isolated or purified or one or more polymer particles to comprise to homogenize, Micro Fluid, ultrasonic, centrifugal or its any combination, or homogenizing, Micro Fluid, ultrasonic, centrifugal or its arbitrarily in conjunction with before or after.
In different embodiments, part that can binding antibody is selected from albumin A, Protein G, albumin A/G, albumen L, its restructuring variant, comprise its functional fragment (for example Z territory of albumin A) of its recombination function fragment and it is arbitrarily in conjunction with (for example comprising in abutting connection with the ZZ territory in the Z territory of repetitive proteins A).
Be intended to (for example mentioning numerical range disclosed herein, 1-10) also be embodied in to all be within this scope rational number (for example, 1,1.1,2,3,3.9,4,5,6,6.5,7,8,9 and 10) and any scope that is in the rational number within this scope (for example, 2-8,1.5-5.5 and 3.1-4.7) mention, therefore, whole subranges of the clear and definite disclosed four corner of this paper are therefore by open clearly.These are only the examples that clearly means, and similarly, between cited Schwellenwert and maximum, all possible combinations of values should be considered as clearly being set forth in the application.
In the situation that this specification sheets referenced patents specification sheets, other external documents or out of Memory source, normally for the purpose of the background that feature of the present invention is discussed is provided.Unless expressly stated otherwise,, quoting of this external documents is not interpreted as admitting the document or this information source common practise as prior art or component part this area.
Further aspect of the present invention and advantage will be by the descriptions subsequently that only provide in the mode of embodiment and are become apparent.
Description of drawings
Fig. 1 has presented tangential flow filtration schematic diagram (Figure 1A) and exemplary simple tangential flow filtration system (figure IB), and described system utilizes fresh feed pump to pass tangential flow filtration film cylinder and recirculation with the penetrant in the permission system by feed storage tank.
Fig. 2-4 have shown available to use the inventive method by the source liquid purifying or to prepare the general scheme of one or more target substances.
Fig. 5 has presented as analyzing photo for the micro polymer corpuscular protein figure of the ZZPhaC-polymer particles of the tangential flow filtration purifying of IgG immunoglobulin (Ig) (Coomassie blue and silver dyeing) SDS-PAGE as described in thispaper embodiment.Line 1, the MW mark;Line 2, not filtering particle;Line 3, from the retentate of 100kDa filtration;Line 4, from the retentate of 0.1 μ m filtration;Line 3, from the retentate of 0.2 μ m filtration.
Fig. 6 presented as described in this paper embodiment for the micro polymer corpuscular protein figure GC/MS spectrum of the ZZPhaC-polymer particles of the tangential flow filtration purifying of IgG immunoglobulin (Ig).
Fig. 7 presented as ZZ-polymer particles as described in this paper embodiment before with the feed diafiltration (A) and with the feed diafiltration after the transmission electron microscope photo of (B).
Fig. 8 is for showing the figure from diafiltration level part elution curve of BSA and IgG mixture TFF diafiltration.A5BSA is not bonded to the polymer particles of the present invention that comprises the Z-territory and easily from this system, removes.(be in level part 13) after concentrating and with 50mM Citrate trianion 150mM salt (pH3.0), processing the retentate pearl, IgG discharges also easily from this retentate diafiltration from this pearl.
The SDS-PAGE that Fig. 9 has described diafiltration level part analyzes, and described diafiltration level part comes the IgG TFF that free BSA obtains to separate as described in this paper embodiment 2.Fig. 9 A has shown the wash-out (1x PBS pH7.4 scrubbing stage part) that contains BSA level part in a TFF280nm peak.Fig. 9 B has shown with Citrate trianion (pH3.0) diafiltration and has comprised after the polymer particles of the present invention of Z-territory pearl the wash-out that contains IgG level part.
Figure 10 is the elution curve that has shown from lowlenthal serum purifying goat IgG, and as described in Example 3, described purifying uses polymer particles of the present invention and the TFF that comprises from the GB1-territory of Protein G.Hatch together with the 5g weight in wet base polymer particles of the present invention that comprises GB1-territory particulate and 50mL1:10 dilution (in PBS) lowlenthal serum suspension and subsequently to its diafiltration (50cm2Cylinder, 0.1um) to remove serum protein.Be concentrated into wash-out IgG after 20mL and be directed to 50mM Trisodium Citrate (pH3.0) diafiltration in 150mM NaCl inlevel part 15 places.
Figure 11 has shown that the SDS-PAGE from IgG purifying TFF diafiltration level part of lowlenthal serum analyzes.Figure 11 A has shown the silver-colored dyeing blood white protein of wash-out from TFF.It is that wash-out is from the albumen of TFF after 3.0 Citrate trianion diafiltration that Figure 11 B has shown with pH, and as major protein in wash-out level part, IgG heavy chain and IgG light chain are high-visible.
Figure 12 has shown the survey sheet that uses as described in Example 4 TFF and the polymer particles of the present invention that comprises gold combination-territory that gluey gold is removed from solution.Make the 30ml suspension of 0.005% gluey gold have 20cm2, 0.2um tubular fibre micro-filtration cylinder the TFF system in circulate, permeate stream is 9ml/min.Locate in 8,13 and 29 minutes (*), to retentate, add respectively 30mg, 300mg and 300mg to comprise the polymer particles of the present invention in gold combination-territory.Measure the light absorption ratio of gluey gold in penetrant in the 520nm place.
Figure 13 has shown as using as described in thispaper embodiment 5 TFF to reclaim the figure of maltose in conjunction with particulate from the amylase of starch bio-transformation mediation.Use the poly-Enz-Amy pearl of 2g that soluble starch suspension (300ml%, 4% and 8%w/v) is converted into maltose.By the TFF filtering suspension liquid to reclaim the maltose in penetrant and comprise this pearl in retentate level part.
Figure 14 has shown during TFF as described in Example 7 and uses organophosphor hydrolytic enzyme in conjunction with the conversion to p-NP of the parathion-methyl of particulate.Make 30ml parathion-methyl solution (200uM) have 20cm2, 0.2um tubular fibre cylinder the TFF system in circulate.Record the two-wheeled bio-transformation under the same terms.
Figure 15 shown as use as described in thispaper embodiment 7 the TFF diafiltration from organophosphor hydrolytic enzyme in conjunction with removing p-NP microparticle suspending liquid.
Figure 16 shown as described in thispaper embodiment 8 for purifying directly from the simplification of the PHB polymer particles of cell homogenates cross flow filter processing scheme figure on a small scale.Layout strategy is to allow by carry out high dispersing homogenate suspension with extensive Micro Fluid.After homogenizing, added DNA enzyme and MgCl before filtering2To dwindle the size of DNA fragmentation.Excessively add in a large number MgCl to EDTA2To allow the DNA enzyme activation.During TFF, the diafiltration of homogenate suspension is entered the diafiltration buffer of eight volumes to remove host cell proteins and nucleic acid.
Figure 17 A has described the penetrant elution curve TFF as 250ml granular cell homogenate as described in this paper embodiment 9.On cell homogenates, at 110cm20.1 use the PBS-EDTA-20% ethanol of 8 diafiltration volumes to carry out the TFF purifying on μ m tubular fibre cylinder.Fig. 7 B is from the Bradford albumen test chart on diafiltration level part of cell homogenates TFF purifying.Fig. 7 C is the SDS-PAGE of diafiltration level part.At 15%Gel(line 1, mw std;Line 2, the 20 final pearl suspension of μ m) diafiltration level part 1-8(line 3-10 ofupper operation 20 μ m sample sizes).Sample loads and does not regulate protein content by volume.
Figure 18 has described as the penetrant analysis by the PHB particulate with 0.2% deoxidation courage ester TFF purifying as described in this paper embodiment 10.As shown in the figure, symbology is crossed over diafiltration level part A260(Δ that 12 diafiltration volumes are collected) and A280nm(■) the light absorption ratio measurement, also shown the pH(o that measures simultaneously).For the 10mM Tris10mM EDTA0.2% deoxidation courage ester pH11 of 8 volumes, the PBS(pH7.4 of 4 volumes subsequently) the diafiltration particulate.
Figure 19 has shown as after TFF purifying as described in thispaper embodiment 10, comprises the IgG binding ability test of the polymer particles of the present invention in Z-territory.After diafiltration, in a plurality of solution (table 2) that contain 0.2% deoxidation courage ester, under room temperature at PBS(pH7.4) in hatch together with 30 minutes with 5mg IgG and 50mg sample size pearl.After hatching, centrifugal polymerization thing particulate to be to remove unconjugated level part and to use subsequently carbohydrate gum damping fluid (pH2.7) wash-out, with from comprising the polymer particles wash-out IgG of the present invention in Z-territory.The recentrifuge polymer particles and use that Bradford albumen experimental measurement reclaims wash out IgG in supernatant liquor.
Figure 20 has described the penetrant analysis as the polymer particles of the present invention that comprises the GB1-territory of the open runner TFF of use as described in thispaper embodiment 11 system.The PHB polymer particles of rouble Ruo Er (lubrol)-extraction is loaded 4 axial systems to Millipore Prostak –.Suspend this pearl to produce 1.3 liters of retentates, and collect and analyze 1 liter of diafiltration level part.
Figure 21 has shown as after TFF purifying as described in thispaper embodiment 11, comprises the IgG binding ability test of the polymer particles of the present invention in GB1-territory.After glycerine gradient or TFF-rouble Ruo Erji process purifying, under room temperature at PBS(pH7.4) in hatch together with 30 minutes with the polymer particles of 5mg IgG and 50mg sample size.After hatching, the isolating polymer particulate to be to remove unconjugated level part and to use subsequently carbohydrate gum damping fluid (pH2.7) wash-out, with from polymer particles wash-out IgG.The recentrifuge polymer particles and use that Bradford albumen experimental measurement reclaims wash out IgG in supernatant liquor.
Figure 22 be multiple extraction agent to host cell proteins/nucleic acid remove with cell extract in from the residual depiction in conjunction with activity influence of the polymer particles of the present invention that comprises the Z-territory.Figure 22 A has shown batch washing supernatant A 260nm and the A280nm light absorption ratio result that is diluted in (20%, in the place of needs) in PBS.Figure 22 B has shown IgG in conjunction with activity, wherein the crude polymer particle sphere wash inPBS 1 time, under 5000xg centrifugal 20 minutes and weigh exsiccation bead and gravimetry normalizing IgG in conjunction with activity.
Figure 23 has shown the scalable scheme that is used for from bacterium living beings matter purifying PHB polymer particles.
Figure 24 shown as described in thispaper embodiment 14 by the extraction of SDS sanitising agent, host cell biomolecule matter removes from the PHB polymer particles.Two independent sub-batch secondary substances (1.1-1.2kg) are suspended into 0.08%SDS, the 25mM Tris10mM EDTA(pH11 of 2.7 liters) and Micro Fluid.Carry out chemical washing in succession respectively at 2.7L, 1L and 1L volume in dissolving damping fluid, 10mM thioglycerin and 0.1M NaOH.Measure the weight in wet base of crude polymer particulate in each treatment step.
Figure 25 has described as penetrant analysis purifying with SDS base TFF purge process as described in this paper Figure 14, polymer particles of the present invention that comprise the Z-territory.SDS is extracted the PHB pearl fill in the Millipore Prostak system (0.41m with 3 two shaft models2).Pearl is suspended to produce 2 liters of retentates and two liters of diafiltration level parts, then collect and analyze 260,280,600nm light absorption ratio and pH.
Figure 26 has described to analyze as the SDS-PAGE with the PHB pearl of SDS base TFF process purifying as described in embodiment 14.The sample size (25 μ l) that will have 5ul sample buffer and 20 each sample of μ l fills on the 8-15% gradient gel.Identified as samples is designated as the 1.MW mark, and 2. the granular cell lysate, 3. dissolve post polymerization thing particulate, 4. dissolve damping fluid (SDS) washing post polymerization thing particulate, 5. thioglycerin washs post polymerization thing particulate, and 6.NaOH washs post polymerization thing particulate (before TFF), 7.TFF purifying post polymerization thing particulate.
Detailed Description Of The Invention
The present invention relates to the method and composition for the tangential flow filtration technology.Tangential flow filtration is a kind of isolation technique, and wherein the feed tangential flow is to film (with respect to being basically perpendicular to film in dead-end filtration).This tangential flow produces different pressure along film.As a result of, some particulate passes film, and other particulate continues along membrane flow (referring to Figure 1A), and it is in some cases in order to cleaning film.When with dead-end filtration, comparing, the tangential flow obstruction that particulate enters the strainer cake of usually slowing down.Other will be well known to those skilled in the art by benefit that the tangential flow filtration system realizes, and comprise that high liquid volume capacity, high target substance binding ability, polymer particles, chromatography resin, film easily regenerate, etc.
Definition
As used herein, term " amorphous polymer " is understood to the irregular alignment of molecular chain no matter and is those polymkeric substance of solid under room temperature.These polymkeric substance are amorphous on substantially, and their degree of crystallinity is usually less than 20%, preferably lower than 15%, lower than 10%, lower than 5%, preferably lower than 2% or be 0%.Those amorphous polymers are particularly suitable for second-order transition temperature TGBe 0 °-60 ℃, preferred 0 °-50 ℃, preferred 0 °-40 ℃, preferred 0 °-35 ℃, and be in particular 0 °-30 ℃ those.
As used herein, term " biological polymer " is understood to can be by biological systems or those synthetic polymkeric substance of entity, such as but not limited to organism, cell or albumen.Correspondingly, term " biological polyester " and " biological polythioester " are understood to respectively to pass through biological systems or synthetic those polyester and the polythioester of entity.Example comprises polyester and the polyhydroxycarboxyliacid acid ester by various bacteria and archeobacteria preparation, typically as a kind of means that store carbon or energy, such as but not limited to polythioester and PHA.
Term " coding region " or " open reading frame " (ORF) refer to and can prepare the genomic dna sequence of transcription product and/or polypeptide or the sense strand of cDNA sequence under suitable regulating and controlling sequence is controlled.Encoding sequence is identified by the existence of 5' translation initiation codon and 3' translation stop codon.In the time of in inserting genetic constructs, when it effectively was connected to promotor and terminator sequence, " encoding sequence " can be expressed.
In this specification sheets, term used " comprises (comprising) " and means " at least in part by ... form ".When each comprises the statement that term " comprises " in explaining this specification sheets, also can exist divided by this term start that or those outside feature.Relevant term for example " comprises (comprises) " to be explained in an identical manner.
Term " pollutent " refers in source material the material that is different from target substance, and removes from the preparation of ultimate aim material ideally.Typical biology source material pollutent comprises nucleic acid, albumen, peptide, intracellular toxin, virus etc.The pollutent that can remove by the practice of the inventive method has one or more and is different from the character of required product characteristics, such as molecular weight, electric charge, for specificity avidity of multiple ligands etc.
Term " tangential flow filter " and grammer equivalents refer to a class at this paper and comprise filter module or the filter box of porous, permeable or semi-permeable filter element, source medium to be filtered is crossed described element surface and is flowed in the tangential flow mode, for example is used for passing this filter element infiltration selected source medium element or pollutent.
Term " coupling agent " refers to the inorganic or organic compound that is applicable in conjunction with at least a material as used herein, perhaps is applicable in a side in conjunction with coupling agent and at opposite side other coupling agent in conjunction with at least a material.The illustrative methods that is applicable to particulate of the present invention or fusion rotein chemical modification method that comprises of suitable coupling agent example and their application is illustrated in the PCT/DE2003/002799(Bernd Rehm that publication number is WO2004/020623), at this by reference to its integral body, incorporating into.
Term " expression construct " refers to and comprises the polynucleotide molecule that allows to transcribe insertion, and randomly transcript is translated into the genetic constructs of the element of polypeptide.Expression construct typically comprises in 5' to 3' direction:
(1) promotor, work in the host cell of construct to be introduced,
(2) polynucleotide to be expressed, and
(3) terminator, work in the host cell of construct to be introduced.
Expression construct of the present invention is inserted into for clone or the replicable vector of be used for expressing, or mergedly enters host genome.
Be fit to adjust and be applicable to expression construct example of the present invention and be provided in the PCT/DE2003/002799(Bernd Rehm that publication number is WO2004/020623) and publication number be the PCT/NZ2006/000251(Bernd Rehm of WO2007/037706) in, be incorporated herein by reference in full at this.
This paper forms at particulate term " formation polymer particles " and " formation of polymer particles " used in albumen and refers to the activity of particulate formation albumen as discussed herein.
Polypeptide " fragment " is for exercising enzymic activity or in conjunction with active required function and/or the polypeptide subsequence of polypeptide three-dimensional structure is provided.
Term " fusion polypeptide " refers to many that comprise two or more aminoacid sequences as used herein, and for example amino and the carboxyl residue of two or more polypeptide structure territory by separately merges to form the polypeptide of single continuous polypeptide with peptide bond.Should be appreciated that two or more aminoacid sequences can directly merge, or via connexon or spacerarm or additional polypeptide by they amino and carboxyl terminal and fusions indirectly separately.
In one embodiment, one of aminoacid sequence that comprises fusion polypeptide comprises particulate and forms albumen.In one embodiment, one of aminoacid sequence that comprises fusion polypeptide comprises the polymkeric substance synthase.
In one embodiment, one of aminoacid sequence that comprises fusion polypeptide comprises fusion partner.
term " fusion partner " refers to polypeptide as used herein, albumen for example, protein fragments, in conjunction with territory, target is in conjunction with territory, in conjunction with albumen, in conjunction with protein fragments, antibody, antibody fragment, heavy chain of antibody, light chain of antibody, single-chain antibody, single domain antibody (for example VHH), the Fab antibody fragment, the Fc antibody fragment, the Fv antibody fragment, F (ab') 2 antibody fragments, the Fab' antibody fragment, scFv (scFv) antibody fragment, antibody binding domain (for example ZZ territory), antigen, antigenic determinant, epitope, haptens, immunogen, immunogen fragment, vitamin H, biotin derivative, avidin, Streptavidin, substrate, enzyme, abzyme, cofactor, acceptor, receptor fragments, receptor subunit, the receptor subunit fragment, part, supressor, hormone, lectin, the poly Histidine, the coupling territory, DNA is in conjunction with territory, the FLAG epi-position, cysteine residues, the library peptide, reporter polypeptide, the affinity purification peptide, or its two or more any combination arbitrarily.
Should be appreciated that above listed two or more polypeptide can form fusion partner.
In one embodiment, the aminoacid sequence of fusion polypeptide merges indirectly via connexon or spacerarm, the aminoacid sequence of described fusion polypeptide puts in order as polymkeric substance synthase-connexon-fusion partner, or fusion partner-connexon-polymkeric substance synthase.In other embodiments, the aminoacid sequence of fusion polypeptide indirectly merges via additional polypeptide or comprises additional polypeptide, and it puts in order as polymkeric substance synthase-additional polypeptide-fusion partner, or polymkeric substance synthase-connexon-fusion partner-additional polypeptide.Again, this paper has considered that especially the N-end of polymkeric substance synthase extends.
In an exemplary, the aminoacid sequence of fusion polypeptide merges indirectly via connexon or spacerarm, for example, putting in order as polymkeric substance synthase-connexon-antibodies polypeptide, or antibodies polypeptide-connexon-polymkeric substance synthase or polymkeric substance synthase-connexon-enzyme or enzyme-connexon-polymkeric substance synthase of the aminoacid sequence of described fusion polypeptide.In other exemplary, the aminoacid sequence of fusion polypeptide indirectly merges via additional polypeptide or comprises additional polypeptide, it puts in order as: polymkeric substance synthase-additional polypeptide-antibodies polypeptide, or polymkeric substance synthase-additional polypeptide-enzyme or polymkeric substance synthase-connexon-antibodies polypeptide-additional polypeptide, or polymkeric substance synthase-connexon-enzyme-additional polypeptide.Again, this paper has considered that especially the N-end of polymkeric substance synthase extends.
Also can comprise the one or more peptide sequences that are inserted in another peptide sequence according to fusion polypeptide of the present invention.For example, peptide sequence such as protease recognition sequence are inserted into and comprise in the variable region of particulate in conjunction with the albumen in territory.
Expediently, fusion polypeptide of the present invention is by single nucleic acid sequence encoding, and wherein nucleotide sequence comprises the subsequence of at least two difference coded polypeptides or polypeptide domain.In certain embodiments, described at least two subsequences with " same reading frame " thus have to form single open reading frame coding fusion polypeptide as desired in this paper.In other embodiments, described at least two subsequences " different reading frame " exist, and by other sequence of rrna reading frame frameshit site or promotion reading frame frameshit, are separated, thereby form fusion polypeptide after translation.In certain embodiments, at least two subsequences are adjacency.In other embodiments, for example wherein at least two polypeptide discussed above or polypeptide domain indirectly merge via additional polypeptide those, at least two subsequences are adjacency not.
To " in conjunction with territory " or " can in conjunction with territory " be intended to represent complementaryly in conjunction with right half, and can comprise from above listed in conjunction with right.For example, antibody-antigen, antibody-antibody binding domain, vitamin H-Streptavidin, receptor-ligand, enzyme-supressor pair.Target, in connection with the target molecule in sample, and is for example antibody or antibody fragment in conjunction with territory.Polypeptide-in conjunction with territory is in connection with polypeptide, and for example for antibody or antibody fragment carry out autoreceptor or signal protein in conjunction with territory.
Comprise albumen, protein fragments, peptide, polypeptide, polypeptide fragment, antibody, antibody fragment, antibody binding domain, antigen, antigen fragment, antigenic determinant, epi-position, haptens, immunogen, immunogen fragment, pharmaceutically active agents, biologically active agent, adjuvant or its two or more any combination arbitrarily by the material example in conjunction with the territory combination.This material is according in the sample of the inventive method analysis " target components ".
Correspondingly, the territory of combining target material " can " and grammer equivalents will be understood to refer to complementary a kind of component in conjunction with centering, and wherein another kind of component is target substance.
Term " genetic constructs " refers to polynucleotide molecule, is generally double-stranded DNA, and it may insert its other polynucleotide molecules (polynucleotide molecule of insertion) such as, but not limited to, the cDNA molecule.Genetic constructs can contain the polynucleotide molecule that allows to transcribe insertion, and randomly, this transcript is translated into the necessary element of polypeptide.In a plurality of embodiments, the polynucleotide molecule of insertion is derived from host cell, or derives from different cells or organism and/or be recombination of polynucleotide.In one embodiment, in case enter host cell, genetic constructs is incorporated into host genome, for example in host chromosome DNA.In an example, genetic constructs is connected in carrier.
Term " host cell " refers to for example mammalian host cell of bacterial cell, fungal cell, yeast cell, vegetable cell, insect cell or zooblast, it is 1) natural PHA particulate prepares host cell or 2) carry the host cell of expression construct, described expression construct comprises the nucleotide sequence of encode thiolase and reductase enzyme at least and optional phasin.Need which kind of gene to increase that host cell forms for polymer particles that gene that the key element lack will depend on host cell forms and substratum in which kind of substrate of providing.
Term as used herein " connexon or spacerarm " relates to amino acid or the nucleotide sequence of two or more nucleotide sequences of the two or more polypeptide of indirect fusion or two or more polypeptide of encoding.In certain embodiments, connexon or spacerarm are about 1,5,10,15,20,25,30,35,40,45,50,55,60,65,70,75,80,85,90,95 or approximately 100 amino acid or Nucleotide.In other embodiments, connexon or spacerarm are about 100,125,150,175,200,225,250,275,300,325,350,375,400,450,500,550,600,650,700,750,800,850,900,950 or approximately 1000 amino acid or Nucleotide.In other embodiment still, connexon or spacerarm be about 1-approximately 1000 amino acid or Nucleotide, be about 10-approximately 1000, approximately 50-approximately 1000, approximately 100-approximately 1000, approximately 200-approximately 1000, approximately 300-approximately 1000, approximately 400-approximately 1000, approximately 500-approximately 1000, approximately 600-approximately 1000, approximately 700-approximately 1000, about 800-approximately 1000 or about approximately 1000 amino acid or Nucleotide of 900-.
In one embodiment, connexon or spacerarm can comprise the Restriction Enzyme recognition site.In another embodiment, connexon or spacerarm can comprise the protease cracking recognition sequence, for example enteropeptidase, zymoplasm or Xa factor recognition sequence, or from montage element intron for example.In another embodiment, connexon or spacerarm promote that the independence of fusion polypeptide is folding.
Term " mix group " refers to two or more entity groups as used herein, be in each entity group of mixing within the group in some aspects be in this another entity group within mixing crowd and there are differences.For example, when being used for explaining the expression construct group of mixing, this refers to two or more expression construct groups, and wherein each expression construct group is with regard to the coded fusion polypeptide of this group members or there are differences with regard to some other side (characteristic of the promotor that for example exists in construct) of construct.Perhaps, when being used for explaining fusion polypeptide and mixing the group, this refers to two or more fusion polypeptide groups, and wherein each fusion polypeptide group is with regard to polypeptide, and for example for example antibody binding domain or enzyme, the contained member of this group there are differences for polymkeric substance synthase, fusion partner.For example, be used in the preparation situation of antibody purification, fusion polypeptide is mixed the group and is referred to two or more fusion polypeptide groups, and wherein each fusion polypeptide group is with regard to polypeptide, and for example polymkeric substance synthase, antibody binding domain, the contained member of this group there are differences.Similarly, be used in the preparation situation of target substance, fusion polypeptide is mixed the group and is referred to two or more fusion polypeptide groups, and wherein each fusion polypeptide group is with regard to polypeptide, and for example polymkeric substance synthase, enzyme, precursor there are differences in conjunction with territory, the contained member of this group in conjunction with territory or enzyme-substrate.Still further, when being used for the statement polymer particles and mixing the group, this refers to two or more polymer particles groups, and wherein each polymer particles group there are differences with regard to the entrained fusion polypeptide of this group members.Considered that especially the polymer particles that comprises two or more polymer particles subgroups mixes the group, wherein each subgroup can comprise one or more fusion polypeptide described herein (for example above those).
Term " nucleic acid " refers to strand or the dichain polymer of deoxyribonucleotide, ribonucleotide base or the known analogue of natural nucleotide or its mixture as used herein.Except as otherwise noted, this term comprises the citation to concrete sequence and complementary sequence thereof.Term " nucleic acid " and " polynucleotide " are used interchangeably at this paper.
" effectively connect " means under control that sequence to be expressed is placed in controlling element, and controlling element comprises promotor, tissue specificity controlling element, instantaneous controlling element, enhanser, repressor and terminator.
Term " is crossed and is expressed " and is commonly referred to as over gene product preparation in the host cell of preparation level in normal or unconverted host cell.When being used for the statement messenger rna level, term " cross and express " preferably represent expression level than the height of usually observing in contrast host cell or no transformed cells at least about 3 times.More preferably, expression level than the height of usually observing in contrast host cell or no transformed cells at least about 5 times, approximately 10 times, approximately 15 times, approximately 20 times, approximately 25 times, approximately 30 times, approximately 35 times, approximately 40 times, approximately 45 times, approximately 50 times, approximately 55 times, approximately 60 times, approximately 65 times, approximately 70 times, approximately 75 times, approximately 80 times, approximately 85 times, approximately 90 times, approximately 95 times or approximately 100 times or more than.
The mRNA level is utilized any measurement in multiple technologies well known by persons skilled in the art, includes but not limited to, RNA trace (Northern blot) is analyzed and RT-PCR, comprises quantitative RT-PCR.
Refer to can be in conjunction with albumen and the albumen territory of particulate for term " particulate is in conjunction with albumen " as used herein.This combination can be by the directly mediation with interpolymer interaction, or via the group with being bonded to polymkeric substance, the polymkeric substance synthase that for example is covalently bond to polymkeric substance interacts and mediates.The particulate that is applicable to this paper comprises one or more particulates from albumen that can conjugated polymer particulate core in conjunction with territory in conjunction with albumen, and for example PHA synthase protein C-terminal fragment or polymkeric substance depolymerization particulate are in conjunction with territory.
Art language as used herein " particulate form albumen " refer to particulate form in related albumen.For example, its optional autohemagglutination compound depolymerizing enzyme, polymkeric substance modulin, polymkeric substance synthase and particle size determine albumen.Particulate forms albumen and is preferably selected from thiolase, reductase enzyme, polymkeric substance synthase and phasin (phasin).Particulate formation albumen for example synthase can carry out the formation of catalytic polymer particulate by polymerization substrate or substrate derivant to form polymer particles.Perhaps, for example thiolase, reductase enzyme or phasin can promote the formation of polymer particles by promoting polymerization to particulate formation albumen.For example, but thiolase or reductase enzyme catalysis produce the suitable substrate of polysaccharase.Phasin can be controlled the size of formed polymer particles.Preferred particulate forms albumen and comprises particulate in conjunction with territory and particulate formative region.
As used herein, the situation that term " particulate form reaction mixture " comprises the synthase catalytic domain in host cell or expression construct is down to referring to less the polymkeric substance synthase substrate, perhaps host cell or expression construct comprise other particulates form albumen or and the particulate of non-polymer synthase catalytic domain in conjunction with the situation in territory down to referring to less polymkeric substance synthase and its substrate.
" particle size determines albumen " refers to the albumen of controlling the micro polymer particle size.It can be for example derived from phasin sample protein family, be preferably selected from from those of Bob Lanier Pseudomonas (Ralstonia), Alcaligenes (Alcaligenes) and Rhodopseudomonas (Pseudomonas), more preferably from the phasin gene phaP of Ralstonia eutropha with from the phasin gene phaF of Pseudomonas oleovorans (Pseudomonas oleovorans).Phasin is the Amphiphilic proteins of molecular weight 14-28kDa, and the hydrophobic surface of itself and polymer particles is combined closely.This also can comprise in conjunction with particulate and affect other host cell proteins of particle size.
The polymkeric substance synthase comprises the synthase catalytic domain that is positioned at synthase protein C-end at least, and the polyreaction of its mediation polymkeric substance and synthase protein are connected with particulate core.Be used for polymkeric substance synthase of the present invention and be specified in Rehm, 2003, it incorporates this paper into its integral body by reference.for example, the polymkeric substance synthase is from acinetobacter (Acinetobacter), Vibrio (Vibrio), Aeromonas (Aeromonas), chromobacterium (Chromobacterium), Rhodopseudomonas (Pseudomonas), Zoogloea (Zoogloea), Alcaligenes (Alcaligenes), Dai Erfute Pseudomonas (Delftia), Burkholderia (Burkholderia), Lei Er Bordetella (Ralstonia), Rhod (Rhodococcus), Gordona (Gordonia), red bacterium belongs to (Rhodobacter), paracoccus (Paracoccus), rickettsiae (Rickettsia), Caulobacter (Caulobacter), methyl Bacillaceae (Methylobacterium), nitrogen-fixing root nodule Pseudomonas (Azorhizobium), Agrobacterium (Agrobacterium), rhizobium (Rhizobium), Sinorhizobium belongs to (Sinorhizobium), rickettsiae (Rickettsia), the ancient bacterium door (Crenarchaeota) of spring, synechocystis (Synechocystis), Ectothiorhodospira (Ectothiorhodospira), Thiocapsa (Thiocapsa), 1 type PHA synthase of Thiocystis (Thyocystis) and different Chromatium (Allochromatium), 2 type PHA synthase from Burkholderia (Burkholderia) and Rhodopseudomonas (Pseudomonas), or from the 4 type PHA synthase of bacillus (Bacillus), more preferably from acinetobacter calcoaceticus (Acinetobacter sp.) RA3849, vibrio cholerae (Vibrio cholerae), Vibrio parahemolyticus (Vibrio parahaemolyticus), aeromonas punctata (Aeromonas punctata) FA440, Aeromonas hydrophila (Aeromonas hydrophila), chromobacterium violaceum (Chromobacterium violaceum), pseudomonas (Pseudomonas sp.) 61-3, give birth to branch moving glue bacterium (Zoogloea ramigera), loose Alcaligenes (Alcaligenes latus), Alcaligenes (Alcaligenes sp.) SH-69, eat sour Dai Erfute bacterium (Delftia acidovorans), burkholderia (Burkholderia sp.) DSMZ9242, alcaligenes eutrophus (Ralstonia eutrophia) H16, Burkholderia cepacia (Burkholderia cepacia), Rhodococcus ruber (Rhodococcus rubber) PP2, Gordon Salmonella (Gordonia rubripertinctus), Rickettsia prowazeki (Rickettsia prowazekii), cytoalgae (Synechocystis sp.) PCC6803, outer sulphur rhodospirillum (Ectothiorhodospira shaposhnikovii) N1 of Sharpe, Pu Shi pod sulphur bacterium (Thiocapsa pfennigii) 9111, the different chomophoric bacterium of wine and women-sensual pursuits (Allochromatium vinosum) D, purple capsule sulphur bacterium (Thyocystis violacea) 2311, the red bacterium of class ball (Rhodobacter sphaeroides), Paracoccus denitrificans (Paracoccus denitrificans), the red bacterium of pod membrane (Rhodobacter capsulatus), crescent handle bacillus (Caulobacter crescentus), turn round demethylation bacillus (Methylobacterium extorquens), Azorhizobium caulinadans (Azorhizobium caulinodans), agrobacterium tumefaciens (Agrobacterium tumefaciens), Sinorhizobium meliloti (Sinorhizobium meliloti) 41, the 1 type PHA synthase of Crimson rhodospirillum (Rhodospirillum rubrum) HA and Crimson rhodospirillum ATCC25903, from China pink burkholderia (Burkholderia caryophylli), Pseudomonas chlororaphis (Pseudomonas chloraphis), pseudomonas Pseudomonas sp.) 61-3, pseudomonas putida (Pseudomonas putida) U, Pseudomonas oleovorans Pseudomonas oleovorans), Pseudomonas aeruginosa (Pseudomonas aeruginosa), Pseudomonas resinovorans (Pseudomonas resinovorans), pseudomonas stanieri (Pseudomonas stutzeri), pseudomonas mendocina (Pseudomonas mendocina), pseudomonas pseudoalcaligenes (Pseudomonas pseudolcaligenes), pseudomonas putida (Pseudomonas putida) BM01, Pseudomonas nitroreducens (Pseudomonas nitroreducins), 2 type PHA synthase of Pseudomonas chlororaphis (Pseudomonas chloraphis), and from the 4 type PHA synthase of bacillus megaterium (Bacillus megaterium) and genus bacillus (Bacillus sp.) INT005
Other suitable polymers for the present invention including those from the following organisms synthase , respectively, identified a polymer synthase accession number : Cupriavidus hookworm bacteria (C.necator) (AY836680), Pseudomonas aeruginosa (P.aeruginosa) ( AE004091), wine and women different colored bacteria (A.vinosum) (AB205104), Bacillus megaterium (B.megaterium) (AF109909), dead Sea Salt box bacteria (H.marismortui) (YP137339), To Wong Pseudomonas (P. aureofaciens) (AB049413), Pseudomonas putida (P.putida) (AF150670), really raising Alcaligenes (R.eutropha) (A34341), Platts pod sulfur bacteria (T.pfennigii) (X93599), spot gas Aeromonas (A.punctata) (O32472), Pseudomonas (A.borkumensis) 61-3 (Pseudomonas? sp.) (AB014757 and AB014758), Rhodobacter sphaeroides (R.sphaeroides) (AAA72004), purple color bacilli (C.violaceum) (AAC69615), Island Park library food alkyl bacteria (A.borkumensis) SK2 (CAL17662), Island Park library food alkyl bacteria (A.borkumensis) SK2 (CAL16866), Rhodobacter sphaeroides (R. sphaeroides) KD131 (ACM01571 and YP002526072), opaque Rhodococcus (R.opacus) B4 (BAH51880 and YP002780825), multi- macrophage Burkholderia (B.multivorans) ATCC17616 (YP001946215 and BAG43679), food alkyl bacteria Island Park library (A.borkumensis) SK2 (YP693934 and YP693138), R. rubrum (R.rubrum) (AAD53179), γ Proteobacteria (gamma? proteobacterium) HTCC5015 (ZP05061661 and EDY86606), nitrogen fixation Vibrio (Azoarcus? sp.) BH72 (YP932525), purple color bacilli (C.violaceum) ATCC12472 (NP902459), lake sediments bacilli (Limnobacter? sp.) MED105 (ZP01915838 and EDM82867), M.algicola? DG893 (ZP01895922 and EDM46004), Rhodobacter sphaeroides ( R.sphaeroides) (CAA65833), purple color bacilli (C.violaceum) ATCC12472 (AAQ60457), mast Alcaligenes (A.latus) (AAD10274, AAD01209 and AAC83658), Stenotrophomonas narrow food spp.strain (S.maltophilia) K279a (CAQ46418 and YP001972712), eggplant Corell coli (R.solanacearum) IPO1609 (CAQ59975 and YP002258080), multi- macrophage Burkholderia (B.multivorans) ATCC17616 (YP001941448 and BAG47458), Pseudomonas ( Pseudomonas? sp.) gl13 (ACJ02400), Pseudomonas (Pseudomonas? sp.) gl06 (ACJ02399), Pseudomonas (Pseudomonas? sp.) gl01 (ACJ02398), Rhizobium (R.sp.) gl32 ( ACJ02397), Rhizobium leguminosarum (R.leguminosarum? bv.viciae) 3841 (CAK10329 and YP770390), nitrogen fixation Vibrio (Azoarcus? sp.) BH72 (CAL93638), Pseudomonas (Pseudomonas? sp.) LDC-5 ( AAV36510), L.nitroferrum2002 (ZP03698179), Soxhlet bacteria (Thauera? sp.) MZ1T (YP002890098 and ACR01721), radiation-resistant bacterium methyl (M.radiotolerans) JCM2831 (YP001755078 and ACB24395), methyl bacteria (Methylobacterium? sp .) 4-46 (YP001767769 and ACA15335), L.nitroferrum2002 (EEG08921), Paracoccus denitrificans (P.denitrificans) (BAA77257),Geruisifeiwa Calder gryphiswaldense (M.gryphiswaldense) (ABG23018), false Aeromonas (Pseudomonas? sp.) USM4-55 (ABX64435 and ABX64434), Aeromonas hydrophila (A.hydrophila) (AAT77261 and AAT77258), bacillus (Bacillus? sp.) INT005 (BAC45232 and BAC45230), Pseudomonas putida (P.putida) (AAM63409 and AAM63407), Gordon coli (G.rubripertinctus) (AAB94058), Bacillus megaterium (B.megaterium) (AAD05260), food acid bacteria Delft (D . acidovorans) (BAA33155), addicted to serine Paracoccus (P.seriniphilus) (ACM68662), Pseudomonas (Pseudomonas? sp.) 14-3 (CAK18904), Pseudomonas (Pseudomonas? sp.) LDC-5 (AAX18690), Pseudomonas (Pseudomonas? sp.) PC17 (ABV25706), Pseudomonas (Pseudomonas? sp.) 3Y2 (AAV35431, AAV35429 and AAV35426), Mendoza aeruginosa (P.mendocina) (AAM10546 and AAM10544), nitro reduction Pseudomonas (P.nitroreducens) (AAK19608), Pseudomonas pseudoalcaligenes (P.pseudoalcaligenes) (AAK19605), fresh resin Pseudomonas (P.resinovorans) ( AAD26367 and AAD26365), Pseudomonas (Pseudomonas? sp.) USM7-7 (ACM90523 and ACM90522), Pseudomonas fluorescens (P.fluorescens) (AAP58480) and other uncultured bacteria (BAE02881, BAE02880, BAE02879, BAE02878 , BAE02877, BAE02876, BAE02875, BAE02874, BAE02873, BAE02872, BAE02871, BAE02870, BAE02869, BAE02868, BAE02867, BAE0286, BAE02865, BAE02864, BAE02863, BAE02862, BAE02861, BAE02860, BAE02859, BAE02858, BAE02857, BAE07146, BAE07145, BAE07144, BAE07143 , BAE07142, BAE07141, BAE07140, BAE07139, BAE07138, BAE07137, BAE07136, BAE07135, BAE07134, BAE07133, BAE07132, BAE07131, BAE07130, BAE07129, BAE07128, BAE07127, BAE07126, BAE07125, BAE07124, BAE07123, BAE07122, BAE07121, BAE07120, BAE07119, BAE07118 , BAE07117, BAE07116, BAE07115, BAE07114, BAE07113, BAE07112, BAE07111, BAE07110, BAE07109, BAE07108, BAE07107, BAE07106, BAE07105, BAE07104, BAE07103, BAE07102, BAE07101, BAE07100, BAE07099, BAE07098, BAE07097, BAE07096, BAE07095, BAE07094, BAE07093 , BAE07092, BAE07091, BAE07090, BAE07089, BAE07088, BAE07053, BAE07052, BAE07051, BAE07050, BAE07049, BAE07048, BAE07047, BAE07046, BAE07045, BAE07044, BAE07043, BAE07042, BAE07041, BAE07040, BAE07039, BAE07038, BAE07037, BAE07036, BAE07035, BAE07034 , BAE07033, BAE07032, BAE07031, BAE07030, BAE07029, BAE07028, BAE07027, BAE07026, BAE07025, BAE07024, BAE07023, BAE07022, BAE07021, BAE07020, BAE07019, BAE07018, BAE07017, BAE07016, BAE07015, BAE07014, BAE07013, BAE07012, BAE07011, BAE07010, BAE07009 , BAE07008, BAE07007, BAE07006, BAE07005, BAE07004, BAE07003, BAE07002, BAE07001, BAE07000, BAE06999, BAE06998, BAE06997, BAE06996, BAE06995, BAE06994, BAE06993, BAE06992, BAE06991, BAE06990, BAE06989, BAE06988, BAE06987, BAE06986, BAE06985, BAE06984 , BAE06983, BAE06982, BAE06981, BAE06980, BAE06979, BAE06978, BAE06977, BAE06976, BAE06975, BAE06974, BAE06973, BAE06972, BAE06971, BAE06970, BAE06969, BAE06968, BAE06967, BAE06966, BAE06965, BAE06964, BAE06963, BAE06962, BAE06961, BAE06960, BAE06959 , BAE06958, BAE06957, BAE06956, BAE06955, BAE06954, BAE06953, BAE06952, BAE06951, BAE06950, BAE06949, BAE06948, BAE06947, BAE06946, BAE06945, BAE06944, BAE06943, BAE06942, BAE06941, BAE06940, BAE06939, BAE06938, BAE06937, BAE06936, BAE06935, BAE06934 , BAE06933, BAE06932, BAE06931, BAE06930, BAE06929, BAE06928, BAE06927, BAE06926, BAE06925, BAE06924, BAE06923, BAE06922, BAE06921, BAE06920, BAE06919, BAE06918, BAE06917, BAE06916, BAE06915, BAE06914, BAE06913, BAE06912, BAE06911, BAE06910, BAE06909 , BAE06908, BAE06907, BAE06906, BAE06905, BAE06904, BAE06903, BAE06902, BAE06901, BAE06900, BAE06899, BAE06898, BAE06897, BAE06896, BAE06895, BAE06894, BAE06893, BAE06892, BAE06891, BAE06890, BAE06889, BAE06888, BAE06887, BAE06886, BAE06885, BAE06884 , BAE06883, BAE06882, BAE06881, BAE06880, BAE06879, BAE06878, BAE06877, BAE06876, BAE06875, BAE06874, BAE06873, BAE06872, BAE06871, BAE06870, BAE06869, BAE06868, BAE06867, BAE06866, BAE06865, BAE06864, BAE06863, BAE06862, BAE06861, BAE06860, BAE06859 , BAE06858, BAE06857, BAE06856, BAE06855, BAE06854, BAE06853 and BAE06852).
The N-terminal fragment of PHA synthase protein (approximately amino acid/11-200 or 1-150 or 1-100) alterable height, and lack in some instances or replace with enzyme, antibody binding domain or another fusion partner, and can not make the synthase inactivation or hinder synthase, via polymer particles, in conjunction with territory (being the C-terminal fragment), with the polymer core covalency, be not connected.The polymer particles of synthase comprises the synthase protein catalytic domain of mediation polymer core polymerization and polymer particles formation at least in conjunction with territory.
In certain embodiments, the C-terminal fragment of PHA synthase protein is modified, excalation or part replace with enzyme, antibody binding domain or another fusion partner, and can not make the synthase inactivation or hinder synthase, with the polymer particles covalency, is not connected.
In some cases, enzyme, antibody binding domain or another fusion partner merge to the N-end of PHA synthase protein and/or C-end, and can not make the synthase inactivation or hinder synthase, with the polymer particles covalency, are not connected.Similarly, in other cases, enzyme, antibody binding domain or another fusion partner insert in the PHA synthase protein, perhaps in fact are positioned at particulate and form among albumen.PhaC merges example known in the art and in presenting herein.
In a specific examples, the N-terminal fragment of PHA synthase protein (approximately amino acid/11-200 or 1-150 or 1-100) lacks or replaces with antibody binding domain for example Z territory or the identical linking repetition of albumin A, and can not make the synthase inactivation or hinder synthase, with the covalency of polymer particles, is not connected.
" polymkeric substance depolymerizing enzyme " refers to and existing polymkeric substance (for example being found in the polymkeric substance in polymer particles) can be hydrolyzed into the albumen of water-soluble monomer and oligopolymer as used herein.the example of polymkeric substance depolymerizing enzyme is present among extensively multiple PHA bacterium for degrading and fungi, and comprise PhaZ1-PhaZ7 extracellular depolymerizing enzyme from Paucimonas lemoignei, from acidovorax facilis (Acidovorax sp.), Alcaligenes faecalis (A.faecalis) (AE122 and T1 bacterial strain), eat (Delftia(Comamonas) acidovorans of sour Dai Erfute bacterium (comamonas)) bacterial strain YM1069, Comamonas testosteroni (Comamonas testosteroni), comamonas (Comamonas sp.), leptothrix falciformis (Leptothrix sp.) bacterial strain HS, pseudomonas (Pseudomonas sp.) bacterial strain GM101(preserving number AF293347), Pseudomonas fluorescens (P.fluorescens) bacterial strain GK13, pseudomonas stanieri (P.stutzeri), Pi Shi Lei Er Salmonella (R.pickettii) (A1 and K1 bacterial strain, preserving number JO4223, D25315), the PhaZ depolymerizing enzyme of disleave streptomycete (S.exfoliates K10) and streptomyces hygroscopicus (Streptomyces hygroscopicus) is (referring to Jendrossek D., and Handrick, R., Microbial Degredation of Polyhydroxyalkanoates, Annual Review of Microbiology, 2002, 56:403-32).
Term " polypeptide " comprises the amino acid chain of any length as used herein, but preferred at least 5 amino acid comprise full-length proteins, and wherein amino-acid residue connects by the covalency peptide bond.Polypeptide of the present invention is the natural product of purifying, perhaps partially or completely utilizes restructuring or synthetic technology preparation.This term can refer to polypeptide, polypeptide aggregation style such as dimer or other polymers, fusion polypeptide, polypeptide variants, or derivatives thereof.
Term " promotor " refers to and is positioned at the non-transcribed cis-regulating element that the upstream of coding region regulatory gene is transcribed.Promotor comprises the initial sub-element of the cis of specifying transcription initiation site, conservative box for example TATA box and the motif by the transcription factor combination.
Term " terminator " refers to and stops the sequence of transcribing, and it sees the 3' untranslated end of translation sequences downstream gene.Terminator is the important determinative of mRNA stability, and finds to have the space adjusting function in some cases.
When statement was bonded to or is absorbed into or integrates with polymer particles, term " material " was intended to represent that the material by the fusion partner combination maybe can be absorbed into or integrate with the material of polymer particles.
Term " variant " refers to polynucleotide or the peptide sequence different from the specific identification sequence as used herein, and wherein one or more Nucleotide or amino-acid residue are lacked, replace or add.Variant is the variant that naturally occurring allele variant or non-natural exist.Variant is from identical or other species, and can comprise homologue, paralog thing and ortholog thing.In certain embodiments, polynucleotide and polypeptide variants have and wild-type polynucleotide or the same or analogous biologic activity of polypeptide.The term " variant " of addressing polynucleotide and polypeptide comprises polynucleotide and the polypeptide of form of ownership as herein defined.
Polynucleotide and polypeptide variants
Term " polynucleotide " represents strand or double-stranded DNA Nucleotide or the ribonucleoside acid polymer of any length as used herein, but preferred at least 15 Nucleotide, and as limiting examples, comprise genes encoding and non-coding sequence, sense and antisense complementary sequence, exon, intron, genomic dna, cDNA, premessenger RNA, mRNA, rRNA, siRNA, miRNA, tRNA, ribozyme, recombinant polypeptide, that separate and naturally occurring DNA purifying or RNA sequence, synthetic RNA and DNA sequence dna, nucleic acid probe, primer and fragment.Many nucleic acid analogs are known in the art and also expect.
The polynucleotide sequence that this paper provides " fragment " is the subsequence of continuous nucleotide, preferably grows to few 15 Nucleotide.Fragment of the present invention preferably comprises at least 20 Nucleotide of polynucleotide of the present invention, more preferably at least 30 Nucleotide, more preferably at least 40 Nucleotide, more preferably at least 50 Nucleotide and most preferably at least 60 continuous nucleotides.The polynucleotide sequence fragment can be used in antisense, gene silencing, triple helical or ribozyme technology, or as primer, probe, be incorporated among microarray or be used for the system of selection of polynucleotide base.
While addressing the promotor polynucleotide sequence, term " fragment " is intended to comprise such sequence, and it comprises cis element and is connected the promotor polynucleotide sequence zone that polynucleotide sequence that this fragment effectively connects with it expresses.
Preferred promotor polynucleotide sequence fragment of the present invention comprises at least 20 of promotor polynucleotide of the present invention, more preferably at least 30, more preferably at least 40, more preferably at least 50, more preferably at least 100, more preferably at least 200, more preferably at least 300, more preferably at least 400, more preferably at least 500, more preferably at least 600, more preferably at least 700, more preferably at least 800, more preferably at least 900 and at least 1000 continuous nucleotides most preferably.
Term " primer " refers to short polynucleotide, usually has free 3 ' O Η group, and it is hybridized to template and for the polynucleotide polyreaction of initiation with this template complementation.This primer preferably grows to few 5, and more preferably at least 6, more preferably at least 7, more preferably at least 9, more preferably at least 10, more preferably at least 11, more preferably at least 12, more preferably at least 13, more preferably at least 14, more preferably at least 15, more preferably at least 16, more preferably at least 17, more preferably at least 18, more preferably at least 19, more preferably at least 20 Nucleotide.
Term " probe " refers to short polynucleotide, and it is used at the polynucleotide sequence of hybridization based assays method detection with this probe complementation.Probe can be comprised of polynucleotide " fragment " as herein defined.Preferred this probe grows to few 5, more preferably at least 10, more preferably at least 20, more preferably at least 30, more preferably at least 40, more preferably at least 50, more preferably at least 100, more preferably at least 200, more preferably at least 300, more preferably at least 400 and at least 500 Nucleotide most preferably.
Term " variant " refers to polynucleotide or the peptide sequence different from the specific identification sequence as used herein, and wherein one or more Nucleotide or amino-acid residue are lacked, replace or add.Variant is the variant that naturally occurring allele variant or non-natural exist.Variant is from identical or other species, and can comprise homologue, paralog thing and ortholog thing.In certain embodiments, polynucleotide and polypeptide variants have and wild-type polynucleotide or the same or analogous biologic activity of polypeptide.The term " variant " of addressing polynucleotide and polypeptide comprises polynucleotide and the polypeptide of form of ownership as herein defined.
The polynucleotide variant
the variant polynucleotide sequence preferably presents at least 50% with specifying polynucleotide sequence, more preferably at least 51%, at least 52%, at least 53%, at least 54%, at least 55%, at least 56%, at least 57%, at least 58%, at least 59%, at least 60%, at least 61%, at least 62%, at least 63%, at least 64%, at least 65%, at least 66%, at least 67%, at least 68%, at least 69%, at least 70%, at least 71%, at least 72%, at least 73%, at least 74%, at least 75%, at least 76%, at least %, at least 77%, at least 78%, at least 79%, at least 80%, at least 81%, at least 82%, at least 83%, at least 84%, at least 85%, at least 86%, at least 87%, at least 88%, at least 89%, at least 90%, at least 91%, at least 92%, at least 93%, at least 94%, at least 95%, at least 96%, at least 97%, at least 98%, or at least 99% identity.Just specify comparison window or the total length of at least 20 nucleotide positions of polynucleotide sequence, preferred at least 50 nucleotide positions, at least 100 nucleotide positions to find identity.
Polynucleotide sequence identity can be come to determine in the following manner.Utilization can be by NCBI(Ftp: //ftp.ncbi.nih.gov/blast/) BLASTN(of acquisition is disclosed from the blast program cover, 2.2.10 version [in October, 2004]) by bl2seq(Tatiana A.Tatusova, Thomas L.Madden (1999), " Blast2sequences-a new tool for comparing protein and nucleotide sequences ", FEMS Microbiol Lett.174:247-250) herbicide-tolerant polynucleotide sequence and candidate's polynucleotide sequence are compared.Use the default parameters of bl2seq, but should close the filtration to the low complex degree part.
Can utilize following unix command line parameter to check the identity of polynucleotide sequence:
Bl2seq-i nucleotideseq1-j nucleotideseq2-F F-p blastn
Parameter-F F closes the filtration to the low complex degree section.Parameter-p is that sequence is to selecting suitable algorithm.The bl2seq program provides the report of sequence identity at " Identities=" capable number with regard to identical Nucleotide and per-cent.
The identity of polynucleotide sequence also can utilize global sequence comparison program (for example Needleman, S.B.and Wunsch, C.D. (1970) J.Mol.Biol.48,443-453) just the total length of candidate and herbicide-tolerant polynucleotide sequence lap calculate.The complete execution of Needleman-Wunsch global sequence alignment algorithm is seen and can be wrapped (Rice by the EMBOSS that http://www.hgmp.mrc.ac.uk/Software/EMBOSS/ obtains, P.Longden, I.and Bleasby, A.EMBOSS:The European Molecular Biology Open Software Suite, Trends in Genetics June2000, vol16, No6.pp.276-277) in the needle program.Europe bioinformation institute (European Bioinformatics Institute) server also provides in http:/www.ebi.ac.uk/emboss/align/ the EMBOSS-needle overall comparison instrument of carrying out between two sequences online.
Perhaps can utilize the GAP program, it calculates the best overall comparison of two sequences and can not carry out point penalty to the end breach.GAP is described in Publication about Document: Huang, X. (1994) On Global Sequence Alignment.Computer Applications in the Biosciences10,227-235.
Polynucleotide variant of the present invention also comprises the sequence that presents similarity with one or more specific identification sequences, and it has probably kept the identical functions of those sequences, and this can not rational expectation can occur at random.With regard to polypeptide, this sequence similarity utilization can openly obtain from NCBI(Ftp: //ftp.ncbi.nih.gov/blast/) the bl2seq program of blast program cover (2.2.10 version [in October, 2004]) measure.
Can utilize following unix command line parameter to check the similarity of polynucleotide sequence:
Bl2seq-i nucleotideseq1-j nucleotideseq2-F F-p tblastx
Parameter-F F closes the filtration to the low complex degree section.Parameter-p is that sequence is to selecting suitable algorithm.Similarity zone between this program looks sequence, and with regard to each such zone, provide " E value " report, it accidentally sees the anticipated number of this type of coupling for expection in the database that contains stochastic sequence in fixing reference size.The size of database is by bl2seq program default setting.For being far smaller than 1 little E value, this E value approximates the probability of this type of random fit.
The variant polynucleotide sequence is preferably compared and is presented less than 1x10 with arbitrary specific identification sequence-10, be more preferably less than 1x10-20, less than 1x10-30, less than 1x10-40, less than 1x10-50, less than 1x10-60, less than 1x10-70, less than 1x10-80, less than 1x10-90, less than 1x10-100, less than 1x10-110, less than 1x10-120Or less than 1x10-123The E value.
Perhaps, the polynucleotide sequence of variant polynucleotide of the present invention and appointment or its complement are hybridized under rigorous condition.
Term " hybridizing under rigorous condition " and grammer equivalents thereof refer to polynucleotide molecule is hybridized with herbicide-tolerant polynucleotide molecule (the herbicide-tolerant polynucleotide molecule of for example fixing on DNA or RNA trace such as Southern trace or Northern trace) under the temperature that limits and salt concentration conditions ability.Can measure by hybridize, then improve at first preciseness to the preciseness of expectation under low rigorous condition in the ability of hybridizing under rigorous hybridization conditions.
With regard to length greater than with regard to the polynucleotide molecule of about 100 bases, typical rigorous hybridization conditions is no more than 25-30 ℃ (for example 10 ℃) (in general manner referring to Sambrook et al. than the temperature of fusion of natural duplex (Tm) is low, Eds, 1987, Molecular Cloning, A Laboratory Manual, 2nd Ed.Cold Spring Harbor Press; Ausubel et al., 1987, Current Protocols in Molecular Biology, Greene Publishing).Greater than the about polynucleotide molecule of 100 bases Tm can (G+C-log (Na+) calculates (Sambrook et al. according to formula Tm=81.5+0.41%, Eds, 1987, Molecular Cloning, A Laboratory Manual, 2nd Ed.Cold Spring Harbor Press; Bolton and McCarthy, 1962, PNAS84:1390).Length is such hybridization conditions greater than the typical rigorous condition of the polynucleotide of 100 bases, for example with 6X SSC, and the prewashing of 0.2%SDS solution; 65 ℃, 6X SSC, the 0.2%SDS hybridization of spending the night; Then in 65 ℃ with 1X SSC, the 0.1%SDS washed twice, each 30 minutes, and in 65 ℃ with 0.2X SSC, 0.1%SDS washed twice, each 30 minutes.
Less than with regard to the polynucleotide molecule of 100 bases, exemplary rigorous hybridization conditions is than the low 5-10 ℃ of Tm with regard to length.On average, length reduces approximately (500/ oligonucleotide length) ℃ less than the Tm of the polynucleotide molecule of 100bp.
Just be known as DNA analog (Nielsen et al., the Science.1991Dec6 of peptide nucleic acid(PNA) (PNA); 254 (5037): 1497-500), the Tm value is higher than the Tm value of DNA-DNA or DNA-RNA heterozygote, and can utilize Giesen et al., Nucleic Acids Res.1998Nov1; 26 (21): the formula described in 5004-6 calculates.Length less than the exemplary rigorous hybridization conditions of the DNA-PNA heterozygote of 100 bases than the low 5-10 ℃ of Tm.
Variant polynucleotide of the present invention also comprise such polynucleotide, and they are different from sequence of the present invention, but due to the degeneracy of genetic codon, and the coded polypeptide of the polypeptide of its coding and polynucleotide of the present invention has similar activity.The sequence variations that does not change polypeptid acid sequence is " silent variant ".Except the ATG(methionine(Met)) and the TGG(tryptophane), in some instances, by this area approval technology, change same amino acid whose other codon, for example with optimizing codon in the specific host organism, express.
The present invention also comprises the polynucleotide sequence variations that causes conservative replacement of one or several amino acid in coded peptide sequence and significantly do not change its biologic activity.The technician can understand the method (referring to for example Bowie et al., 1990, Science247,1306) of carrying out the replacement of phenotype silent amino acid.
Due in silent variant and coded peptide sequence conservative replace the variant polynucleotide that cause can utilize as previously mentioned can openly obtain from NCBI(Ftp: //ttp.ncbi.nih.gov/blast/) blast program cover (2.2.10 version [in October, 2004]) in the bl2seq program measure by the tblastx algorithm.
Polypeptide variants
That term with regard to polypeptide " variant " comprises is naturally occurring, the polypeptide of restructuring and synthetic preparation.variant polypeptide sequence preference and sequence of the present invention present at least 50%, more preferably at least 51%, at least 52%, at least 53%, at least 54%, at least 55%, at least 56%, at least 57%, at least 58%, at least 59%, at least 60%, at least 61%, at least 62%, at least 63%, at least 64%, at least 65%, at least 66%, at least 67%, at least 68%, at least 69%, at least 70%, at least 71%, at least 72%, at least 73%, at least 74%, at least 75%, at least 76%, at least %, at least 77%, at least 78%, at least 79%, at least 80%, at least 81%, at least 82%, at least 83%, at least 84%, at least 85%, at least 86%, at least 87%, at least 88%, at least 89%, at least 90%, at least 91%, at least 92%, at least 93%, at least 94%, at least 95%, at least 96%, at least 97%, at least 98% or at least 99% identity.With regard to the comparison window of at least 20 amino acid positions of polypeptide of the present invention, preferred at least 50 amino acid positions, at least 100 amino acid positions or with regard to total length, find identity.
Peptide sequence identity can be measured in the following manner.Utilization can be by NCBI(Ftp: //ftp.ncbi.nih.gov/blast/) the open BLASTP(that obtains is from the blast program cover, 2.2.10 version [in October, 2004]) by bl2seq, target polypeptides sequence and candidate's peptide sequence are compared.Use the default parameters of bl2seq, but should close the filtration to the low complex degree zone.
Peptide sequence identity also can utilize global sequence's comparison program to calculate with regard to the total length of candidate and herbicide-tolerant polynucleotide sequence lap.EMBOSS-needle(can be available from http:/www.ebi.ac.uk/emboss/align/ as discussed above) and GAP(Huang, X. (1994) On Global Sequence Alignment.Computer Applications in the Biosciences10,227-235) be also suitable global sequence's comparison program of calculating peptide sequence identity.
Polypeptide variants of the present invention also comprises the sequence that presents similarity with one or more specific identification sequences, and it has probably kept the identical functions of those sequences and this can not rational expectation can occur at random.With regard to polypeptide, this sequence similarity can utilize can openly obtain from NCBI(Ftp: //ftp.ncbi.nih.gov/blast/) blast program cover (2.2.10 version [in October, 2004]) in the bl2seq program measure.Can utilize following unix command line parameter to check the similarity of peptide sequence:
Bl2seq-i peptideseq1-j peptideseq2-F F-p blastp
When with arbitrary specific identification sequence, comparing, the variant polypeptide sequence preference presents less than 1x10-10, be more preferably less than 1x10-20, less than 1x10-30, less than 1x10-40, less than 1x10-50, less than 1x10-60, less than 1x10-70, less than 1x10-80, less than 1x10-90, less than 1x10-100, less than 1x10-110, less than 1x10-120Or less than 1x10-123The E value.
Parameter-F F closes the filtration to the low complex degree section.Parameter-p is that sequence is to selecting suitable algorithm.Similarity zone between this program looks sequence, and with regard to each such zone, provide " E value " report, it accidentally sees the anticipated number of this type of coupling for expection in the database that contains stochastic sequence in fixing reference size.For being far smaller than 1 little E value, this E value approximates the probability of this type of random fit.
The present invention also comprises the conservative replacement of one or several amino acid that does not significantly change its biologic activity in described peptide sequence.The technician can understand the method (referring to for example Bowie et al., 1990, Science247,1306) of the aminoacid replacement that carries out the phenotype silence.
The nucleic acid that polypeptide variants of the present invention also comprises by coded polypeptide produces but the polypeptide different from wild type peptide, and this is because processing is different so that it has altered aminoacid sequence.For example, by the alternative splice mode of elementary rna transcription thing and the different variants that produce of generation wild type peptide.
Term " carrier " refers to polynucleotide molecule, is generally double-stranded DNA, and it is in order to be transported to genetic constructs in host cell.In some instances, carrier can, at least one other host system, for example copy in intestinal bacteria (E.coli).
Tangential flow filtration
Usually, the present invention finds to be applied to the tangential flow filtration technology.For example, in one embodiment, the present invention relates to a kind of for prepared the method for one or more target substances by source liquid, the method comprises: in the tangential flow filtration system or before adding the tangential flow filtration system, source liquid is contacted with the biological polymer Particle Swarm, wherein carries out one or more following steps:
The concentrated polymer Particle Swarm,
Separate one or more pollutents from target substance or its polymer particles of one or more polymer particles combinations in conjunction with precursor, for example by diafiltration,
From polymer particles wash-out target substance;
With the recovery target substance.
In the embodiment of the target substance precursor that relates to the particulate combination, one or more polymer particles comprise one or more enzymes that can catalyged precursor is converted into target substance or is converted into further target substance precursor.For example, in one embodiment, the target substance precursor is for can catalytic substrate being converted into enzyme substrates and one or more polymer particles that comprises enzyme of target substance.In another example, the target substance precursor comprises the polymer particles of first enzyme, second enzyme or first enzyme and second enzyme for the enzyme substrates that can catalytic substrate be converted into further target substance precursor (himself for can the further precursor conversion of catalysis be the second enzyme substrate of target substance) and one or more.Be to be understood that:, by one or more polymer particles that comprises the enzyme of suitable selection are provided, can use a series of catalytic steps in the conversion of target substance at precursor.
In another embodiment, the present invention relates to a kind of for prepare the method for one or more target substances from source liquid, the method comprises: in the tangential flow filtration system or before adding the tangential flow filtration system, source liquid is contacted with the biological polymer Particle Swarm, wherein carries out one or more following steps:
The concentrated polymer Particle Swarm,
From one or more target substances of separated from contaminants or its precursor of one or more polymer particles combinations, for example by diafiltration,
With the recovery target substance.
In one embodiment, source liquid carries out with contacting by circulating biological polymer particles in the tangential flow filtration system and source liquid of biological polymer Particle Swarm.
In another embodiment, the present invention relates to a kind of for prepare the method for one or more target substances from source liquid, the method comprises to the tangential flow filtration system and adds and comprise biological polymer Particle Swarm and one or more target substances of choosing wantonly or the source liquid of its precursor and/or one or more pollutents, with the concentrated polymer Particle Swarm, and/or from polymer particles, separate one or more target substances or its precursor and/or one or more pollutents, and reclaim polymer particles, target substance or pollutent.
The present composition, method and polymer particles are applied with existing tangential flow system and technical tie-up.There is this a large amount of systems.In the tangential flow filtration system, by the liquid medium shearing force that puts on the filter element outside that flows, trend towards stoping buildup of solids on the filter element surface.
Tangential flow filter comprises micro-filtration, ultrafiltration, nanofiltration and reverse osmosis filter system.In an exemplary, tangential flow filter comprises the multiple filter paper (filtering membrane) of arranging with effective multilayered structure, for example, wherein filter paper and penetrant and retentate paper are used alternatingly, and when liquid to be filtered flows through filter paper, do not permeate material in the past, for example solid or diameter are retained and enter retentate stream greater than the high molecular weight material in filter paper aperture, and liquid is gone forward side by side into the infiltration logistics along with infiltration material in the past passes the filter paper diffusion.
, as understanding ground, can use at present many tangential flow technology (also referred to as lateral flow technology) and be applicable to unite use with the present invention.Commercially available tangential flow technology (comprising the tangential flow film filter), comprise, for example, and from the Vivaflow strainer (for example comprising Vivaflow200,100,000MWCO, PES, VivaScience) of Vivascience, from Sartorius'sWith polyether sulfone micro-filtration and ultra-filtration membrane, and the filter of suitable tangential flow filter module and the type differently is described in U.S.Pat.No.4, and 867,876; U.S.Pat.No.4,882,050; U.S.Pat.No.5,034,124; U.S.Pat.No.5,034,124; U.S.Pat.No.5,049,268; U.S.Pat.No.5,232,589; U.S.Pat.No.5,342,517; U.S.Pat.No.5,593,580; U.S.Pat.No.5,868,930; With publication number beWOPCT International Application Serial No. PCT/US10/027266 of/2010/107677; Its whole disclosures by reference with its separately integral body incorporate this paper into.
The general overview that is applicable to exemplary tangential flow process of the present invention is shown in Fig. 1-4.Tangential flow filtration (TFF) or cross flow filter (this paper is used interchangeably) are that a kind of filtration is by being parallel to the process (Figure 1A) of filtration medium surface flow solution or suspension flow path implement.Exemplary, simple TFF system utilizes fresh feed pump to pass TFF film cylinder and recirculation (Figure 1B) with penetrant in the permission system from feed storage tank.Little compound and solution pass strainer as penetrant.Large compound in retentate can be concentrated by this way.By adding extra solution storage tank, retentate can be by filtering (diafiltration) dialysis.Diafiltration in certain embodiments is therefore as the process (molecule suspension, cell, solid) from less compound separation large compound.Be in for example so-called micro-filtration of application of the TF strainer of 0.1-0.6 μ m of sub-micro scope.For general approach shown in Figure 2, as needed in purifying subsequently, source liquid is pretreated (for example, to remove particulate or solid matter (for example by centrifugal or filtering technique known in the art)), concentrated or dilution optionally.Then make source liquid contact for some time with the biological polymer Particle Swarm to form particulate: the target mixture.
Usually, make source liquid contact for some time with the biological polymer particulate to be enough to cause the combination of target and the required ratio of biological polymer particulate.The mixing of source liquid and biological polymer particulate for example will be conducive to usually guarantee that by stirring or pass the processing of tangential flow filtration system the best of target contacts and combination.
Particulate: the target mixture passes the circulation of tangential flow filtration system, therefore and pass tangential flow filter, wherein (a) mixture be concentrated, the relative diafiltration liquid of (b) mixture (usually select with from particulate: the target mixture separates the pollutent of nonspecific combination) and by diafiltration, (c) from particulate wash-out target substance (usually by with the second diafiltration liquid diafiltration with separating particles: the target substance mixture), (d) target substance subsequently from the biological polymer separation of particles (for example, target substance is gone out by diafiltration), thereby to reclaim the target substance of purifying.Target substance is optionally further processed by (e), for example by concentrated.
In another exemplary that Fig. 3 describes, source liquid comprises the target substance precursor, and for example, one or more enzyme substratess, its product are required target substance.In this embodiment, the source liquid that comprises precursor substance contacts with the biological polymer particulate that one or more comprise one or more enzymes, and described endonuclease capable catalyged precursor is converted into target substance.As mentioned above, source liquid contacts for some time to be enough to form mixture with the biological polymer particulate, be particulate in this case: enzyme-substrate complex.Source liquid and biological polymer particle mixture are kept for some time to be enough to the making precursor of required ratio can be combined with the biological polymer particulate and make precursor molecule can be converted into target substance.
Fig. 4 has shown the general approach that uses the inventive method purification of target material, and wherein the biological polymer particulate is in order to by removing one or more enriching pollutants target substances.In this case, source liquid can contact in conjunction with one or more polymer particles groups that are present in the pollutent in the liquid of source with one or more.At this moment, particulate: the formation of pollutent mixture allows the diafiltration target substance, and described target substance can be further processed (for example comprise, via one or more tangential flow methods of the present invention) as described herein subsequently.Diafiltration (usually using the second diafiltration liquid) allows separating particles: the pollutent mixture, wherein the biological polymer particulate can be recycled in order to further use.
Correspondingly, those skilled in the art will recognize that a plurality of embodiment of the present invention (comprising above those representative example of summarizing) considered in the retentate or in penetrant required target substance, from the wash-out of tangential flow filtration system, depend on concrete structure or the concrete group of polymer particles used.
Source material
The present invention relates to prepare target substance from source material." source material " refers to and is generally containing of liquid at least a material and usually contain the material of more than one materials as used herein, it typically is biological agents or for attempting from other extracting substances of being present in this source material or the valuable product of purifying.Usually, source material can be for example aqueous solution, organic solvent system or water-based/ORGANIC SOLVENT MIXTURES or solution.Source material is often for containing complex mixture or the solution of many biological molecule such as albumen, antibody, hormone and virus and small molecules such as salt, sugar, lipid etc.Although typical biogenesis source material can be used as aqueous solution or suspension is initial, it also can contain early separating step organic solvent used, described early separating step such as solvent deposition, extraction etc.The source examples of liquids that can contain valuable biological agents, is applicable to purification process of the present invention comprises, but be not limited to, from culture supernatants, homogeneous cell suspending liquid, blood plasma, plasma component and the diary processing of bio-reactor, for example flow for example cheese whey of milk, colostrum and whey.
In a plurality of embodiments, source material comprises one or more and is selected from the liquid of serum, blood plasma, plasma component, whole blood, milk, colostrum, whey, enchylema, tissue culture medium, plant cell liquor, vegetable cell homogenate and tissue homogenate.For example, source material is plant milk extract, for example fruit juice or vegetables juice.What expect especially is fermented product,, as culture or culture supernatants, particularly expresses those cultures of one or more recombinant proteins, for example one or more monoclonal antibodies.
In other embodiments, source material comprises culture supernatants, and for example from bio-reactor, it comprises polymer particles of the present invention.Those skilled in the art will recognize that this source material comprises other biological agents of significant quantity, it can be the pollutent of considering under some environment.For example, in an exemplary, source material is the cellular preparations that culture supernatants or comprise prepares the bacterium of polymer particles of the present invention.In embodiment of other special expection, source material is culture supernatants or from the cellular preparations of the cell of the cell of preparation polymer particles of the present invention and one or more target substances of preparation or its precursor.In certain embodiments, source material is culture supernatants or comprises preparation polymer particles of the present invention and the cellular preparations of the cell mass of one or more target substances or its precursor.
Target substance
As above, the present invention relates to from source material, comprise that the source material that comprises the target substance precursor prepares target substance.Term " target substance " refers to one or more required products from the preparation of source liquid or purifying as used herein.Target substance is generally valuable biological products, for example, and immunoglobulin (Ig), thrombin, vaccine, antigen, antibody, selected albumen or glycoprotein, peptide, enzyme, metabolite etc.
In different embodiments, target substance is selected from vaccine, thrombin, immunoglobulin (Ig), antigen, antibody, albumen, glycoprotein, peptide, sugar, carbohydrate and enzyme.
In different embodiments, one or more affinity ligands are in conjunction with at least a target species, and described target species are selected from albumen, nucleic acid, virus, sugar, carbohydrate, immunoglobulin (Ig), thrombin, glycoprotein, peptide, antibody, antigen, hormone or polynucleotide.
Yet the present invention finds to be applied to except the preparation that usually is considered to " biological " the plurality of target material those, as being identified for the multi-functional group that can be combined with polymer particles described herein by understanding.For example, polymer particles available metal of the present invention or metal ion conjugated group, for example metal or metal ion coordination polypeptide carry out functionalization expediently, for example by the polymkeric substance synthase: the expression of melts combine polypeptide fusion polypeptide.In fact, one or more protein functions fusion to polymer formation albumen that comprise polymer particles or the protein-bonded ability of polymkeric substance are allowed to be applied to the very preparation of broad range target substance.
The fusion polypeptide that comprises biological polymer particulate of the present invention can prepare with biotechnology known in the art expediently, comprises and uses one or more expression construct.To recognize in certain embodiments, the fusion polypeptide that comprises biological polymer particulate of the present invention is the desired target substance of this paper itself.
Expression construct
Prepare and utilize expression construct to express the method for fusion polypeptide in microorganism, vegetable cell or zooblast (cell expression system) or in Cell free expression system, and the host cell that comprises the expression construct that is used to form the present invention's polymer particles used be known in the art (for example, Sambrook et al., 1987; Ausubel et al., 1987).
In one embodiment, the expression construct that is used for the inventive method is inserted into replicable vector and is used for the clone or expresses, or in another embodiment, is incorporated in host genome.Variety carrier can openly obtain.Carrier is for example the form of plasmid, clay, virus particle or phage.Suitable nucleotide sequence can be inserted in carrier by multiple programs.Usually, utilize technology known in the art that DNA is inserted into suitable restriction endonuclease site.Carrier component generally comprises but is not limited to: but one or more signal sequence, replication origin, one or more selectable marker gene, enhancer element, promotor and transcription termination sequence.The structure that contains the appropriate carrier of one or more these components adopts standard interconnection technique known in the art.
The cloning and expression carrier all contains carrier can be copied in the host cell of one or more selections nucleotide sequence.For various bacteria, yeast and virus, this type of sequence is known.
In one embodiment, expression construct is present among the high copy number carrier.
In one embodiment, the high copy number carrier is selected from those carriers that exists with 20-3000 copy in each host cell.
In one embodiment, the high copy number carrier contains high copy number replication origin (ori), for example the derivative replication origin of ColE1 or ColE1.For example, the derivative replication origin of ColE-1 can comprise the pUC19 replication origin.
Numerous high copy number replication origins that are applicable to carrier of the present invention are conventionally known to one of skill in the art.These comprise derivative replication origin and other high copy number replication origin, for example M13FR ori or p15A ori from the ColE1 of pBR322 and derivative thereof.2 μ plasmid initial points are applicable to yeast, and Various Diseases toxogen point (SV40, polyomavirus, adenovirus, VSV or BPV) is used for the cloning vector of mammalian cell.
Preferably, the high copy number replication origin comprises the derivative pUC19 replication origin of ColE1.
Restriction site is positioned among replication origin, thereby Insert Fragment is cloned into this restriction site, can make this initial point inactivation, makes it to instruct carrier to copy.Perhaps, within least one restriction site is positioned at this initial point, thereby being cloned into this restriction site, Insert Fragment can make it only can to copy with low copy number or single copy number by supporting carrier.
The cloning and expression carrier will typically contain Select gene, but also become selective marker, to detect existing of this carrier in the host cell transformed.Typical Select gene coding (a) is given microbiotic or other toxin, for example, the albumen of penicillin, Liu Suanyan NEOMYCIN SULPHATE, methotrexate or tetracyclin resistance, (b) albumen of extra-nutrition defective type, or (c) albumen of the supply crucial nutrient that can not obtain from complex media, for example, be the gene of bacillus (Bacilli) encoding D-alanine racemase.
But the selective marker that is usually used in Plant Transformation comprises the neomycin phosphotransferase II gene (NPT II) of giving kalamycin resistance; Give the aadA gene of spectinomycin and streptomycin resistance; Be used for Ignite(AgrEvo) and the Basta(Hoechst) phosphinothricin acetyl transferase of resistance (bar gene); With the hygromycin phosphotransferase gene (hpt) that is used for hygromycin resistance.
But the example that is used for the suitable selective marker of mammalian cell is those marks that can identify the cell of the absorption expression construct of having the ability, for example DHFR or thymidine kinase.While adopting wild-type DHFR, suitable host cell is as Urlaub et al., 1980 described preparations and the active defective type Chinese hamster ovary celI of the DHFR that goes down to posterity system.The suitable Select gene that is used for yeast is trp1 gene (Stinchcomb et al., 1979 that are present in yeast plasmid YRp7; Kingsman et al., 1979; Tschemper et al., 1980).For example ATCC No.44076 or PEP4-1 provide selective marker [Jones, Genetics, 85:12 (1977)] to the trp1 gene for the yeast mutant that lacks energy for growth in tryptophane.
The expression construct that is used to form polymer particles preferably includes promotor, and it controls the expression of nucleic acid of at least one coding polymkeric substance synthase, particulate formation albumen or fusion polypeptide.
The promotor that multiple potential host cell is identified is known.The promotor that is applicable to prokaryotic hosts comprises β-lactamase and Lac operon system (Chang et al., 1978; Goeddel et al., 1979), alkaline phosphatase, tryptophane (trp) promoter systems (Goeddel, Nucleic Acids Res., 8:4057 (1980); EP36,776) and hybrid promoter tac promotor (deBoer et al., 1983) for example.The promotor that is used for bacterial system also can contain Shine-Dalgarno(S.D.) sequence, it effectively is connected to the nucleic acid of coding polymkeric substance synthase, particulate formation albumen or fusion polypeptide.
The example that is used for the suitable promoter sequence of yeast host comprises glycerol 3-phosphate acid kinase (Hitzemanet al., 1980) or other glycolytic ferment (Hess et al., 1968; Holland, 1978) promotor, for example Hydratase, phosphoenolpyruvate, glyceraldehyde-3-phosphate dehydrogenase, hexokinase, pyruvic carboxylase, phosphofructokinase, GPI, 3-phoshoglyceric acid mutase, pyruvate kinase, triosephosphate isomerase, glucose phosphate isomerase and glucokinase.
Other is to have the promoter region that the Yeast promoter of controlling the inducible promoter of the additional advantage of transcribing by growth conditions is the enzyme ofalcoholdehydrogenase 2, different cell pigment C, acid phosphatase, degrading enzyme, metallothionein(MT), glyceraldehyde-3-phosphate dehydrogenase and responsible maltose and the galactose utilization relevant to nitrogen metabolism.
The suitable promotor example that is used for plant host cell, the tissue that comprises unifacial leaf or dicotyledons or organ comprises cell, tissue and organ specific promoters, the cell cycle specific promotor, instantaneous starting, inducible promoter, activated constitutive promoter in the most plants tissue, and recombinant promoter.The selection of promotor will be depended on the spatial-temporal expression of desired clone's polynucleotide.Promotor be from host cell those or be the promotor derived from the gene of other plant, virus and plant pathogenic bacterium and fungi.Those skilled in the art need not overlabor, just can select to be applicable to modify and regulate the promotor of the expression construct of using the genetic constructs that comprises polynucleotide sequence of the present invention.The example of constitutive plant promoters comprises CaMV35S promotor, nopaline synthase promoter and octopine synthase promoter and from the Ubi1 promotor of corn.Have in particular organization that activity, response are inner grows signal or outside abiotic or biological plant promoter of coercing is described in the scientific research document.Exemplary promotor for example is described in WO02/00894, and it incorporates this paper by reference into.
the example that is used for the suitable promotor of mammalian host cell comprises available from virus (polyomavirus for example, fowlpox virus, adenovirus (for example 2 type adenovirus), bovine papilloma virus, avian sarcomata virus, cytomegalovirus, retrovirus, hepatitis B virus and simian virus 40 (SV40)) genome, allos mammalian promoter (for example actin promoter or immunoglobulin promoter), and those of heat-inducible promoter (as long as this type of promotor compatible with host cell systems).
In some instances, by increasing transcribing of expression construct in higher eucaryotic cells in the enhancer sequence insertion vector.Enhanser is the DNA cis-acting elements, common approximately 10-300bp, and it acts on promotor and increases it and transcribes.Present known many enhancer sequence from mammalian genes (globin, elastoser, albumin, α-fetoprotein and Regular Insulin).Yet people will use the enhanser from eukaryotic cell virus usually.Example comprises the sub-enhanser of SV40 enhanser, cytomegalovirus early promoter that is positioned at replication origin downstream (bp100-270), the polyomavirus enhanser that is positioned at the replication origin downstream and adenovirus enhanser.The common montage of enhanser forms albumen or fusion polypeptide encoding sequence 5' or 3' position to polymkeric substance synthase, particulate in carrier, but is preferably placed at the 5' site of promotor.
The expression vector that uses in eukaryotic host cell (yeast, fungi, insect, plant, animal, the mankind or from the karyocyte of other multicellular organism) also can contain and stops transcribing and the necessary sequence of stable mRNA.This type of sequence often comes from the 5' of eucaryon or viral DNA or cDNA and 3' non-translational region once in a while.Contain the Nucleotide section that is transcribed into mRNA non-translational region Polyadenylation section in these zones, described mRNA coding polymkeric substance synthase, particulate form albumen or fusion polypeptide.
In one embodiment, expression construct contains the upstream inducible promoter, the BAD promotor of for example by pectinose, inducing.
In one embodiment, expression construct comprises composing type or regulation type promoter systems.
In one embodiment, the regulation type promoter systems is induction type or checks the type promoter systems.
Although strong promoter is used in expectation in preparing recombinant protein, the regulation and control of these promotors are most important, because the composing type of heterologous protein is crossed, express the decline that causes the speed of growth, plasmid stability and culture viability.
Many promotors interact by repressor albumen and operon (promotor downstream area).Foremost operon is from those of lac manipulator and phage A.The summary of relevant E.coli regulation type promotor is provided in Friehs﹠amp; Reardon, in 1991 table 1.
Standard microbial culture and relate to a Main Differences between the cultivation of recombination bacillus coli (E.coli) and be the separation of growth phase and preparation or induction period.The recombinant protein preparation often utilizes the regulation type promotor, so that (this moment, promotor " was closed " at growth phase, the metabolic burden of host cell is light) realize high-cell density, and realize the preparation of high speed heterologous protein at induction period (" unlatching " promotor after inducing) subsequently.
In one embodiment, the regulation type promoter systems is selected from LacI, Trp, phage γ and phage rna polymerase.
In one embodiment, promoter systems is selected from lac or Ptac promotor and lacI repressor, or trp promotor and rpR repressor.
In one embodiment, the LacI repressor is by adding isopropyl-β-D-thiogalactoside(IPTG) (IPTG) inactivation, thereby IPTG be combined with active repressor and caused from the operon permission expression of dissociating.
In one embodiment, the synthetic medium that the application of trp promoter systems has clear and definite tryptophane concentration, so that this system becomes the auto-induction type when concentration is brought down below threshold level.In one embodiment, add 3-β-indoles-vinylformic acid so that TrpR repressor inactivation.
In one embodiment, promoter systems can utilize phage γ repressor cI.This repressor utilizes the γ prophage and by with two operons that are called OL and OR, interacting and stop the expression of all lysis genes.These operons are overlapping with two strong promoter PL and PR respectively.The existence of cI repressor has stoped the combination of RNA polymerase.The cI repressor can be processed cell and inactivation by the UV-radiation or with ametycin.Allow that recombinant polypeptide expresses one more easily approach be application of temperature responsive type cI repressor cI857.Carrying the host cell that the γ base table reaches system can grow to mid-log phase and move to subsequently high temperature to induce the expression of recombinant polypeptide under low temperature.
A kind of widely used expression system utilizes the phage t7 RNA polymerase, and it only identifies the promotor that sees T7DNA, but not the promotor that exists in host cell chromosome.Therefore, expression construct can contain the T7 promotor (before promotor is positioned atgene 10 usually) that recombination merges with it.The gene of coding t7 rna polymerase is arranged on this expression construct, on another compatible expression construct or be integrated into host cell chromosome.In all three kinds of situations, gene all merges with allowing its inducible promoter of transcribing and translate at expression phase.
Intestinal bacteria (E.coli) bacterial strain BL21(DE3) and BL21(DE3) pLysS(Invitrogen, CA) for the host cell example that carries the t7 rna polymerase gene (some fit closely commercially available E.coli bacterial strains are arranged, its contain the t7 rna polymerase gene for example KRX and XJ(from dissolubility)).Other cell strain that carries the t7 rna polymerase gene is known in the art, for example the Pseudomonas aeruginosa ADD1976(Brunschwig﹠amp of t7 rna polymerase gene integration in its genome; Darzins, 1992) and the greedy copper bacterium (Cupriavidus necator) of t7 rna polymerase gene integration hookworm under the phaP promotor is controlled in its genome (in the past being called alcaligenes eutrophus (Ralstonia eutropha)) (Barnard et al., 2004).
T7 rna polymerase is compared with host cell enzymes has 3 advantages: the first, and it only is comprised of a subunit, and the second, the handling property that its performance is higher, and the 3rd, it is insensitive to Rifampin.A rear feature can usually be used for strengthening the content of fusion polypeptide by approximately adding this antibiosis after the gene inducing the coding t7 rna polymerase in 10 minutes especially.During that, synthetic enough polysaccharases, to allow the high level expression of fusion polypeptide, and suppress host cell enzymes, prevents the further expression of all other genes on plasmid and karyomit(e).Other microbiotic of anti-bacteria RNA polymerase but not t7 rna polymerase is known in the art, for example streptolydigin and streptovaricin.
Because all promoter systems have seepage, toxic protein may be harmful to cell the gene low expression level of coding t7 rna polymerase in the situation that those recombinant polypeptides are encoded.These polysaccharase molecules that exist at growth phase can suppress by the lysozyme gene of expressing the T7 coding.This enzyme is bifunctional protein, the chain link in its cracking host cell cell walls and by with its in conjunction with and selectivity suppresses t7 rna polymerase, this is controlled Feedback mechanism of transcribing outburst between a kind of T7 of guaranteeing period of infection.Intestinal bacteria (E.coli) bacterial strain BL21(DE3) pLysS is a host cell example that carries the plasmid pLysS of constitutive expression T7 N,O-Diacetylmuramidase.
In one embodiment, the promoter systems utilization is such as the promotor of API or APR, its be induced by temperature variation or " unlatching " with initial induction duration, for example by with temperature by approximately 30-37 ℃ be elevated to 42 ℃ and carry out initial induction durations.
During can preparing in vivo, strong promoter strengthens the fusion polypeptide density of microparticle surfaces.
The preferred fusion polypeptide that is used for one embodiment of the invention comprises (i) polymkeric substance synthase and (ii) comprises the fusion partner of at least one antibody binding domain.
Be used for the coding (i) of this paper and (ii) both nucleotide sequence comprise the nucleic acid of coding polymkeric substance synthase and the nucleic acid of the fusion partner that comprises at least one antibody binding domain of encoding.Once expression, fusion polypeptide can form or promote the formation of polymer particles.
In one embodiment, the nucleotide sequence of polymkeric substance synthase at least polynucleotide connexon or the spacerarm sequence and form the nucleotide sequence of albumen with encoding microsomal or the nucleic acid of coding fusion partner merges indirectly by desired length of encoding.
In one embodiment, encode at least one fusion partner fusion rotein aminoacid sequence with comprise the aminoacid sequence C-end adjacency of polymkeric substance synthase.
In one embodiment, the aminoacid sequence that comprises the fusion rotein of at least one fusion partner, the promotion fusion polypeptide by desired length independently folding peptide connexon or spacerarm and the aminoacid sequence N-end that comprises polymkeric substance synthase fragment merge indirectly.
In one embodiment, the encode aminoacid sequence and the aminoacid sequence N-end adjacency that comprises particulate and form albumen or C-end synthase fragment of fusion polypeptide of at least one fusion partner.
In one embodiment, the encode aminoacid sequence of fusion rotein of at least one fusion partner, promotion fusion polypeptide by desired length is folding peptide connexon or spacerarm independently, with the aminoacid sequence C-end that comprises particulate and form albumen or N-end polymer synthase fragment, indirectly merges.
In one embodiment, the encode aminoacid sequence N-end adjacency of aminoacid sequence and coding depolymerizing enzyme or C-end depolymerizing enzyme fragment of fusion polypeptide of at least one fusion partner.
Fusion polypeptide advantage is according to the present invention, modifies the function that does not affect the albumen that participates in polymer particles formation with the albumen of polymer particles surface bonding.For example, the function of polymkeric substance synthase is kept when recombinant polypeptide and the fusion of its N-end, thereby causes producing recombinant polypeptide at microparticle surfaces.If albumen functional or because merge, weaken, this shortcoming can make up by exercising identical function and with the extra particulate that active condition exists, forming albumen so.
, in this mode, can guarantee to be bonded to the recombinant polypeptide of polymer particles and stablize bonding by means of particulate forms albumen.
Should be understood that the distributing order of albumen in fusion polypeptide depends on the order of the gene order of contained nucleic acid in plasmid.
For example, may expect to prepare wherein fusion partner and the indirect fusion polypeptide that merges of polymkeric substance synthase.Term " fusion indirectly " refers to the fusion polypeptide that comprises particulate formation albumen (preferred polymers synthase) and at least one fusion partner, and it is separated by can be other albumen that is desirably in any albumen of expressing in fusion polypeptide.
In one embodiment, as discussed above, other albumen is selected from particulate and forms albumen or fusion polypeptide or promote connexon or the spacerarm that fusion polypeptide independently folds.In this embodiment, be necessary gene order in plasmid is sorted, with the expectation of reflection fusion polypeptide, arrange.
In one embodiment, fusion partner directly merges to the polymkeric substance synthase.Term " directly merges " at this paper connected via peptide bond in order to represent two or more peptides.
Also can form such particulate, wherein particulate comprises at least two distinct fusion polypeptide of with polymer particles, being combined.For example, comprise and can be bonded to polymer particles in conjunction with first fusion polypeptide in conjunction with territory of at least one enzyme product (merging to the polymkeric substance synthase), and the second fusion polypeptide that comprises enzyme can be bonded to polymer particles.
In one embodiment, expression construct is expressed in vivo.The preferred expression construct is in microorganism, the plasmid of expressing in preferred Eschericbia coli.
In one embodiment, expression construct is at vivoexpression.The preferred expression construct utilizes Cell free expression system at vivoexpression.
In one embodiment, one or more genes can insert in single expression construct, or one or more gene can be integrated in the host cell gene group.In all cases, can control expression by promotor as above.
In one embodiment, expression construct at least one additional fusion polypeptide of further encoding, described additional fusion polypeptide comprise the antigen of can the trigger cell mediated immunity replying or can be combined with at least one antigen of can the trigger cell mediated immunity replying form albumen in conjunction with territory and particulate, the preferred polymers synthase, as discussed above.
The plasmid that is used for this paper is shown in embodiment and at publication number, is WO2004/020623(Bernd Rehm) PCT/DE2003/002799 and publication number be WO2007/037706(Bernd Rehm) PCT/NZ2006/000251 in describe in detail, it incorporates this paper into its integral body respectively by reference.
The host who is used for the particulate preparation
Particulate of the present invention utilizes one or more expression construct as described herein to prepare in host cell expediently.Polymer particles of the present invention can prepare by making this expression construct of host cell expression.This can be by realizing in the progenitor cell of at first expression construct being introduced host cell or host cell, for example by with the progenitor cell of expression construct conversion or transfection host cell or host cell, or by alternate manner, guarantee that expression construct is present among host cell.
After conversion, at the host cell that is applicable to keep conversion under the condition of expression construct expression fusion polypeptide and formation polymer particles.As known in the art, this type of Conditional Include is applicable to the selected table expression constructs, for example those conditions of expressing in suitable organism of plasmid.For example, particularly when expecting high yield or crossing expression, provide the particulate that suitable substrate allows fusion polypeptide to form protein ingredient formation polymer particles in substratum.
Preferred host cell is, for example, bacterial cell, fungal cell, yeast cell, vegetable cell, insect cell or zooblast, preferable separation or the non-human host cell.After the consideration item that careful note this paper discusses, for the preparation of the method known in the art of recombinant polymers particulate (Sambrook et al. for example, 1987; Ausubel et al., 1987) host cell that uses in often is applicable to method of the present invention.
Suitable prokaryotic host cell comprises, for example, eubacterium, for example Gram-negative or Gram-positive organism, for example, enterobacteriaceae (Enterobacteriaceae) is as intestinal bacteria (E.coli).Multiple coli strain can openly obtain, e. coli k12 strain MM294(ATCC31 for example, 446); Intestinal bacteria X1776(ATCC31,537); Coli strain W3110(ATCC27,325) and K5772(ATCC53,635).other suitable prokaryotic host cell comprises for example Escherichia (Escherichia spp.) of other enterobacteriaceae, enterobacter (Enterobacter), erwinia (Erwinia), Klebsiella (Klebsiella), proteus (Proteus), salmonella (Salmonella) is salmonella typhi (Salmonella typhimurium) for example, serratia (Serratia) is serratia marcescens (Serratia marcescans) and Shigella (Shigella) for example, and bacillus (Bacilli) for example subtilis (B.subtilis) and Bacillus licheniformis (B.licheniformis), Rhodopseudomonas (Pseudomonas) is Pseudomonas aeruginosa (P.aeruginosa) for example, reach for example streptomyces (Streptomyces) of actinomycetes (Actinomycetes), Rhod (Rhodococcus), corynebacterium (Corynebacterium) and Mycobacterium (Mycobaterium).
For example, in certain embodiments, can use coli strain W3110, because it is the common host strain that is used for the fermentation of recombinant DNA product.The proteolytic ferment of preferred host cell secretion minimum.For example, can modify bacterial strain W3110 with genetic mutation in the gene of realizing coding host intrinsic protein, this type of host's example comprises intestinal bacteria W3110 bacterial strain 1A2, and it has complete tonA genotype; Intestinal bacteria W3110 bacterial strain 9E4, it has complete tonA ptr3 genotype; Intestinal bacteria W3110 bacterial strain 27C7(ATCC55,244), it has complete tonA ptr3phoA E15(argF-lac) and 169degP ompT kanr genotype; Intestinal bacteria W3110 bacterial strain 37D6, it has complete tonA ptr3phoA E15(argF-lac) 169degP ompT rbs7ilvG kanr genotype; Intestinal bacteria W3110 bacterial strain 40B4, it is the bacterial strain 37D6 with non-kalamycin resistance degP deletion mutantion.
For example, in some preferred embodiment, can use and not produce the endotoxic Lactococcus lactis of lipopolysaccharides (Lactococcus lactis) bacterial strain.The example of lactococcal strain comprises MG1363 and lactococcus lactis subsp (Lactococcus lactissubspecies cremoris) NZ9000.
For example, except prokaryotic organism, eukaryotic cell microorganism for example filamentous fungus or yeast also for being used for suitable clone and the expressive host of the inventive method.Example comprises yeast saccharomyces cerevisiae (Saccharomyces cerevisiae), a kind of low microorganism such as eucaryon host such as grade commonly used.Other example comprises chestnut wine fission yeast (Schizosaccharomyces pombe) (Beach and Nurse, 1981; EP139,383), genus kluyveromyces (Kluyveromyces) host (U.S. Patent No. 4,943,529; Fleer et al., 1991) Kluyveromyces lactis (K.lactis) (MW98-8C, CBS683, CBS4574 for example; Louvencourt et al., 1983), crisp closet kluyveromyces (K.fragilis) (ATCC12,424), Bulgarian kluyveromyces (K.bulgaricus) (ATCC16,045), dimension gram Durham kluyveromyces (K.wickeramii) (ATCC24,178), Wa Erte kluyveromyces (K.waltii) (ATCC56,500), fruit bat kluyveromyces (K.drosophilarum) (ATCC36,906; Van den Berg et al, 1990), heat-resisting kluyveromyces (K.thermotolerans) and kluyveromyces marxianus (K.marxianus), Ye Shi yeast belong (yarrowia) (EP402,226); Pichia pastoris phaff (Pichia pastoris) (EP183,070; Sreekrishna et al., 1988); Mycocandida (Candida); Trichodermareesei (Trichoderma reesia) (EP244,234); Neuraspora crassa (Neurospora crassa) (Case et al., 1979); Permitted prosperous yeast belong (Schwanniomyces) and for example permitted prosperous yeast (Schwanniomyces occidentalis) (EP394,538, October 31 nineteen ninety is open) in west; With filamentous fungus for example Neurospora (Neurospora), Penicillium (Penicillium), Tolypocladium (Tolypocladium) (WO91/00357, on January 10th, 1991 is open) and aspergillus niger belong to for example Aspergillus nidulans (A.nidulans) (Ballance et al., 1983 of (Aspergillus) host; Tilburn et al., 1983; Yelton et al., 1984) and aspergillus niger (A.niger) (Kelly and Hynes, 1985).Methylotrophic yeast is applicable to this paper and comprises the yeast with lower class of being selected from that can grow on methyl alcohol: Hansenula (Hansenula), mycocandida (Candida), Kloeckera (Kloeckera), Pichia (Pichia), yeast belong (Saccharomyces), torulopsis (Torulopsis) and Rhodotorula (Rhodotorula).Concrete species inventory as this type of yeast example is found in Anthony, 1982.
Example without the vertebra host cell comprises insect cell for example fruit bat (Drosophila) S2 and spodoptera (Spodoptera) Sf9; And vegetable cell, for example cell culture of cotton, corn, potato, soybean, petunia, tomato and tobacco.That has identified numerous baculovirus strains and variant and correspondence for example covets the permissive insect host cell of noctuid (Spodoptera frugiperda) (caterpillar), Aedes aegypti (Aedes aegypti) (mosquito), Aedes albopictus (Aedes albopictus) (mosquito), drosophila melanogaster (Drosophila melanogaster) (fruit bat) and silkworm (Bombyx mori) in meadow from the host.Multiple virus strain for transfection can openly obtain, for example, the Bm-5 strain of the L-1 variant of Autographa californica multicapsid nucleopolyhedrosisvirus nucleopolyhedrosis virus (Autographa californica) NPV and silkworm nuclear-polyhedrosis virus (Bombyx mori) NPV, and this viroid can, in this article as according to virus of the present invention, be coveted noctuid (Spodoptera frugiperda) cell especially for the transfection meadow.
The example of available mammalian host cell line is the CV1 monkey-kidney cells system (COS-7, ATCC CRL1651) that SV40 transforms; Human embryonic kidney cell line (293 or through subclone, carry out 293 cells of suspension culture, Graham et al., J.Gen Virol.36:59 (1977)); Baby hamster kidney cell system (BHK, ATCC CCL10); Chinese hamster ovary cell/-DHFR(CHO, Urlaub et al., 1980); Properties of Sertoli Cells Isolated from Mice Testis (TM4, Mather, 1980); Monkey-kidney cells (CV1ATCC CCL70); African green monkey kidney cell (VERO-76, ATCC CRL-1587); Human cervical carcinoma cell (HELA, ATCC CCL2); Madin-Darby canine kidney(cell line) (MDCK, ATCC CCL34); Buffalo rats liver (BRL3A, ATCC CRL1442); Human pneumonocyte (W138, ATCC CCL75); Human liver cell (Hep G2, HB8065); Mouse mastopathy cell (MMT060562, ATCC CCL51); TRI cell (Mather et al., 1982); The MRC5 cell; The FS4 cell; And Polymerase chain reaction (Hep G2).
For example, work as fusion partner, for example enzyme or antibody binding domain need one or more posttranslational modifications, for example during glycosylation, with preferred eukaryotic cell lines, for example mammal cell line.For example, one or more enzymes may need posttranslational modification to have optimum activity, and therefore can be in the expressive host that can carry out this type of posttranslational modification effective expression.
In one embodiment, host cell is the cell with oxidisability endochylema, for example intestinal bacteria Origami bacterial strain (Novagen).
In another embodiment, host cell is the cell with reductibility endochylema, preferred intestinal bacteria.
For example, host cell can be selected from following class: Lei Er Bordetella (Ralstonia), Alcaligenes (Acaligenes), Rhodopseudomonas (Pseudomonas) and salt two type Pseudomonas (Halobiforma).for example, preferred microorganism used is selected from: alcaligenes eutrophus (Ralstonia eutropha), loose Alcaligenes (Alcaligenes latus), intestinal bacteria (Escherichia coli), crisp pseudomonas (Pseudomonas fragi), pseudomonas putida (Pseudomonas putida), Pseudomonas oleovorans (Pseudomonas oleovorans), Pseudomonas aeruginosa (Pseudomonas aeruginosa), Pseudomonas fluorescens (Pseudomonas fluorescens), with salt two type bacterium (Halobiforma haloterrestris).This group had both comprised can prepare microorganism biocompatible, the biodegradable particulate natively, comprises again microorganism such as intestinal bacteria (it can not so be done due to its genomic constitution).Be introduced as described above and make the described microorganism of the latter can prepare the required gene of particulate.
The polymer particles that extreme halotolerant archeobacteria preparation has more low-level albumen non-specific binding, make separate from these cells and the purifying particulate more easy.
In principle, any educable host cell all can, by aforesaid method for the preparation of polymer particles, form the required substrate of polymer particles even if host cell can not prepare due to different metabolism.In this case, add and must also convert it into polymer particles by the expressed albumen of the gene of introducing cell subsequently by substrate in substratum.
Be used for the gene make the described host cell of the latter can prepare polymer particles and comprise for example thiolase, reductase enzyme or polymkeric substance synthase, for example from phaA thiolase, phaB ketoacyl reductase enzyme or the phaC synthase of alcaligenes eutrophus (Ralstonia eutropha).Need which kind of gene to increase that host cell forms for polymer particles that gene that the key element lack will depend on host cell forms and substratum in which kind of substrate of providing.
Participate in the gene of formation PHA (PHA) particulate and the overall consideration item of albumen and the formation of relevant particulate and be reported in Madison, et al, 1999; Disclosed PCT International Application No. WO 2004/020623(Bernd Rehm); And Rehm, 2003; Brockelbank JA.et al., 2006; Peters and Rehm, 2006;Et al, (2006) and Rehm (2006), it all incorporates this paper by reference into.
The polymkeric substance synthase uses in how (R)-hydroxyl acyl group-CoA in office or the host cell of other CoA thioesters or derivatives thereof as substrate separately.
Polymer particles also can externally form.For example, preferably use Cell free expression system.The polymkeric substance synthase is provided in this system.The polymkeric substance synthase of preferred purifying, for example can be prepared by restructuring, or in can carrying out the cell free system of protein translation, can be by introducing the encode expression construct of polymkeric substance synthase and the polymkeric substance synthase that obtains in cell free system self.To allow the outer environment that forms of microsome in order preparing, should to comprise in substratum that polymer particles forms necessary substrate.
The polymkeric substance synthase for example can utilize (R)-hydroxyl acyl group-CoA or other CoA thioesters as substrate and be used for the external functionalized polymer particulate for preparing.
Before being used for the preparation of polymerization in vitro thing particulate, fusion polypeptide can utilize cell sorter, centrifugal, filtration or affinity chromatography and from lysing cell purifying.
Polymerization in vitro thing particulate forms can the optimal control surface composition, comprises fusion polypeptide covering level, Lipid composition etc.
The characteristic that should be understood that polymer particles can be affected or be controlled by the condition that control prepares polymer particles.For example, this can comprise the genomic constitution of host cell, for example prepares oarse-grained cell fission mutant,, as Peters and Rehm, discusses in 2005.Keep in addition the condition of host cell, for example existence of temperature, substrate, one or more particulate formation albumen for example particle size determine the existence of albumen, the existence of polymkeric substance conditioning agent, etc.
In one embodiment, polymer particles desired characteristic is persistence.Term " persistence " refers to polymer particles degradation-resistant ability in selected environment.Another desired characteristic of polymer particles is that it forms albumen by polymkeric substance synthase or particulate and forms, and is bonded to polymkeric substance synthase or particulate at the particulate assembly process and forms C-or the N-end of albumen.
In certain embodiments of the invention, be desirably in host cell the expression of crossing that realizes expression construct.The expression mechanism of crossing of particular expression construct is known in the art, and will depend on construct self, its host and other factors to be expressed, comprises the expression degree excessively of expectation or needs.For example, can realize in the following way expression: i) utilize the strong promoter system in prokaryotic hosts, for example the t7 rna polymerase promoter systems; Ii) utilize high copy number plasmid, for example contain the plasmid of colE1 replication origin; Or iii) stablize messenger RNA(mRNA), for example by the application fusion sequence; Or iv) by such as optimizing codon, with, ribosome bind site or termination site etc., optimizing translation.Crossing the benefit of expressing can allow to prepare than the polymer particles of small particle with the higher number of preparation when expectation.
The polymkeric substance that forms polymer particles forms machinery or the physicochemical property that can affect polymer particles.For example, polymkeric substance forms other polymer particles possibility half life difference, perhaps may be with different speed release of bioactive substances, particularly active constituents of medicine.For example, by C6-C14The polymer particles that the 3-hydroxy fatty acid forms is because the low-crystallinity of this polymkeric substance presents higher polymer degradation speed.Increase the molecular ratio of the polymeric components that on polymer backbone, side chain is relatively large, usually can reduce degree of crystallinity and cause the elastic performance of more giving prominence to.Form by the polymkeric substance of controlling according to described herein and means known in the art, therefore can correspondingly affect the biodegradability of polymer particles and affect polymer particles (with one or more fusion partners when existing) for example, time length in the tangential flow filtration system, or affect one or more target substances or its precursor to the combination of polymer particles, to the catalysis of polymer particles or the release of autohemagglutination compound particulate.
Preferably at least a lipid acid with functional side group is introduced substratum as the substrate that forms polymer particles, wherein particularly preferably introduce at least a hydroxy fatty acid and/or at least a sulfydryl lipid acid and/or at least a beta-amino lipid acid." lipid acid with functional side group " is interpreted as representing saturated or unsaturated fatty acids.These also comprise and contain the lipid acid that is selected from following functional side group: methyl, alkyl, hydroxyl, phenyl, sulfydryl, primary amine groups, secondary amine and tertiary amine groups, aldehyde radical, ketone group, ether, carboxyl, O-ester group, thioester substrate, carboxylic acyloxy amido, hemiacetal group, acetal radical, mono phosphoric acid ester ester group and phosphate diester base.The use of substrate expects to form by polymer particles and expected performance decides.
Substrate or substrate mixture can comprise amino acid, lactic acid salt, ester or the saturated or unsaturated fatty acids of at least a optional replacement, preferred acetyl-CoA.
In one embodiment, one or more materials are provided in substrate mixture and integrate with polymer particles during polymer particles forms, or be diffused in polymer particles.
Polymer particles can comprise the polymkeric substance that for example is selected from poly-beta-hydroxy acid, poly-lactic acid ester, polythioester and polyester.Most preferably polymkeric substance comprises PHA (PHA), preferably gathers (3-hydroxybutyrate ester) (PHB).
Polymkeric substance synthase or polymer particles preferably comprise the phosphatide individual layer that encapsulates polymer particles.Preferred described particulate forms albumen across described lipid monolayer.
Polymkeric substance synthase or particulate form the albumen preferred combination to polymer particles in conjunction with or with the phosphatide single layer, or with both equal combinations.
Particulate forms albumen preferably covalently or non-covalent its formed polymer particles that is bonded to.
The preferred polymers particulate has fusion polypeptide at least about 1%, 2%, 3%, 4%, 5%, 10%, 15%, 20%, 25%, 30%, 35%, 40%, 45%, 50%, 55%, 60%, 65%, 70%, 75%, 80%, 85%, 90%, 95%, 99% or 100% surface coverage.
Under some environment, the prepared particle size of possible desired control the inventive method, for example be particularly suitable for the particulate of given application with preparation.For example, may expect to prepare the relatively large polymer particles that comprises one or more fusion partners, for example to support powerful weather resistance.For example, in the particulate situation for the preparation of one or more antibody, may expect to prepare the relatively large polymer particles that comprises one or more antibody binding domains with the weather resistance of guaranteeing the tangential flow filtration system and functional.In other example, for example at enzyme substrates in the catalysis of target substance, may expect to prepare the relatively little polymer particles that comprises one or more enzymes, for example so that the tangential flow filtration system can have relatively high enzyme concn.It is in the PCT/NZ2006/000251 of WO2007/037706 that the method for control polymer particles size is described in PCT/DE2003/002799 and the publication number that publication number is WO2004/020623.
For example, in certain embodiments, particle size forms the expression of albumen or controls by the expression of controlling particle size decision albumen if present by controlling particulate.
For example, in other embodiments of the present invention, particle size control can be by controlling substrate utilizability, for example substratum in the utilizability of substrate realize.In some instances, add substrate by the amount of sufficient to guarantee control polymer particles size in substratum.
Should understand these class methods of application capable of being combined, thereby can realize more efficiently control to particle size.
For example, in different embodiments, can control particle size with prepare particle diameter approximately 10nm to 3 μ m, preferred approximately 10nm to about 900nm, approximately 10nm to about 800nm, approximately 10nm to about 700nm, approximately 10nm to about 600nm, approximately 10nm to about 500nm, approximately 10nm to about 400nm, approximately 10nm to about 300nm, approximately 10nm to about 200nm and particularly preferably approximately 10nm to the about particulate of 100nm.
For example, in other embodiments, can control particle size with prepare particle diameter approximately 10nm to about 90nm, approximately 10nm to about 80nm, approximately 10nm to about 70nm, approximately 10nm to about 60nm, approximately 10nm to about 50nm, approximately 10nm to about 40nm, approximately 10nm to about 30nm or approximately 10nm to the about particulate of 20nm.
Considered especially other scope of average polymer size, for example, comprised the scope that falls within above-mentioned scope, such as particle diameter approximately 50 to about 500nm, approximately 150 to about 250nm or approximately 100 to the about polymer particles of 500nm etc.
For example, in different embodiments, the about about about about about about about 35nm or following of 50nm or following and 5% particle diameter of 60nm or following, 25% particle diameter of 80nm or following, 40% particle diameter of 100nm or following, 45% particle diameter of 150nm or following, 60% particle diameter of 200nm or following, 80% particle diameter of 90% particle diameter in prepared particulate.
For example, in different embodiments, the method prepares median size less than about 200nm, less than about 150nm or less than the about polymer particles of 110nm.
The present invention is comprised of aforementioned content, also imagines the framework that hereinafter only provides as an example.
Embodiment
Embodiment 1: by the tangential flow filtration IgG purification
This embodiment has described the polymer particles that represents antibody-Binding peptide territory and multiple commercially available tangential flow film and has united purposes for the IgG purification immunoglobulin (Ig).
Material and method
All filter and carry out with Sartorius Crossflow Slice200 system.Use is available from the following film of Sartorius: 0.1 μ m polyethersulfone, 0.2 μ m Hydrosart and 100kDa Hydrosart.
Pressure-controlling
P1, P2 and P3 are connected to pressure transmitter, by each point, record and signal is delivered to central controller.P1, P2 and P3 initially control by clamping tube, then at a run duration, are placed in and do not touch (water flux and diafiltration).Therefore, keep transmembrane pressure (TMP) by automatic change pump feeding rate.
The particulate preparation
In bio-reactor, the E.coli BL21 bacterium of carrying pET14b-ZZ (-) phaC plasmid by cultivation prepares the ZZPhaC polymer particles.(Brockelbank etc., 2006).All biomass are dissolved with the BugBuster scheme and are washed 3 times in 50mM potassium phosphate buffer (pH7.5).
The 2.69g polymer particles is suspended in the 50mM potassium phosphate buffer (pH7.5) of 50mL again, obtains the 53.8g/L polymer particulate suspending liquid.
The 53.8g/L polymer particulate suspending liquid of 15mL is added the 50mM phosphate buffered saline buffer (pH7.5) of 100mL, obtain the 8.07g/L polymer particulate suspending liquid.
The 8.07g/L polymer particulate suspending liquid of this 100mL is used for diafiltration during tangential flow filtration.
Clear water flux
Before the polymer particulate suspending liquid diafiltration and carry out afterwards clear water flux with the monitor filter film quality.
0.1 μ m strainer :-
Before diafiltration, TMP=1.1bar, permeate stream=272mL/min.
After diafiltration, with 1M NaOH(40 ℃) with the sterilizing 15min of film, and then sterilizing 30min, and with MQ water, rinse.Make 0.1M NaOH be cycled to used in storage in film.
TMP=1bar, permeate stream=248mL/min.
0.2 μ m strainer :-
Before diafiltration, TMP=1.1bar, permeate stream=284mL/min.
After diafiltration, with 1M NaOH(40 ℃) with the sterilizing 30min of film, then 50min, and then 30min, and with MQ water, rinse.Make 0.1M NaOH be cycled to used in storage in film.
TMP=1.1bar, permeate stream=228mL/min.
The 100kDa strainer :-
Before diafiltration, TMP=1.3bar, permeate stream=136mL/min.
After diafiltration, with 1M NaOH(40 ℃) with the sterilizing 15min of film, and with MQ water, rinse.Make 0.1M NaOH be cycled to used in storage in film.
TMP=1.3bar, permeate stream=120mL/min.
Diafiltration
8.7g/L polymer particulate suspending liquid with 50mM potassium phosphate buffer (pH7.5) the diafiltration 100mL of 2L.Filter, until be finished approximately 18-20min of 2L().TMP remains unchanged during various pumps charging flow velocity.
Result
Retentate is analyzed
Initial feed is carried out the blue dyeing of micro polymer corpuscular protein figure SDS-PAGE(Coomassie, referring to Fig. 5), IgG purifying, GC/MS(be referring to Fig. 6) and TEM(referring to Fig. 7) analyze (being respectively Fig. 6 A and 7A) and the tangential flow filtration retentate carried out the blue dyeing of micro polymer corpuscular protein figure SDS-PAGE(Coomassie, referring to Fig. 5), IgG purifying, GC/MS(be referring to Fig. 6) and TEM(referring to Fig. 7) analyze (being respectively Fig. 6 B and 7B).
Can find out, use polymer particles of the present invention to realize the final efficiently purifying of fabulous flow velocity, permeate collection speed and IgG immunoglobulin (Ig).GC/MS analyzes demonstration and has removed the lipid acid pollutent.
These data have also shown typical and have been used under the condition of tangential flow filtration, and polymer particles of the present invention does not suffer distortion (referring to Fig. 7 B) or infringement (Fig. 6 B and Fig. 7 B).GC/MS analyzes and does not show the polymer degradation products evidence.These data presentation are used tangential flow technology (comprising film, strainer and filter apparatus) opposing infringement and the dirt of polymer particles of the present invention and therefore will can not polluted target substance, and can easily regenerate to reuse.
Discuss
The present embodiment has proved that clearly the inventive method of using polymer particles as described herein in the tangential flow filtration technology is highly suitable for separating and prepare valuable target molecule from complex mixture.
Introduce
This embodiment has described and has comprised Z-territory polymer particles and TFF in the purposes in mixing solutions purifying human IgG.
Material and method
The polymer particles of the present invention (as described above in Example) that 5g is comprised the Z-territory be added to BSA and IgG solution (the 50ml suspension in PBS, pH7.4).Allow IgG to be bonded to the period (30min) of one section setting of polymer particles.After preincubate, at the TFF(0.1um film) upper diafiltration polymer particles-IgG-BSA suspension diafiltration volume several times.The albumen that exists in diafiltration level part by 280nm place light absorption ratio measurement collection (A280,50ml level part), and draw elution profile (to observe removing of BSA).When A280 reached 0, by adding Citrate trianion (pH3.0) wash-out IgG, and in penetrant, the wash-out of IgG was followed and is analyzed diafiltration level part (silver dyeing) by A280 with by SDS-PAGE.
Result
As shown in Figure 8, the initial A280 light absorption ratio of BSA explanation., atlevel part 13 places, when diafiltration level part light absorption ratio is zero, adds Citrate trianion and be used as diafiltration buffer, while wash-out IgG.Use molar extinction coefficient separately calculates the relative quantity of IgG and BSA.This calculation result shows and exists in diafiltration level part IgG and BSA with the quantitative recovery of their prepared ratios in initial soln.
For first peak and the second peak of determining A280 is respectively BSA and IgG, SDS-PAGE is to check the albumen in each diafiltration level part in operation.In Fig. 9 A, gel has shown initial soln and each of diafiltration level part 1-13 of analyzing from TFF.This gel has confirmed that BSA mainly is present in front wash-out diafiltration level part (exist trace not in conjunction with IgG).As shown in Fig. 9 B, operation the second gel is to observe the albumen in diafiltration level part 14-26.Collect immediately afterwards these grades part and wash-out IgG subsequently adding Citrate trianion (pH3.0).
These results show that IgG mainly enters penetrant from the polymer particles wash-out.
Discuss
This result has proved that clearly utilizing the inventive method of the polymer particles that comprises the Z-territory in TFF is effective for the solution purification IgG from comprising contaminating protein (BSA).Similarly, the inventive method is effectively for the solution that preparation has removed IgG, and this has proved the effectiveness of the inventive method in for example without immunoglobulin (Ig) serum, preparing.
Embodiment 3.GBl-territory polymer particles and TFF are in the application from lowlenthal serum purifying goat IgG.
Introduce
The polymer particles that the present embodiment has been described in TFF preparation and used the GB1 territory that comprises Protein G is with from complex mixture purifying goat IgG.
Material and method
The structure of expression plasmid
Following structure plasmid pET-14b PhaC-(GB1) 3.By Genscript Inc. synthetic DNA sequence (SEQ ID NO.1 in appended serial ID list), described DNA sequence encoding N-end connexon (LEVLAVIDKRGGGGGSGGGSGGGSGGGG, [SEQ ID NO.2]) and three GBl from Protein G in conjunction with territory (Streptococcus sp.), each is separated by connecting subdomain (SGGGSGGGSGGGGS, [SEQ ID NO.3]).The XhoI/BamHI site of introducing is in order to substitute the MalE coding DNA territory (Jahns and Rehm, 2009) in plasmid pET14b PhaC-MalE.This formation has in appended serial ID list the plasmid pET-14b PhaC-(GB1) 3 as DNA sequence dna as described in SEQ ID NO.4.
Plasmid pET-14b PhaC-(GB1) 3 is introduced the coli strain (Amara and Rehm, 2003) of holding plasmid pMCS69 can prepare the PHB polymer particles of demonstration (GB1) 3.
The IgG purifying
Use TFF base IgG combination and purification schemes with from lowlenthal serum combination and IgG purification.5mL lowlenthal serum sample is added to 35.5ml(5g) comprise the polymer particulate suspending liquid of the present invention in GBl-territory.Add polymer particles with fully in conjunction with IgG(5g weight in wet base polymer particulate suspending liquid for example with calculating concentration〉the IgG binding ability of 220mg) and the final volume that is adjusted to 50ml to make the final serum dilution of 1:10 in PBS.With PBS diafiltration mixture until remove serum protein fully when measuring (Figure 10) by A280nm and by SDS-PAGE, measure (Figure 11).With the 50cm with 0.1nm aperture2The tubular fibre cylinder carries out diafiltration.In case remove serum protein, retentate be concentrated into 20ml and then use goat IgG in sodium citrate salt (pH3.0) wash-out 50ml retentate.
Result
Digital proof shown in Figure 10 and 11 IgG successfully from lowlenthal serum, remove, therefore prepared the serum protein without IgG, and the polymer particles wash-out that then IgG of purifying can be in retentate and use low pH damping fluid diafiltration to make the IgG of purifying pass penetrant to be released.
Discuss
This result proved in TFF the inventive method of utilizing the polymer particles that comprises the GB1-territory for from complex mixture at first purifying be effective without serum protein preparation and the subsequent purificn IgG of IgG.Therefore, by selecting suitable percolation condition, the inventive method can provide required one-tenth classification part in succession from complex mixture.
Introduce
The present embodiment has been described TFF and has been comprised of the present invention polymer particles purposes during from solution removing inorganic substance (gluey gold) of gold in conjunction with territory.
Method
As describe the preparation comprise golden binding peptide polymer particles (referring to Jahns, A.C etc., Bioconjugate Chem.2008,19,2072-2080).Prepare 0.005% solution of the gluey golden particulate of 10nm and it is equilibrated at 20cm in the 30ml deionized water2, on 0.2um tubular fibre micro-filtration cylinder.Moving this system under recirculation fully, the retentate tank is returned in the penetrant charging.Measure the amount of golden particulate by 520nm place light absorption ratio.In measuring penetrant level part after the light absorption ratio of gluey gold solution, with the final 1mg/ml of 30mg() polymer particles be added to the retentate storage tank.With 4 minutes intervals from incoming flow sampled permeate level part.Located in 8 and 29 minutes, the polymer particles of extra 300mg is added to retentate with further combined with residue gold in solution.
Result
Easily by Figure 12, found out the minimizing of gluey gold content in penetrant, this has clearly proved TFF and has comprised the polymer particles effectiveness from solution chelating golden particulate of gold in conjunction with territory.
Discuss
The present embodiment has proved that clearly the inventive method is reclaiming mineral compound and from solution, removing effectiveness them.The method both can be applied to mineral compound be valuable, and need to reclaim its environment, the environment that also can be applied to mineral compound and be pollutent and its other composition that exists need to be removed from solution or other solution.
Introduce
The present embodiment has been described TFF and has been comprised the purposes of polymer particles in the biological treatment biomolecules of enzyme.At this moment, comprise diastatic polymer particles in order to soluble starch suspension is converted into maltose.
Method
As describe the preparation comprise diastatic polymer particles (referring to Rasiah, I., Rehm, B.H.A., (2009) One-step production of immobilised a-amylase in recombinant Escherichia coli.Appl Environ.Microbiol.75:2012-2016).Under 50 ℃, with the soluble starch PBS suspension (300ml) of 2g polymer particles oscillation incubation (batchwise operation) 1%w/v, 4%w/v and 8%w/v.After hatching 2 hours, 1% starch-polymer microparticle suspending liquid diafiltration is entered to be fixed with 110cm2, 0.1um micro-filtration cylinder the TFF system.Collect diafiltration level part (50ml) and measure after a while maltose concentration.In addition, cross 200ml PBS damping fluid by diafiltration and from polymer particles, wash maltose.
After collecting 1% solution fully, 4% starch-polymer microparticle suspending liquid is added to identical retentate and this system is crossed in diafiltration, and in an identical manner from 8% suspension recovery maltose.In case complete TFF, measure the maltose amount (Figure 13) that reclaims in penetrant.
Result
As can be by the clear finding of Figure 13, be bonded to the amylase of polymer particles can be in the TFF system preparation of catalysis maltose, this has proved that particulate-connection catalyzer can be used for the high temperature application and product (maltose) can easily remove from reaction suspension.
Discuss
In this embodiment, polymer particles and high molecular starch remain in and allow in retentate level part that hydrolysis occurs, and low molecular weight product maltose separates serially and enters diafiltration level part.
The present embodiment clearly proved the inventive method under the active mediation by the polymer particles desmoenzyme with feedstock conversion, be required product and reclaim this product from solution effectiveness.
Introduce
The present embodiment has been described the polymer particles and the expression of this particulate at intestinal bacteria (Escherichia coli.) that comprises organic phosphohydrolase (OpdA) from radiation edaphic bacillus (A.radiobacter) preparation.OpdA via the connection subdomain of design the N-end merge to the polymer particles of alcaligenes eutrophus (Ralstonia eutropha) form enzyme PhaC(referring to Blatchford etc., in press Biotech.Bioeng.).
Material and method
Bacterial isolates and growth conditions
In this research, bacterial isolates used is listed in the table below 1.Except as otherwise noted, all coli strain grows under 37 ℃.When needed, add microbiotic with following concentration: penicillin (75 μ g/ml), paraxin (50 μ g/ml) and tsiklomitsin (12.5 μ g/ml).For the polymer particles preparation, cell grows to OD under 37 ℃600Be 0.45, then by adding 1mM IPTG, induce.After inducing, culture was cultivated 44 hours under 30 ℃ in shaker flask.
Table 1. bacterial isolates, plasmid and oligonucleotide
Tcr-tetracyclin resistance, Apr-penicillin resistance, Cmr-chlorampenicol resistant
Plasmid and oligonucleotide
This institute lists in upper table 1 with plasmid.Use the common known method in this area generally to clone program and DNA segregation.DNA primer, deoxynucleoside triphosphate, T4DNA ligase and Taq polysaccharase are available from Integrated DNA Technologies, (CA, USA).Chemical reagent is available from Sigma Aldrich(St.Louis, MO).
Structure for the preparation of the plasmid of functional OpdA polyester granulate
As the inset of plasmid pETMCSI, by CSIRO, Canberra, Australia obtain the opdA DNA sequence dna of coding organic phosphorus degrading albumen.5' and 3' restriction site design primer with design.The 5' primer (5' – XhoI, [SEQ ID NO.5] carries the XhoI restriction site, and (3' – BamHI, [SEQ ID NO.6] carries the BamHI restriction site to the 3' primer.Carry out Pfx PCR to enlarge the OpdA coding region with the primer that Sigma makes.This fragment is for gathering that A ends up and catching into plasmid pGEM-T Easy.Use indigo plant/be chosen in vain on indicator plate and screen transformant.By confirming that step-sizing operation restructuring white colony is used for the opdA inset.By with XhoI and BamHI Restriction Enzyme, being hydrolyzed, the opdA sequence is from plasmid pGEM-T Easy cracking.Plasmid pET14b PhaC-connexon-MalE connects the necessary suitable carrier of subdomain as comprising after OpdA protein N terminal hydrophobicity analysis.With XhoI and BamHI hydrolysis plasmid pET14b PhaC-connexon-MalE with from plasmid cracking MalE territory.The opdA sequence clone is entered XhoI and the BamHI site of the key pET14b PhaC-of plasmid connexon, obtain plasmid pET14b PhaC-connexon-OpdA.This carries e. coli bl21 λ (the D Ε 3) competent cell of plasmid pMCS69 in order to conversion, its mediation polymer particles forms the synthetic of required precursor R-3-maloyl group-coenzyme A (CoA).The DNA sequence dna of novel plasmid carrier is by determining that DNA sequence confirms.In order to prepare the comparison polymer particulate that does not show the OpdA activity, the wild-type PhaC of its alcaligenes eutrophus of only encoding of plasmid pETC() be used for e. coli bl21 λ (D Ε 3) under the existence of plasmid pMCS69.
Analysis of protein
Analyze polyester albumen figure by sodium laurylsulfonate (SDS)-polyacrylamide gel electrophoresis (PAGE), as Laemmli, described in U.K.1970.Cleavage of structural proteins during the assembly of the head of bacteriophage T4.Nature227:680-5.Gel dyes with Coomassie brilliant blue G250.Use Bradford protein quantification method to measure protein concentration.
Use MALDI-TOF mass spectrum fingerprint recognition to analyze tryptic peptide
In order to differentiate the PhaC-OpdA fusion rotein, the target protein band is cut out and carries out tryptic digestion, (15) tryptic peptide by MALDI-TOF mass spectroscopy gained subsequently as described above from gel.
Polyester is analyzed
Measure polyester by gas chromatography/mass spectrometry (GC/MS) quantitative and qualitative analysis, the preparation of poly butyric ester (it shows the polyester synthase activity in vivo), as Brandl, H., R.A.Gross, R.W.Lenz, and described in R.C.Fuller.1988.Pseudomonas oleovorans as a Source of Poly (beta-Hydroxyalkanoates) for Potential Applications as Biodegradable Polyesters.Appl.Env.Microbiol.54:1977-1982.
Polymer particles
Use mechanical cytoclasis and gradient ultracentrifugation on glycerine, from recombinant Bacillus coli cells isolating polymer particulate, as Jahns, A.C, R.G.Haverkamp, and described in B.H.Rehm.2008.Multifunctional inorganic-binding polymer particles self-assembled inside engineered bacteria.Bioconj.Chem.19:2072-80.Prepare the comparison polymer particulate from e. coli bl21 λ (the D Ε 3) cell that carries pMCS69 and pETC.
Microscopy
After the Nile red colouring, manifest the polyester granulate that generates in bacterial cell with fluorescent microscope, as Peters, V., and described in B.H.Rehm.2005.In vivo monitoring of PHA granule formation using GFP-labeled PHA synthases.FEMS Microbiol.Lett.248:93-100.
Enzyme test
use Dumas and coworkers(Dumas, D.P., S.R.Caldwell, J.R.Wild, with F.M.Raushel.1989.Purification and properties of the phosphotriesterase from Pseudomonas diminuta.J.Biol.Chem.264:19659-19665) and (Harcourt such as Harcourt, R.L., I.Horne, T.D.Sutherland, B.D.Hammock, R.J.Russell, with J.G.Oakeshott.2002.Development of a simple and sensitive fluorimetric method for isolation of coumaphos-hydrolysing bacteria.Lett.Appl.Microbiol.34:263-268) described method, by using parathion-methyl (O, O-diethyl O-(4-nitrophenyl) thiophosphatephosphorothioate, Sigma) measure in conjunction with the polymer particles of PhaC-OpdA and active in conjunction with the organophosphor hydrolytic enzyme of the polyester of PhaC as substrate.
Use Spectromax90 spectrophotometer (Molecular Devices), monitor the hydrolysis rate of parathion-methyl by the increase (release by p-NP causes) of 405nm place light absorption ratio.Unit of enzyme activity is defined as the μ mol parathion-methyl that per minute transforms.
Result
The plasmid pET14b PhaC-connexon of coding total length OpdA-OpdA translation is merged to the formation of poly butyric ester (PHB) polymer particles in polyester synthase PhaC(mediation recombination bacillus coli B121 λ (D Ε 3)) C-terminal, cause total amount of polyester to account for approximately 48% of biomass, it is smaller when 59% prepared content of the recombination bacillus coli B121 λ (D Ε 3) with only expressing the wild-type polyester synthase is compared.Additionally confirmed the formation of spherical particle in the cell (not display data) by Nile red colouring cell fluorescence microscopy.The appended analysis of protein of polymer particles that separates has clearly shown the excessive preparation of PhaC-OpdA fusion rotein, and the identity of described PhaC-OpdA fusion rotein is by tryptic peptide fingerprint recognition analysis confirmation (not display data).
Use parathion-methyl as substrate, test shows that the organophosphor hydrolytic enzyme of the polymer particles that PhaC and PhaC-OpdA merge is active.The PhaC polymer particles does not have can detect the organophosphor hydrolytic enzyme activity, yet the PhaC-OpdA fusion rotein that shows polymer particles has every gram wet polymer particle mass approximately 1, the activity of 840U.
Discuss
The present embodiment shown and can prepare catalytic polymer particulate of the present invention by merging to the C-terminal of polyester synthase PhaC, and wherein enzyme (being OpdA in this situation) is effectively fixed with high-density and functional quilt.Application standard fermentation using bacteria technology, can in commercial quantity prepare these polymer particles, and these polymer particles are applicable to TFF.
The purposes ofembodiment 7. catalytic polymer particulates in the TFF base transforms and removes poison.
In this embodiment, use the polymer particles that comprises the enzyme group by TFF, from solution catalyzing with separate organic low molecular and quantize compound.In addition, proved that in present method, enzymic activity can circulate.
Method
The 50ml solution of 200 μ Μ parathion-methyls in the CHES damping fluid forms retentate solution.0.2 μ m, 20cm have been used in employing2The TFF system of PES micro-filtration cylinder is also moved this 50ml TFF retentate under recycle to extinction, collected 0.5ml level part (~30ml or 1DV) in every 5 minutes simultaneously, in order to measure light absorption ratio and to be back to retentate.Move after 10 minutes, the 500mg polymer particles is added to suspension and observes the conversion (Figure 14) of MP to PNP in the 405nm place.After reaction was completed, diafilteration retentate was to remove the whole PNP(Figure 15 in collected 50ml level part).After removing whole PNP, remaining polymer particles is suspended in 45ml again and 5ml MP enriched material is added to generate 200 μ Μ parathion-methyls, repeat concentrated and approving and forwardingization process until complete recirculation, and in 520nm,sentence 5 minutes interval measurement reaction process (Figure 14).
Result
As can be clearly by Figure 14 and 15 findings, the inventive method can remove via the repeatedly circulation of catalytic process the low molecular weight organic compound of pollution.Figure 14 clearly shown parathion-methyl during TFF with under polymer particles contacts to the rapid conversion of p-NP.As shown in Figure 14, complete parathion-methyl after the catalyzed conversion of p-NP, with CHES damping fluid diafiltration 30ml polymer particulate suspending liquid.Monitor removing of p-NP by measuring diafiltration level part in the light absorption ratio at 405nm place.In case p-NP is removed, polymer particles be recycled for another take turns except the poison.
The purposes ofembodiment 8. tangential flow filtrations in PHB polymer particles purifying
The present embodiment has been described the broad sense purposes that TFF is used for technical grade purifying PHB polymer particles and is used for multiple application.In an exemplary, TFF is used for removing the host cell pollutent from cell homogenates.Bacterium living beings matter is suspended in and comprises for example buffered soln of lysozyme and EDTA (to destroy bacteria cell wall) and by several different methods known in the art of processing vehicle, comprise that any in ultrasonic, cell crushing instrument or Micro Fluid dissolves.In case dissolve, use the micro-filtration of desired size (for example 0.1 μ m-0.45 μ m) to separate little subcellular component from polymer particles.Representative processing scheme is shown in Fig. 6.
Representative processing scheme inembodiment 9 is used for this Preparation Example, and it has been described use TFF and has prepared the polymer particles composition.
Method
With 1mM EDTA, about 20g is contained intestinal bacteria biomass Micro Fluid in the salt (PBS) of 250ml phosphate buffered of PHB polymer particles.Directly 250ml homogenate is added to and has 0.1 μ m hole 110cm2The tubular fibre TFF system of TFF cylinder, and with the PBS-20% ethanol of 8 volumes (8x250ml), carry out diafiltration (Figure 17).
Result
As can be by Figure 17 finding, as the content by observing diafiltration level part (by diafiltration level part in 260,280 and the light absorption ratio at 600nm place) (Figure 17 A), the protein concentration of diafiltration level part (Figure 17 B) and by analyze that diafiltration level part (Figure 17 C) on SDS PAGE proves like that, easily realized removing of host cell pollutent.Due to soluble protein (A280) and nucleic acid (A260) from polymer particles, remove and enter penetrant, purifying is proved.
The present embodiment has proved separating by using sanitising agent (being in this embodiment Septochol (DOC)) further to be strengthened of host cell proteins and film.
Method
With the multiple damping fluid host cell (and discharge PHB polymer particles) that homogenizes, every kind contains 0.2%DOC.The damping fluid composition that homogenizes used is listed in the table below 2.These identical damping fluids also are used for the diafiltration of tubular fibre TFF method with purified polymer microparticle suspending liquid (Figure 18).With intestinal bacteria biomass (~20g) Micro Fluid in the multiple damping fluid of 250ml.Subsequently at 110cm2On tubular fibre tangential flow cylinder, with this homogenate of same buffer diafiltration of 8 volumes (8x250ml).After the extra TFF diafiltration of PBS-20% ethanol, estimate the IgG of polymer particles in conjunction with activity.
Result
As can, by Figure 19 finding, under multiple more and more exacting terms, by after the TFF percolation treatment, having kept IgG-in conjunction with activity.
Table 2. is used for homogeneity and the TFF buffer conditions of IgG purifying
The purposes ofembodiment 11. sanitising agents (rouble Ruo Er) in the PHB polymer particles purifying that uses open runner tangential flow filtration.
Use is designed for the open runner crossing current system of pilot scale, and the use of the PHB polymer particles TFF purifying that sanitising agent strengthens also is able to extensive development.Sanitising agent for example deoxidation courage ester, rouble Ruo Er and SDS to be proved to be for the purifying that strengthens these polymer particles be effective.
Method
In 0.5% rouble of Ruo Er 50mM Tris-10mM edta buffer liquid (pH10), the intestinal bacteria biomass that 325g contained the polymer particles of the present invention that comprises the Z-territory homogenize by Micro Fluid.Reclaimed the crude polymer particulate in 30 minutes to remove the supernatant liquor that is rich in host cell DNA, albumen and lipid by centrifugal this cell homogenates under 16000xg.
The homogenate of crude polymer particulate is applied to the long-pending 0.34m of being of total open water passage surface2Millipore Prostak – 4 axilemma cylinders.Process the crude polymer microparticle suspending liquid to carry out diafiltration with 0.1% rouble of Ruo Er of 8 volumes.The 25mM sodium citrate salt (pH3.0) of 20mM Tris-10mM EDETATE SODIUM (pH10), 8 volumes and the PBS-20% ethanol (pH7.4) of 8 volumes.Use the processing of pH3.0 citrate buffer to be designed to simulating polymer particulate elution requirement and remove any residual, can be at the host cell proteins of wash-out under acidic conditions.PBS-20% ethanol is in order to control pH and the salinity of final product in the environment not supporting microorganism growth.
Result
Penetrant analysis shown in Figure 20 has shown significantly reduced albumen and nucleic acid, and this is to a great extent owing to centrifugal and removed these pollutents via the crude polymer particulate before TFF.
Analysis is that reclaim from retentate, the IgG of polymer particles of the present invention that comprise the GB1-territory in conjunction with active and with the glycerine gradient purification of samples of original host cell biomolecule matter in conjunction with activity compare (referring to Figure 21)., in conjunction with data presentation, derived from the gained IgG productive rate of these polymer particles, to the non-glycerine gradient of expanding, process and can expand the similar of TFF-sanitising agent extraction treatment.Therefore, be not only that the PHB polymer particles is functional to be retained, and be used for the TFF based method of particulate preparation can scale operation.
The present embodiment proof is by using the chemical extraction agent to realize the enhancing of polymer particles purifying.In the method, process bacterium homogenate with the dispersion that strengthens cell debris with by removing the purifying of pollutent with any of number of chemical condition.The scope of electrochemical conditions can form the chemical extraction model.In addition, test this chemical processing agent and whether affect the activity of polymer particles to measure this chemical processing agent.
Method
Be used for strengthening the inventive method and be listed in the table below 3 from the number of chemical condition of PHB-polymer particles extraction pollutent.
Table 3. chemical extraction model
Criticize wash studies
Contain the coarse biometric matter homogenate of the polymer particles of the present invention (IgG is in conjunction with the PHB polymer particles) that comprises the Z-territory with the extraction of number of chemical treatment agent, described chemical processing agent comprises bronsted lowry acids and bases bronsted lowry treatment agent, high salt, sequestrant, sanitising agent and chaotropic agent.In centrifugal polymerization thing particulate/homogenate (15000xg, 20 minutes) afterwards, quantize pollutent degree of removing by measuring the supernatant liquor light absorption ratio.The crude polymer particle sphere is suspended in PBS(pH7.4 again) in and measure the residual degree (with PBS contrast, comparing) of IgG combination.
Result
As depending on chemical processing agent used by Figure 22 A finding, by pollutent degree of the removing noticeable change of A260 and A280 quantification.In addition, as shown in Figure 22 B, depend on chemical processing agent used in the preparation method, IgG is in conjunction with residual degree noticeable change.
A kind of expandable method that is used for the purified polymer particulate that has merged chemical extraction and TFF is shown in Figure 23.The method can be from the multikilogram operation at the most of 20g biological quality.In addition, the chemical extraction condition be not limited to this paper those of clear and definite example---sanitising agent type, concentration both, and can change chemical processing agent to be suitable for the particular requirement of polymer particles preparation process.
After chemical extraction, but the polymer particles piece of purifying is applied to be mounted with the Prostak system on expanded film surface, as requested, but described expanded film surface is 0.17m2-number m2
After the TFF diafiltration, when from the Prostak system, reclaiming, the polymer particles of purifying is stored in PBS-ethanol, perhaps is concentrated into specific " slurry " concentration in more small-scale tubular fibre system.Carry out multiple analysis to measure method and carry out as required multiple analysis to measure to characterize final polymer particles preparation or to run through the method.
Embodiment 14.PHB polymer particles is from the pilot scale extraction of intestinal bacteria biomass
In the present embodiment, process the intestinal bacteria biomass (1100-1200g) that contain the PHB polymer particles of pilot scale amount with scalable method as described inabove embodiment 13.
Method
With polymer particles in SDS-Tris-EDTA alkali lye Micro Fluid to homogenize cell and reclaim the crude polymer particulate.In subordinate phase, the crude polymer corpuscular eclipse in dissolution process (it is by extensively compacting) (referring to Figure 24) is subsequently with dissolving sanitising agent, and thioglycerin and 0.1N NaOH wash.Between each step, with 16000xg, collectedpolymer particles 30 minutes.
After extraction, the neutralized crude polymer particles also fills on the Prostak system, and it is 0.41m that described Prostak system is filled with membrane area2But expanded film surface, and with the 0.04%SDS-TRIS EDTA of 20 volumes, the citrate buffer (pH3.0) of 7 volumes and 10mM sodium sulfate, the 150mM NaCl(pH7.4 of the highest 10 volumes)-20% ethanol percolation, until the pH of suspension reaches pH7.4(Figure 25).
Result
The effect of the present embodiment purification process used is analyzed intracellular toxin minimizing in (referring to Figure 26) and polymer particulate suspending liquid by SDS-PAGE and is identified that (as shown in table 3 below) institute is high-visible.
Before table 3 – TFF purifying and level of endotoxin afterwards
Discuss
The present embodiment proof is by using methods described herein easily to realize preparing via the polymer particles pilot scale of TFF.Realized the significantly reduction of significantly removing of contaminating protein and level of endotoxin from the separation of coarse biometric matter via TFF.Therefore, for utilizing the TFF method to expand to prepare the purified polymer particulate, the inventive method is amenable to.。
Industrial application
Polymer particles of the present invention and method have been widely used in purifying and technology of preparing, comprise from complex combination thing isolation of target substances with from comprising the composition preparation feedback product of one or more reaction substrates.
Claims (52)
1. purification process that is used for from the source material isolation of target substances, the method comprises that (a) provides source material, (b) with the described source material of at least one semi-permeable strainer tangential flow filtration, (c) reclaim target substance, wherein in one or more source materials, semi-permeable strainer or described tangential flow filtration, one or more solution used comprise one or more polymer particles, and wherein one or more polymer particles comprise
I. be selected from the biological polymer of polyester, polythioester or PHA; Or
Ii. form the polypeptide of polymer particles, for example polymkeric substance synthase or polymkeric substance synthase merge; Or
Iii. the polypeptide of conjugated polymer particulate;
Iv. polypeptide fusion partner;
V. affinity ligand;
Vi. enzyme;
Vii. the fusion polypeptide that comprises above two or more; Or
Viii. above (i) is to (any two or more any combination vii).
2. the process of claim 1 wherein one or more polymer particles comprise the biological polymer that is selected from polyester, polythioester or PHA and
I. form the polypeptide of polymer particles, for example polymkeric substance synthase or polymkeric substance synthase merge; Or
Ii. the polypeptide of conjugated polymer particulate;
Iii. polypeptide fusion partner;
Iv. affinity ligand;
V. enzyme;
Vi. the fusion polypeptide that comprises above two or more; Or
Vii. above (i) is to (any two or more any combination vi).
3. the process of claim 1 wherein one or more polymer particles comprise can the combining target material part.
4. the purification process of claim 1 or claim 2, wherein target substance is one or more antibody.
5. the purification process of claim 1, wherein target substance is one or more polymer particles.
6. method that is used for preparing from source material one or more target substances, the method comprises makes source material and amorphous polymer Particle Swarm contact for some time to be enough to make the amorphous polymer particulate to be combined one or more target substances or one or more target substance precursors or one or more pollutents, separate one or more pollutents or from one or more target substances of separated from contaminants or its precursor of particulate combination by tangential flow filtration from the target substance of particulate combination or its precursor, and reclaim target substance.
7. the method for claim 6, wherein the amorphous polymer Particle Swarm is the homogeneous group.
8. the method for claim 6, wherein the amorphous polymer Particle Swarm is heterogeneous group.
9. the method for claim 6, wherein one or more amorphous polymer particulates comprise one or more biological polymers that are selected from polyester, polythioester or PHA.
10. the method for claim 6, wherein one or more amorphous polymer particulates are synthetic for maybe forming albumen by particulate.
11. the method for claim 10, wherein whole polymer particles group is synthetic for maybe forming albumen by particulate basically.
12. the method for claim 6, wherein one or more amorphous polymer particulates comprise polymer particles formation albumen, and for example polymkeric substance synthase or polymkeric substance synthase merge.
13. the method for claim 6, wherein the recovery of target substance is by carrying out from the polymer particles wash-out.
14. the method for claim 6, wherein the recovery of target substance is undertaken by collecting the tangential flow filtration penetrant.
15. the method for claim 6, wherein the recovery of complex is undertaken by collecting the tangential flow filtration retentate.
16. method that is used for from one or more target substances of source material isolated or purified, the method comprises makes source material and polymer particles group contact for some time to be enough to make one or more polymer particles to be combined one or more target substances, separate one or more pollutents by tangential flow filtration from the target substance of particulate combination, with the recovery target substance, wherein one or more polymer particles comprise
I. be selected from the biological polymer of polyester, polythioester or PHA; Or
Ii. form the polypeptide of polymer particles, for example polymkeric substance synthase or polymkeric substance synthase merge; Or
Iii. the polypeptide of conjugated polymer particulate;
Iv. polypeptide fusion partner;
V. affinity ligand;
Vi. enzyme;
Vii. the fusion polypeptide that comprises above two or more; Or
Viii. above (i) is to (any two or more any combination vii).
17. method that is used for from one or more target substances of source material isolated or purified, the method comprises makes source material and polymer particles group contact for some time to be enough to make one or more polymer particles to be combined one or more pollutents, by tangential flow filtration one or more target substances of separated from contaminants from the particulate combination, with the recovery target substance, wherein one or more polymer particles comprise
I. be selected from the biological polymer of polyester, polythioester or PHA; Or
Ii. form the polypeptide of polymer particles, for example polymkeric substance synthase or polymkeric substance synthase merge; Or
In. the polypeptide of conjugated polymer particulate;
Iv. polypeptide fusion partner;
V. affinity ligand;
Vi. enzyme;
Vii. the fusion polypeptide that comprises above two or more; Or
Viii. above (i) is to (any two or more any combination vii).
18. method for the preparation of one or more reaction product, the method comprises by tangential flow filtration makes the source material that comprises one or more reaction substrates and one or more polymer particles contact for some time to be enough to make one or more polymer particles to be combined the required level part of one or more reaction substrates, randomly by tangential flow filtration, from polymer particles, separate one or more pollutents, with the recovery reaction product, wherein one or more polymer particles comprise catalysts, and wherein one or more polymer particles comprise
I. be selected from the biological polymer of polyester, polythioester or PHA; Or
Ii. form the polypeptide of polymer particles, for example polymkeric substance synthase or polymkeric substance synthase merge; Or
Iii. the polypeptide of conjugated polymer particulate;
Iv. polypeptide fusion partner;
V. affinity ligand;
Vi. enzyme;
Vii. the fusion polypeptide that comprises above two or more; Or
Viii. above (i) is to (any two or more any combination vii).
19. the method for the preparation of polymer particles, wherein one or more polymer particles comprise
Ix. be selected from the biological polymer of polyester, polythioester or PHA; Or
X. form the polypeptide of polymer particles, for example polymkeric substance synthase or polymkeric substance synthase merge; Or
Xi. the polypeptide of conjugated polymer particulate;
Xll. polypeptide fusion partner;
Xlll. affinity ligand;
Xiv. enzyme;
Xv. the fusion polypeptide that comprises above two or more; Or
Xvi. above (i) is to (any two or more any combination vii);
And wherein the method comprises by tangential flow filtration and separates one or more pollutents from polymer particles, and reclaims polymer particles.
20. method that is used for from one or more polymer particles of source material isolated or purified, the method comprises by tangential flow filtration separates one or more pollutents from polymer particles, with one or more polymer particles of recovery, wherein one or more particulates comprise
I. be selected from the biological polymer of polyester, polythioester or PHA; Or
Ii. form the polypeptide of polymer particles, for example polymkeric substance synthase or polymkeric substance synthase merge; Or
Iii. the polypeptide of conjugated polymer particulate;
Iv. polypeptide fusion partner;
V. affinity ligand;
Vi. enzyme;
Vii. the fusion polypeptide that comprises above two or more; Or
Viii. above (i) is to (any two or more any combination vii).
21. purification process that is used for one or more antibody of purifying, it comprises provides the source material that comprises one or more antibody, with the described source material of at least one semi-permeable strainer tangential flow filtration, wherein in one or more source materials, semi-permeable strainer, described tangential flow filtration, one or more solution used comprise one or more polymer particles, and wherein one or more polymer particles comprise part that can binding antibody, and reclaim antibody.
22. method for the manufacture of the semi-permeable strainer that is used for tangential flow filtration, the method comprises provides permeable or semi-permeable carrier, one or more polymer particles are bonded to carrier so that semi-permeable strainer to be provided, and wherein one or more polymer particles comprise
I. be selected from the biological polymer of polyester, polythioester or PHA; Or
Ii. form the polypeptide of polymer particles, for example polymkeric substance synthase or polymkeric substance synthase merge; Or
Iii. the polypeptide of conjugated polymer particulate;
Iv. polypeptide fusion partner;
V. affinity ligand;
Vi. enzyme;
Vii. the fusion polypeptide that comprises above two or more; Or
Viii. above (i) is to (any two or more any combination vii).
23. be used for composition, film, strainer or the filter apparatus of tangential flow filtration, wherein composition, film, strainer or filter apparatus comprise one or more and comprise following polymer particles
I. be selected from the biological polymer of polyester, polythioester or PHA; Or
Ii. form the polypeptide of polymer particles, for example polymkeric substance synthase or polymkeric substance synthase merge; Or
Iii. the polypeptide of conjugated polymer particulate;
Iv. polypeptide fusion partner;
V. affinity ligand;
Vi. enzyme;
Vii. the fusion polypeptide that comprises above two or more; Or
Viii. above (i) is to (any two or more any combination vii).
24. one kind comprises following polymer particles
I. be selected from the biological polymer of polyester, polythioester or PHA; Or
Ii. form the polypeptide of polymer particles, for example polymkeric substance synthase or polymkeric substance synthase merge; Or
Iii. the polypeptide of conjugated polymer particulate;
Iv. polypeptide fusion partner;
V. affinity ligand;
Vi. enzyme;
Vii. the fusion polypeptide that comprises above two or more; Or
Viii. above (i) to (any two or more any combination vii),
Wherein one or more polypeptide for or comprise GB1 territory from streptococcic Protein G.
25. one kind comprises the polypeptide that forms polymer particles and from the fusion polypeptide in one or more GB1 territory of streptococcic Protein G.
26. the particulate of claim 24 or the polypeptide of claim 25, wherein polypeptide for or comprise by having the GB1 territory of 12 or a plurality of polynucleotide sequence coding in abutting connection with Nucleotide SEQ ID NO.4.
27. the particulate of claim 24 or the polypeptide of claim 25, wherein polypeptide for or comprise by having the polypeptide of 12 or a plurality of polynucleotide sequence coding in abutting connection with Nucleotide SEQ ID NO.4.
28. the particulate of claim 24 to 27 any one, wherein polymer particles has the immunoglobulin (Ig) binding ability greater than 30mg immunoglobulin (Ig)/g wet polymer particulate.
29. the particulate of claim 28, wherein binding ability is at least about 35mg immunoglobulin (Ig)/g wet polymer particulate, about 40mg immunoglobulin (Ig)/g wet polymer particulate, about 45mg immunoglobulin (Ig)/g wet polymer particulate, about 50mg immunoglobulin (Ig)/g wet polymer particulate, about 55mg immunoglobulin (Ig)/g wet polymer particulate, or about 60mg immunoglobulin (Ig)/g wet polymer particulate.
30. the particulate of claim 28 or 29, wherein immunoglobulin (Ig) is IgG.
31. the method for claim 1-18,20 or 21 any one, wherein source material for or be derived from cell lysate, for or be derived from protein expression system.
32. the method for claim 1-18,20 or 21 any one, wherein source material is or is derived from food, comprises that milk preparation or diary processing flow, comprise the fermented liquid of grape wine or beer fermentation liquid.
33. the method for claim 1-18,20 or 21 any one, wherein source material is solution, comprises reaction soln, chemosynthesis solution, chemosynthesis intermediate.
34. the method for claim 1-18,20 or 21 any one, wherein target substance is polypeptide, for example comprises recombinant polypeptide, antibody, enzyme, hormone.
35. the method for claim 1-18,20 or 21 any one, wherein target substance is polynucleotide, for example comprise, and recombination of polynucleotide, carrier, oligonucleotide, the RNA molecule is rRNA, mRNA, miRNA, siRNA or tRNA for example, or DNA molecular cDNA for example.
36. the method for claim 1-18,20 or 21 any one, wherein target substance is products of cellular metabolism, comprises the secretion meta-bolites.
37. the method for claim 1-22 any one, the composition of claim 23, film, strainer or filter apparatus or claim 24 or 26 are to the particulate of 30 any one, wherein polymer particles comprises the biological polymer that is selected from polyester, polythioester or PHA (PHA).
38. the method for claim 1-22 any one, the composition of claim 23, film, strainer or filter apparatus or claim 24 or 26 are to the particulate of 30 any one, wherein polymkeric substance comprises PHA, preferably gathers (3-hydroxybutyrate ester) (PHB).
Substantially go up by or by the biological polymer that is selected from polyester, polythioester or PHA (PHA), formed 39. the method for claim 1-22 any one, the composition of claim 23, film, strainer or filter apparatus or claim 24 or 26, to the particulate of 30 any one, wherein form the polymkeric substance of particulate.
40. the method for claim 1-22 any one, the composition of claim 23, film, strainer or filter apparatus or claim 24 or 26 are to the particulate of 30 any one, wherein polymer particles comprises the polymer particles by the encapsulation of phosphatide individual layer.
41. any one of aforementioned claim, wherein when existing, the polymkeric substance synthase is bonded to polymer particles or is bonded to the phosphatide individual layer or is bonded to both.
42. any one of aforementioned claim, wherein polymer particles comprises two or more different fusion polypeptide.
43. any one of aforementioned claim, wherein when existing, the polymkeric substance synthase covalently or non-covalently is bonded to its formed polymer particles.
44. any one of aforementioned claim, wherein when existing, the polymkeric substance synthase is from Gram-negative and gram positive bacterium or from the PHA polymkeric substance synthase of archeobacteria.
45. any one of aforementioned claim, wherein when existing, the polymkeric substance synthase comprises from preserving number and is respectively AY836680, AE004091, AB205104, AF109909, YP137339, the hookworm of AB049413 and AF150670 is coveted copper bacterium (C.necator), Pseudomonas aeruginosa (P.aeruginosa), the different chomophoric bacterium of wine and women-sensual pursuits (A.vinosum), bacillus megaterium (B.megaterium), dead sea salts box bacterium (H.marismortui), Pseudomonas aureofaciens (P.aureofaciens), or the PHA polymkeric substance synthase of pseudomonas putida (P.putida).
46. the method for claim 1-22 any one, the composition of claim 23, film, strainer or filter apparatus or claim 24 or 26 are to the particulate of 30 any one, wherein one or more polymer particles are combined with permeable or semi-permeable carrier enduringly.
47. the method for claim 1-22 any one, the composition of claim 23, film, strainer or filter apparatus or claim 24 or 26 are to the particulate of 30 any one, wherein one or more polymer particles reversibly are combined with permeable or semi-permeable carrier.
48. the method for claim 1-22 any one, the composition of claim 23, film, strainer or filter apparatus or claim 24 or 26 are to the particulate of 30 any one, wherein one or more polymer particles covalently or non-covalently are bonded to semi-permeable strainer.
49. the method for claim 1-22 any one, the composition of claim 23, film, strainer or filter apparatus or claim 24 or 26 are to the particulate of 30 any one, wherein one or more polymer particles are adsorbed on semi-permeable carrier or film.
50. the method for claim 1-22 any one, the composition of claim 23, film, strainer or filter apparatus or claim 24 or 26 are to the particulate of 30 any one, wherein one or more polymer particles comprise the part that can be bonded to semi-permeable carrier or film.
51. one kind basically as described herein and reference example and accompanying drawing be used for method from one or more target substances of source material isolated or purified or polymer particles.
52. composition, film, strainer, filter apparatus or the polymer particles of as described herein and reference example and accompanying drawing basically.
Applications Claiming Priority (3)
| Application Number | Priority Date | Filing Date | Title |
|---|---|---|---|
| US42166910P | 2010-12-10 | 2010-12-10 | |
| US61/421,669 | 2010-12-10 | ||
| PCT/IB2011/055564WO2012077080A1 (en) | 2010-12-10 | 2011-12-09 | Compositions for separation methods |
Publications (1)
| Publication Number | Publication Date |
|---|---|
| CN103384677Atrue CN103384677A (en) | 2013-11-06 |
Family
ID=46206666
Family Applications (1)
| Application Number | Title | Priority Date | Filing Date |
|---|---|---|---|
| CN2011800672323APendingCN103384677A (en) | 2010-12-10 | 2011-12-09 | Compositions for separation methods |
Country Status (9)
| Country | Link |
|---|---|
| US (1) | US20130337528A1 (en) |
| EP (1) | EP2649088A4 (en) |
| JP (1) | JP2014506873A (en) |
| KR (1) | KR20140092227A (en) |
| CN (1) | CN103384677A (en) |
| AU (1) | AU2011340132A1 (en) |
| CA (1) | CA2820861A1 (en) |
| SG (1) | SG191089A1 (en) |
| WO (1) | WO2012077080A1 (en) |
Cited By (2)
| Publication number | Priority date | Publication date | Assignee | Title |
|---|---|---|---|---|
| CN106457153A (en)* | 2014-03-07 | 2017-02-22 | 新加坡科技研究局 | Apparatus and methods for fractionation of biological products |
| CN113634124A (en)* | 2013-12-04 | 2021-11-12 | 普凯尔德诊断技术有限公司 | Method and apparatus for processing and analyzing particles extracted by tangential filtration |
Families Citing this family (24)
| Publication number | Priority date | Publication date | Assignee | Title |
|---|---|---|---|---|
| DE12722942T1 (en) | 2011-03-31 | 2021-09-30 | Modernatx, Inc. | RELEASE AND FORMULATION OF MANIPULATED NUCLEIC ACIDS |
| CA2868485C (en)* | 2012-03-28 | 2020-09-15 | Michael R. Ladisch | Methods and systems useful for foodborne pathogen detection |
| WO2013190453A2 (en)* | 2012-06-18 | 2013-12-27 | Tracy Thompson | Compositions for separation methods |
| AU2014236396A1 (en)* | 2013-03-14 | 2015-08-13 | Shire Human Genetic Therapies, Inc. | Methods for purification of messenger RNA |
| LT2970948T (en) | 2013-03-15 | 2019-03-25 | Glaxosmithkline Biologicals Sa | Rna purification methods |
| WO2014152027A1 (en) | 2013-03-15 | 2014-09-25 | Moderna Therapeutics, Inc. | Manufacturing methods for production of rna transcripts |
| EP4279610A3 (en) | 2013-03-15 | 2024-01-03 | ModernaTX, Inc. | Ribonucleic acid purification |
| SG11201608725YA (en) | 2014-04-25 | 2016-11-29 | Shire Human Genetic Therapies | Methods for purification of messenger rna |
| WO2016180430A1 (en) | 2015-05-08 | 2016-11-17 | Curevac Ag | Method for producing rna |
| DE202016009003U1 (en) | 2015-05-29 | 2021-05-28 | Curevac Real Estate Gmbh | Composition comprising in vitro transcribed RNA obtainable by a method for the production and purification of RNA with at least one step with a tangential flow filtration |
| ES2908449T3 (en) | 2015-09-17 | 2022-04-29 | Modernatx Inc | Polynucleotides that contain a stabilizing tail region |
| US9758755B2 (en) | 2015-10-23 | 2017-09-12 | Life Technologies Corporation | Filter-based method for efficient capture of lysis of suspended cells |
| JP6885611B2 (en) | 2015-12-18 | 2021-06-16 | ユニバーシティ オブ カンタベリー | Separation medium |
| WO2017223176A1 (en) | 2016-06-24 | 2017-12-28 | Modernatx, Inc. | Methods and apparatus for filtration |
| JP2018053175A (en)* | 2016-09-30 | 2018-04-05 | 日立化成株式会社 | Dissolution treatment device and dissolution treatment method |
| CN110650972A (en)* | 2017-03-29 | 2020-01-03 | 耶路撒冷希伯来大学伊森姆研究发展有限公司 | Purification of an agent of interest |
| EP3841208A1 (en) | 2018-08-24 | 2021-06-30 | Translate Bio, Inc. | Methods for purification of messenger rna |
| FR3098416B1 (en)* | 2019-07-11 | 2023-03-31 | Agro Paris Tech | Process for the purification of high molecular weight cofactors by tangential dia-filtration |
| KR20210121585A (en)* | 2020-03-30 | 2021-10-08 | 한국세라믹기술원 | Z domain-calsequestrin fusion protein with improved reactivity, stability and antibody recovery and method of isolating and purifying antibody using the same |
| WO2023049747A1 (en)* | 2021-09-22 | 2023-03-30 | Elanco Us Inc. | Streptococcus suis lytic enzyme compositions and methods of use thereof |
| WO2023085374A1 (en)* | 2021-11-11 | 2023-05-19 | 株式会社カネカ | Method for producing polyhydroxyalkanoate |
| EP4551589A1 (en)* | 2022-07-05 | 2025-05-14 | Lihme Protein Solutions | Improved apparatus for compound separation |
| EP4622990A1 (en) | 2022-11-21 | 2025-10-01 | CHRETO ApS | Method for purification of a target product using affinity purification technology |
| WO2025100924A1 (en)* | 2023-11-06 | 2025-05-15 | 주식회사 엘지화학 | Particle complex, cell culture composition using same, and method for producing cell therapeutic agent |
Citations (2)
| Publication number | Priority date | Publication date | Assignee | Title |
|---|---|---|---|---|
| US20060141570A1 (en)* | 2004-11-16 | 2006-06-29 | Wood David W | Intein-mediated protein purification using in vivo expression of an aggregator protein |
| WO2007037706A2 (en)* | 2005-09-27 | 2007-04-05 | Bernd Helmut Adam Rehm | Polymer particles and uses thereof |
Family Cites Families (5)
| Publication number | Priority date | Publication date | Assignee | Title |
|---|---|---|---|---|
| US5256557A (en)* | 1991-12-27 | 1993-10-26 | Solvay Enzymes, Inc. | Purified alkaline protease concentrate and method of preparation |
| EP0808373B1 (en)* | 1995-02-09 | 1999-05-06 | The Monsanto Company | Latex of polyhydroxyalkanoate |
| AU2001268153A1 (en)* | 2000-06-02 | 2001-12-17 | Pall Corporation | Processing of plasmid-containing fluids |
| CA2586107A1 (en)* | 2004-11-03 | 2006-05-18 | Introgen Therapeutics Inc. | A novel method for the production and purification of adenoviral vectors |
| EP2321337B2 (en)* | 2008-08-14 | 2018-10-10 | Genentech, Inc. | Methods for removing a contaminant using protein displacement ion exchange membrane chromatography |
- 2011
- 2011-12-09CNCN2011800672323Apatent/CN103384677A/enactivePending
- 2011-12-09EPEP11846892.5Apatent/EP2649088A4/ennot_activeWithdrawn
- 2011-12-09USUS13/992,813patent/US20130337528A1/ennot_activeAbandoned
- 2011-12-09SGSG2013044557Apatent/SG191089A1/enunknown
- 2011-12-09KRKR1020137017938Apatent/KR20140092227A/ennot_activeWithdrawn
- 2011-12-09CACA2820861Apatent/CA2820861A1/ennot_activeAbandoned
- 2011-12-09AUAU2011340132Apatent/AU2011340132A1/ennot_activeAbandoned
- 2011-12-09JPJP2013542659Apatent/JP2014506873A/enactivePending
- 2011-12-09WOPCT/IB2011/055564patent/WO2012077080A1/enactiveApplication Filing
Patent Citations (2)
| Publication number | Priority date | Publication date | Assignee | Title |
|---|---|---|---|---|
| US20060141570A1 (en)* | 2004-11-16 | 2006-06-29 | Wood David W | Intein-mediated protein purification using in vivo expression of an aggregator protein |
| WO2007037706A2 (en)* | 2005-09-27 | 2007-04-05 | Bernd Helmut Adam Rehm | Polymer particles and uses thereof |
Non-Patent Citations (1)
| Title |
|---|
| CHRISTIAN ET AL.: "Affinity cross-flow filtration: purification of IgG with a novel protein A affinity matrix prepared from two-dimensional protein cystals", 《BIOTECHNOLOGY AND BIOENGINEERING》* |
Cited By (4)
| Publication number | Priority date | Publication date | Assignee | Title |
|---|---|---|---|---|
| CN113634124A (en)* | 2013-12-04 | 2021-11-12 | 普凯尔德诊断技术有限公司 | Method and apparatus for processing and analyzing particles extracted by tangential filtration |
| CN113634124B (en)* | 2013-12-04 | 2022-11-18 | 普凯尔德诊断技术有限公司 | Method and device for processing and analyzing particles extracted by tangential filtration |
| CN106457153A (en)* | 2014-03-07 | 2017-02-22 | 新加坡科技研究局 | Apparatus and methods for fractionation of biological products |
| CN106457153B (en)* | 2014-03-07 | 2019-03-29 | 新加坡科技研究局 | Device and method for being classified separation biological products |
Also Published As
| Publication number | Publication date |
|---|---|
| CA2820861A1 (en) | 2012-06-14 |
| WO2012077080A1 (en) | 2012-06-14 |
| EP2649088A1 (en) | 2013-10-16 |
| SG191089A1 (en) | 2013-07-31 |
| JP2014506873A (en) | 2014-03-20 |
| US20130337528A1 (en) | 2013-12-19 |
| AU2011340132A1 (en) | 2013-05-02 |
| KR20140092227A (en) | 2014-07-23 |
| EP2649088A4 (en) | 2014-09-03 |
Similar Documents
| Publication | Publication Date | Title |
|---|---|---|
| CN103384677A (en) | Compositions for separation methods | |
| Zhou et al. | Metaproteomic analysis of biocake proteins to understand membrane fouling in a submerged membrane bioreactor | |
| Zacharof et al. | Recovery of volatile fatty acids (VFA) from complex waste effluents using membranes | |
| Zhao et al. | Increasing the vibration frequency to mitigate reversible and irreversible membrane fouling using an axial vibration membrane in microalgae harvesting | |
| Jarusutthirak et al. | Role of soluble microbial products (SMP) in membrane fouling and flux decline | |
| Zhou et al. | Characterization and significance of sub-visible particles and colloids in a submerged anaerobic membrane bioreactor (SAnMBR) | |
| Das et al. | A comparative study on the production of galacto-oligosaccharide from whey permeate in recycle membrane reactor and in enzymatic batch reactor | |
| Ghosh | Protein bioseparation using ultrafiltration: theory, applications and new developments | |
| Nuengjamnong et al. | Membrane fouling caused by extracellular polymeric substances during microfiltration processes | |
| Kroll et al. | Highly efficient enzyme-functionalized porous zirconia microtubes for bacteria filtration | |
| Mahendran et al. | Surface properties of biofouled membranes from a submerged anaerobic membrane bioreactor after cleaning | |
| Persson et al. | Transmission of BSA during cross-flow microfiltration: influence of pH and salt concentration | |
| Wang et al. | Recovery of organic matters in wastewater by self-forming dynamic membrane bioreactor: performance and membrane fouling | |
| Shirani et al. | Strategically designing a pumpless microfluidic device on an “inert” polypropylene substrate with potential application in biosensing and diagnostics | |
| Wang et al. | Clarification of succinic acid fermentation broth by ultrafiltration in succinic acid bio–refinery | |
| CN1369003A (en) | Detection of micro-organisms | |
| Schuster et al. | S-layer ultrafiltration membranes | |
| Wen et al. | Double-barrier forward osmosis membrane for rejection and destruction of bacteria and removal of dyes | |
| Tran et al. | Fouling analysis in one-stage ultrafiltration of precipitation-treated Bacillus subtilis fermentation liquors for biosurfactant recovery | |
| Guo et al. | The performance of microfiltration process for purifying lactic acid in the fermented broth of kitchen waste | |
| CN103547922B (en) | Method for detecting cells from a sample | |
| RU2762256C2 (en) | Method for purifying agent of interest | |
| Zheng et al. | Virus rejection with two model human enteric viruses in membrane bioreactor system | |
| Huang et al. | Identifications and characterizations of proteins from fouled membrane surfaces of different materials | |
| Lee et al. | A mechanistic study of in situ chemical cleaning-in-place for a PTFE flat sheet membrane: fouling mitigation and membrane characterization |
Legal Events
| Date | Code | Title | Description |
|---|---|---|---|
| C06 | Publication | ||
| PB01 | Publication | ||
| C10 | Entry into substantive examination | ||
| SE01 | Entry into force of request for substantive examination | ||
| C02 | Deemed withdrawal of patent application after publication (patent law 2001) | ||
| WD01 | Invention patent application deemed withdrawn after publication | Application publication date:20131106 |